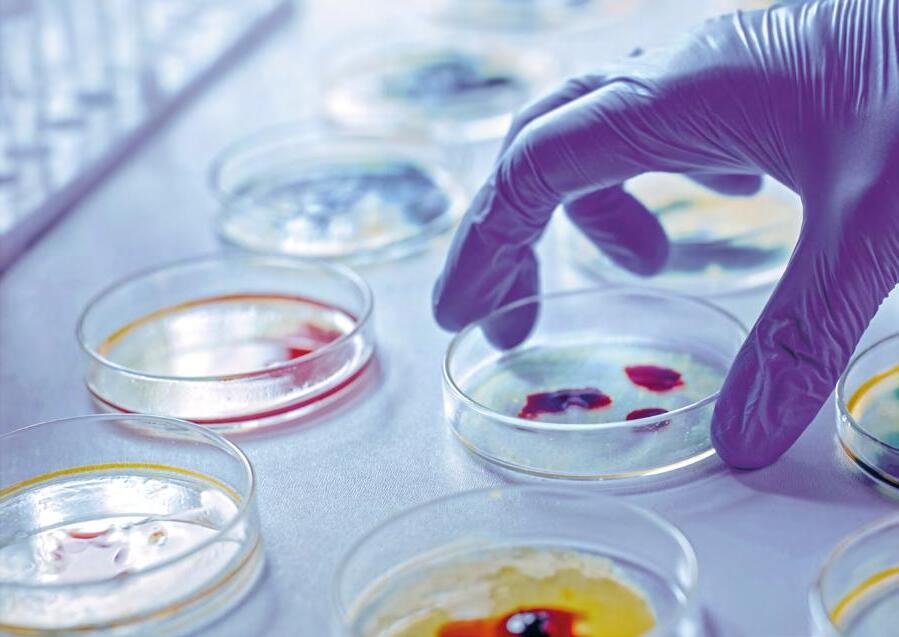
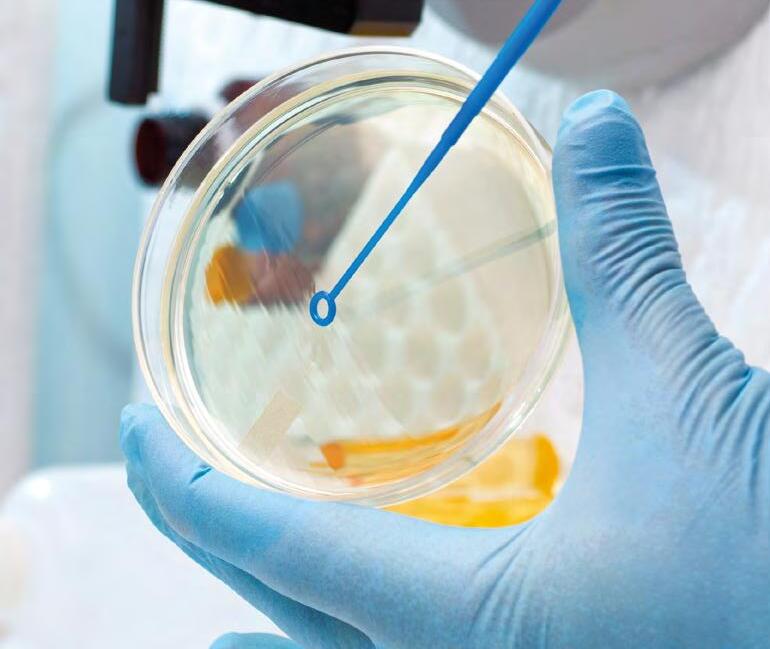

ЛЮТИЙ 2023

Вітаміни Доппельгерц KINDER для майбутніх вундеркіндів




ПНЖК Омега-3 складає 300 мг
високу біологічну активність і підсилюють ефект ПНЖК Омега-3
• в складі є вітаміни А і D, які мають
для дітей з 7-ми років
високу біологічну активність і
підсилюють ефект ПНЖК Омега-3

• для дітей з 7-ми років
• має приємний смак яблука
• унікальна форма – желейні пастилки
• для дітей з 3-х років
МУЛЬТИВІТАМІННИЙ
60 жел. пастилок
КОМПЛЕКС
• має приємний смак малини та апельсину
• унікальна форма – желейні пастилки у вигляді медведиків
• для дітей з 3-х років
БЕЗ ШТУЧНИХ БАРВНИКІВ, КОНСЕРВАНТІВ, ГЛЮТЕНУ ТА ЛАКТОЗИ
Продукція представлена в аптеках України
www.doppelherz.ua






КОМПЛЕКСНИЙ ЗАСІБ ПРИ ЦИСТИТІ
ПОЛЕГШУЄ БІЛЬ ТА СПАЗМ
ТРАВА ЗОЛОТОТИСЯЧНИКА
ЧИНИТЬ ПРОТИЗАПАЛЬНИЙ ТА


СЕЧОГІННИЙ ЕФЕКТИ











КОРІНЬ ЛЮБИСТКУ ЛИСТЯ РОЗМАРИНУ


Îáîâ'ÿçêîâî îçíàéîìòåñü ç іíñòðóêöієþ ïåðåä çàñòîñóâàííÿì.



СКОРОЧЕНА ІНСТРУКЦІЯ ДЛЯ МЕДИЧНОГО ЗАСТОСУВАННЯ ЛІКАРСЬКОГО ЗАСОБУ НЕФРОДОЛ® СКЛАД: діючі речовини: трава золототисячника, корінь любистку, листя розмарину; 1 таблетка містить висушені лікарські рослини у вигляді порошку: трави золототисячника (Herba Centaurii)18 мг,кореня любистку (Radix Levistici)18 мг, листя розмарину (Folia Rosmarini)18 мг; допоміжні речовини: крохмаль кукурудзяний; кремнію діоксид колоїдний безводний; лактоза, моногідрат; повідон; магнію стеарат; цукор білий; гіпромелоза; титану діоксид (Е 171); тальк; поліетиленгліколь; заліза оксид червоний (E 172); рибофлавін (Е 101). ЛІКАРСЬКА ФОРМА: Таблетки, вкриті оболонкою. ПОКАЗАННЯ: Для комплексного лікування запальних захворювань сечовивідних шляхів. Профілактика утворення сечових каменів, у тому числі і після їх видалення. ПРОТИПОКАЗАННЯ: Підвищена індивідуальна чутливість до будь-якого компонента препарату або до інших рослин сімейства Зонтичні (Apiaceae), наприклад аніс, фенхель, та до анетолу (тобто компонента ефірних масел, що містять, наприклад, аніс і фенхель). Пептична виразка. Набряки внаслідок серцевої недостатності або порушення функції нирок та/або рекомендація лікаря щодо обмеження споживання рідини. СПОСІБ ЗАСТОСУВАННЯ ТА ДОЗИ: Якщо лікар не призначив інакше, препарат слід приймати дорослим та дітям віком від 12 років по 2 таблетки 3 рази на добу (загальна добова доза - 6 таблеток). Таблетки слід ковтати, не розжовуючи, з достатньою кількістю рідини (наприклад склянка води). Одночасно з прийомом препарату необхідно забезпечити вживання достатньої кількості рідини. Тривалість лікування визначає лікар індивідуально. Якщо препарат переноситься добре, його можна призначати на тривалий термін. Препарат не рекомендується застосовувати дітям віком до 12 років. ПОБІЧНІ РЕАКЦІЇ: Часто трапляються порушення з боку травного тракту (нудота, блювання, діарея). Можуть виникати алергічні реакції у разі підвищеної чутливості до складових компонентів препарату, включаючи кропив’янку, свербіж, гіперемію шкіри. У разі виникнення будь-яких небажаних реакцій слід припинити застосування препарату і звернутися до лікаря. КАТЕГОРІЯ ВІДПУСКУ: Без рецепта. ВИРОБНИК: ПрАТ «Технолог». МІСЦЕЗНАХОДЖЕННЯ ВИРОБНИКА ТА АДРЕСА МІСЦЯ ПРОВАДЖЕННЯ ЙОГО ДІЯЛЬНОСТІ: Україна, 20300, Черкаська обл., місто Умань, вулиця Стара прорізна, будинок 8. ЗАЯВНИК: ТОВ "ФК "САЛЮТАРІС".

МІСЦЕЗНАХОДЖЕННЯ ЗАЯВНИКА: м. Київ, бульвар Дружби народів, 9. Інформація підготовлена: листопад 2022 року. РП UA/15033/01/01 Наказ МОЗ № 2852 від 23.12.2021 Термін дії реєстраційного посвідчення необмежений з 03.02.2021

2023,
лютий
ЄРЬОМЕНКО Римма Фуатівна — доктор біологічних наук, професор, завідувачка кафедри клінічної лабораторної діагностики Національного фармацевтичного університету
ЗМІСТ
ЧАСУ
04 Всесвітній день боротьби проти раку
08 В україні презентували «Сheck point» — унікальну модель відновлення психічного здоров’я для тих, хто зазнав впливу війни
12 Як живе і працює Національний фармацевтичний університет в умовах воєнного часу: інтерв’ю з в.о. ректора Аллою Котвіцькою
16 Кар’єра і нові знання: які можливості відкриває для молоді програма «Подорожник START»
20 Компанія «Фармак» визнана кращим роботодавцем 2022
21 Панжест — мікробні ферменти для лікування органів травлення
28 Як зберегти та активізувати життєві ресурси в умовах війни?
31 Неовітам® — надійний помічник у боротьбі з хронiчним болем
36 Аптечна мережа 9-1-1: Під опікою не тільки люди, а й тварини

40 Пробіз® Імуно — природній захист організму
48 Стифімол Плюс покращує метаболічні процеси
54 Як підтримати імунітет дитини в період застуди?
60 В Україні удосконалюють систему післядипломної освіти та безперервного професійного розвитку фармацевтичних та медичних фахівців
У СВІТІ МЕДИЦИНИ
63 Розкриття секретів вірулентності Streptococcus A



64 Сучасні погляди на лікування міом. Досвід Ніжинського міського пологового будинку

68 Міжнародний день жінок і дівчат у науці
72 Температура нашого тіла знижується, і причиною можуть бути кишкові бактерії


74 Українських ліків у Європі стане більше: «Фармак» будує завод в Іспанії

76 Cхвалено перший генний препарат для лікування пацієнтів з гемофілією В
78 Харчування: користь і шкода харчових та нехарчових компонентiв
2023 / лютий
НАТУР
84 Ігроманія — сучасні реалії паралельного світу
ПУЛЬС
MODERN АРСЕНАЛ ЗНАНЬ
У ФАРВАТЕРІ ГАЛУЗІ
В 2005 році Міжнародним союзом протиракового контролю (Union for International Cancer Control) — найбільшої і найстарішої міжнародної онкологічної організації — було запропоновано 4 лютого відзначати «Всесвітній день боротьби проти раку». Головною метою проведення Всесвітнього дня боротьби про-



ти раку є:
підвищення обізнаності про рак як про одне із найстрашніших захворювань сучасної цивілізації;
привернення уваги суспільства до запобігання, виявлення, лікування злоякісних новоутворень;
формулювання завдань, що стоять перед світом у боротьбі з онкохворобами;
заклик до політиків і членів організації Міжнародний союз по боротьбі з онкологічними захворюваннями відноситися до раку, як до політичного пріоритету.
Щороку у 14 мільйонів людей діагностують онкопатологію, більшість з яких живуть в країнах з низьким і середнім рівнем економічного розвитку.
9,6 мільйона чоловік вмирають щороку від раку — це більше, ніж ВІЛ/ СНІД, малярія і туберкульоз разом узяті. Приблизно дві третини від загальної кількості випадків смерті від онкологічних захворювань було зафіксовано в менш розвинених країнах через пізню діагностику та дороговартісне лікування.
Більше 60 % нових випадків захворювання на рак зареєстровані в країнах Африки, Азії та Центральної і Південної Америки. У цих регіонах відбувається 70 % всіх випадків смерті від раку. До 2030 року експерти прогнозують зростання смертності від раку до 13 мільйонів. Статистика свідчить про те, що за останніх 100 років за рівнем захворюваності та смертності у світі онкопатологія змістилась з десято-
го місця на друге, поступаючись лише хворобам серцево-судинної системи.
Актуальною темою Всесвітнього дня боротьби проти раку у 2022–2024 роках є «усунення прогалин у догляді». 2023 рік присвячений об’єднанню окремих осіб, організацій, громад, правозахисників і політиків у закликах до змін і вживання заходів. Лікування раку, догляд і супровід пацієнта після лікування відображає нерівність та несправедливість нашого світу, оскільки, половина населення світу не має доступу до всього спектру основних медичних послуг. У низько економічно розвинених країнах багатьом хворим відмовляють у базовій допомозі, незважаючи на те, що ми живемо за часів вражаючих досягнень у галузі профілактики, діагностики та лікування злоякісних новоутворень.
Дохід, освіта, місцезнаходження та дискримінація за ознакою етнічної приналежності, статі, сексуальної орієнтації, віку, інвалідності, способу життя — лише деякі з факторів, що можуть негативно позначитися на доступності до медичних послуг. Але ці бар’єри можна змінити. Саме на це направлена багаторічна кампанія Міжнародного союзу по боротьбі з онкологічними захворюваннями, що дає можливість привернути увагу громадськості до цієї глобальної проблеми.
ЦЕ ВАЖЛИВО!!!
У всьому світі найбільша кількість чоловіків вмирає від наступних видів раку: раку легенів, шлунку, печінки, ободової і прямої кишки та стравоходу; найбільша кількість жінок помирає від наступних видів раку: раку молочної залози, легенів, шлунку, прямої та ободової кишки і шийки матки.
4 ЛЮТОГО
ВСЕСВіТНіЙ ДЕНЬ
БОРОТЬБИ
ПРОТИ РАКУ
4 Журнал «Сучасна фармація» • modern-pharmacy.com.ua • 2023 / лютий • Пульс часу • Події
ЦЕ ЦІКАВО!!!
Існують різні символи, які допомагають
привернути увагу до боротьби проти різних форм раку. Наприклад, рожева стрічка асоціюється з раком молочної

залози, помаранчева — з онкологічними захворюваннями у дітей, жовта — саркомою, блакитна — раком яєчника.
НА ЗАМІТКУ!!!
рак — друга за значущістю причина смерті у всьому світі;
третину всіх поширених видів раку можна запобігти;
70 % випадків смерті від раку відмічається у країнах з
низьким та середнім рівнем доходу;
Для України цього року актуальною є тема: «Онкологічна допомога в умовах військового часу». Щогодини в Україні реєструють понад 20 нових випадків захворювань на рак, а помирає 10 людей. Онкологічні захворювання — на другому місці після серцево-судинних, щороку вперше реєструються в 10 тисяч та забирають життя 90 тисяч українців, 35 % з яких є працездатного віку. Ризик захворіти на рак протягом життя має кожен 3–4-й чоловік і кожна 5–6-та жінка.
Деякі факти Всесвітньої організації охорони здоров’я:
щорічно можна врятувати до 3,7 мільйонів життів завдяки профілактиці, ранньому виявленню та своєчасному лікуванню раку; третина смертей від раку спричинені п’ятьма провідними поведінковими та дієтичними ризиками: високим індексом маси тіла, низь-
Відкриття онкогенних вірусів
ким споживанням фруктів та овочів, відсутністю фізичної активності, вживанням тютюну та алкоголю; вживання тютюну є найважливішим фактором ризику розвитку раку та є причиною приблизно 22 % смертей від раку.
Великою віхою в історії онкології стало усвідомлення вірусного походження пухлин. У різні роки ряд вчених висували гіпотезу про вірусне походження деяких видів пухлин. Проте довести вірусну природу пухлин вдалося ПЕЙТОНУ РОУС. Перші його серйозні дослідження було спрямовано на вивчення лімфоцитів і злоякісних пухлин. У 1912 році вчений висунув три теорії механізмів канцерогенезу. У першій з них говорилося, що віруси інфікують організм ще під час внутрішньоутробного розвитку або в молодому віці і «… здебільшого зовсім не виявляються. Згідно другої теорії, виникнення пухлини залежить від впливу хімічних «провокуючих канцерогенів».
І згідно з третьою гіпотезою, дрімаючі віруси і хімічні канцерогени при взаємодії здатні викликати спонтанну появу пухлин.
У подальшому вид пухлини, що вивчався ним, став називатися саркомою Роуса, а основний етіологічний фактор — вірусом саркоми Роуса. У 40-х роках
ХХ століття цей вірус було виявлено шляхом електронної мікроскопії.
У віці 87 років Френсіс Пейтон Роус отримав Нобелівську премію за відкриття онкогенних вірусів. Нагороду він розділив з ЧАРЛЗ ХАГГІНСОМ, який відомий своїми роботами з лікування раку передміхурової залози.

У 2018 році Нобелівську премію з фізіології та медицини вручили за «відкриття терапії при ракових захворюваннях, яке полягає у гальмуванні негативного імунного регулювання». Нагороджені за це спільно ДЖЕЙМС ЕЛЛІСОН та ТАСУКУ ХОНЧО. Відкриття, зроблене двома лауреатами медицини, використовує здатність імунної системи атакувати ракові клітини, знімаючи з гальм імунні клітини. Джеймс Еллісон вивчав білок і виявив, що він діє як «гальма» на імунну систему. Він втілив цю концепцію у новому підході для лікування пацієнтів. У свою чергу Тасуку Хонджо виявив, що імунні клітини також гальмує протеїн, але має інший механізм дії. Терапія, яку розробили на основі його відкриття, виявилася вражаюче ефективною у боротьбі з раком.
ДЛЯ ПОПЕРЕДЖЕННЯ ТА РАННЬОГО ВИЯВЛЕННЯ БАГАТЬОХ ОНКОЗАХВОРЮВАНЬ ВИЗНАЧЕНО ТРИ ЕТАПИ НАЙЕФЕКТИВНІШИХ ПРОФІЛАКТИЧНИХ ЗАХОДІВ: Первинна профілактика. Має на увазі ведення здорового способу життя, виключивши шкідливі звички.
Вторинна профілактика. Полягає у своєчасній діагностиці ранніх форм захворювання, а також у контролі за особами, що належать до групи ризику та мають схильність до розвитку онкопатології.
Третинна профілактика. Стосується безпосередньо хворих, які вже перенесли ефективне лікування злоякісних новоутворень, і допомагає уникнути їхнього метастазування.
За матеріалами: www.worldcancerday.org



ЦЕ ЦІКАВО!!!
Журнал «Сучасна фармація» • modern-pharmacy.com.ua • 2023 / лютий • Пульс часу • Події 5
В УКРАЇНІ
ПРЕЗЕНТУВАЛИ «CHECK POINT» —

УНІКАЛЬНУ МОДЕЛЬ
ВІДНОВЛЕННЯ
ПСИХІЧНОГО ЗДОРОВ’Я ДЛЯ ТИХ, ХТО ЗАЗНАВ ВПЛИВУ ВІЙНИ

Спеціалісти Центру психічного здоров’я та реабілітації ветеранів «Лісова поляна» Міністерства охорони здоров’я України презентували унікальну модель відновлення психічного здоров’я «Check point» для тих, хто пережив психотравмуючі події. Захід відбувся в межах ініціативи першої леді Олени Зеленської зі створення Національної програми психічного здоров’я та психосоціальної підтримки.
Участь у презентації взяли представники офісу першої леді, міністр охорони здоров’я Віктор Ляшко та директор Місії United States Agency for International Development (USAID) в Україні Джеймс Хоуп, захисники України, представники міжнародних організацій, громадянського суспільства, соціально відповідального бізнесу.
«Повномасштабне воєнне вторгнення росії до нашої
держави поставило перед сферою охорони здоров’я
України нові складні виклики.
Проте майже через рік
впевнено стверджуємо, що
ми тримаємося і ми непохитні.
Але ніхто точно не знає, коли
завершиться війна та скільки триматися
ще. Ми ж точно знаємо, що у наших силах
побудувати таку систему підтримки
психічного здоров’я, яка уже зараз дозволить
отримати комплексну допомогу кожному
і кожній, хто відстоював Україну на полі
бою, хто перебував під окупацією або зазнав

руйнівного впливу війни. Cаме такою є



мета ініціативи першої леді зі створення
Національної програми психічного
здоров’я», — сказав Віктор Ляшко.
USAID залишається відданим стратегії підтримки українців в отриманні необхідних послуг із психічного здоров’я. Під час заходу Джеймс Хоуп засвідчив важливу роль Центру психічного здоров’я та оголосив про підтримку з боку USAID у створенні на базі закладу нового ресурсного центру з питань психічного здоров’я. Створення ресурсного центру — це частина допомоги, яку у розмірі майже 36 мільйонів доларів США USAID виділило від початку війни на розширення доступу до послуг психічного здоров’я та на підтримку ініціативи першої леді України зі створення Національної програми психічного здоров’я та психосоціальної підтримки. Після повномасштабного вторгнення з боку росії потреба у фаховій допомозі у сфері психічного здоров’я в Україні зросла в рази. Створення ресурсного центру за підтримки проєкту USAID «Розбудова стійкої системи громадського здоров’я» допоможе масштабувати досвід «Лісової Поляни» та проводити навчання фахівців, які працюватимуть як в медичних закладах, так і в громадах, надаючи послуги з відновлення психічного здоров’я для постраждалих від психотравмуючих подій. Модель послуг, запроваджена «Лісовою Поляною», вже довела свою ефективність. Тож відтепер навчені за програмою фахівці зможуть застосовувати цю модель для роботи у громадах всієї України, працюючи з ветеранами, їхніми сім’ями та тими, хто зазнав впливу війни.
6 Журнал «Сучасна фармація» • modern-pharmacy.com.ua • 2023 / лютий • Пульс часу • Check point
Презентована модель є мультимодальною. Вона передбачає застосування великої кількості різних підходів, методів, принципів лікування й реабілітації для досягнення найкращого ефекту відновлення психічного здоров’я. ЇЇ основа — підхід до здоров’я людини як до системи, на яку впливають біологічні, психологічні та соціальні чинники. Отже, і допомога має враховувати кожен із цих чинників.
ЦЕ ВАЖЛИВО!!!
Лише 4 % українців звертаються за психологічною допомогою. Система фіксує тільки 10 % громадян
із найпоширенішими психічними розладами.
Модель «Check Point» заснована на багаторічному успішному досвіді роботи з травмами війни у ветеранів. Вона акумулює найкращі світові практики. Модель має робочу назву або ж «Контрольна точка». Так назвав її один із пацієнтів після лікування, зазначивши, що за допомогою даної моделі буквально «перезавантажився». І це, дійсно, — контрольна точка піклування про стан психічного здоров’я: відновлення втрачених сенсів, отримання нових навичок та знань, трансформація травматичного досвіду в посттравматичне зростання.
З огляду на масштаби війни наша країна має потребу у створенні низки реабілітаційних центрів, і презентована модель дозволить зробити роботу таких центрів максимально ефективною.
НА ЗАМІТКУ!!!
Центр «Лісова поляна» — це державний заклад управління Міністерства охорони здоров’я, який є першим в Україні медичним центром зі спеціалізацією на лікуванні психотравми і наслідків
черепно-мозкових травм, а також допомозі особам, які пережили полон та тортури. Команда працює з 2014
року з травмами війни та має великий практичний досвід у наданні послуг, навчанні фахівців, розбудові мережі допомоги для згаданих категорій осіб. Центр акумулює український
та міжнародний досвід, забезпечує навчання, підвищення кваліфікації

фахівців, що реалізується через роботу Тренінгової платформи.
НА ЗАМІТКУ!!!
Безкоштовні ресурси для підтримки психологічного здоров’я українців:


1) UA Mental Help. Благодійна організація UA Mental Health надає 12 безкоштовних консультацій психологів-волонтерів. Звертатися до фонду можуть ті, хто відчувають симптоми депресії, розпач, апатію або інші тривожні стани.


2) ХАБ СТІЙКОСТІ. Це платформа підтримки від благодійного фонду «Брейнкульт» і ГО «Фундація Суспільність». Можна знайти психологічні поради або записатися на відеоконсультацію з фахівцем.
3) СИЛЬНІ. Цей благодійний фонд надає психологічну допомогу постраждалим від сексуального насилля під час війни. Для фонду працюють клінічні психологи, психотерапевти та психіатри, які безкоштовно проводять лікувальні сеанси.
4) РОЗКАЖИ МЕНІ. На цій інтернет-платформі можна отримати безкоштовні консультації тривалістю 30-60 хвилин. Звертатися по допомогу можуть люди, котрі відчувають тривогу, апатію, панічні атаки чи інші прояви депресії.
5) ПОРУЧ. Спільна ініціатива МОН, ЮНІСЕФ, Українського інституту когнітивно-поведінкової терапії та ГО «ВГЦ «Волонтер». Мета проєкту — надати психологічні консультації для підлітків та їх батьків, а також вчителів.
6) TEPLO. Teplo — це додаток для пошуку психолога в онлайн-форматі. Люди, які постраждали від війни, зокрема, переселенці, які втратили дім, можуть отримати допомогу безоплатно. Усі фахівці, які працюють з додатком, — професіонали з досвідом роботи до 15 років.
7) SafeWomenHUB. Платформа створена для надання безоплатної невідкладної психологічної, соціальноправової та гуманітарної допомоги жінкам та дівчатам, які постраждали внаслідок війни, та для підвищення їх обізнаності щодо запобігання різним формам насильства, в тому числі сексуальному насильству.
8) OPEN DOORS. У цьому центрі також можливо отримати безкоштовні психологічні консультації. Фахівці центру фокусуються на травмах, отриманих під час воєнних конфліктів.
9) TELEHELP Україна. Це ініціатива, яку організували студенти Стенфордського університету, щоб підтримати українців в Україні та Польщі.
10) GOTOHELP. Скористатися допомогою психологів-волонтерів можуть усі, хто потребують екстреної психологічної допомоги. Спілкуватися з психологом можливо через Telegram, WhatsApp або відеочат.
За матеріалами https://moz.gov.ua
• 2023 / лютий • Пульс часу • Check point 7
Журнал «Сучасна фармація» • modern-pharmacy.com.ua
ЯК ЖИВЕ І ПРАЦЮЄ
ФАРМАЦЕВТИЧНИЙ

НАЦІОНАЛЬНИЙ
В УМОВАХ ВОЄННОГО ЧАСУ: інтерв’ю з в.о. ректора
Аллою Котвіцькою
Уже рік наша країна протистоїть повномасштабному
військовому вторгненню. Національний фармацевтичний
університет, разом з цілою країною, долає небачені
виклики, живе і працює на передовій освітнього
фармацевтичного фронту. НФаУ робить свій внесок у Перемогу України і розробляє плани на майбутнє.
Журналісти редакції поспілкувались з доктором фармацевтичних наук, професором, Заслуженим
діячем науки і техніки України, в.о. ректора Аллою Котвіцькою.
— Вельмишановна Алло Анатоліївно, 16 листопада 2017 року колектив обрав Вас ректором Національного фармацевтичного університету. Що вдалося і що не вдалося зробити за 5 років на цій відповідальній посаді?
— Почну з того, що свого часу я свідомо обрала професію й жодного разу не пошкодувала про свій вибір. Мій життєвий і трудовий шлях протягом чверті століття поєднаний із життям університету. Тут відбулося моє становлення як людини і фахівця, тут я переживала невдачі та раділа успіхам, помилялася, долала сумніви, зростала, надихалася прикладами учителів і колег. У 2017 році я так само свідомо і цілеспрямовано ухвалила рішення брати участь у виборах ректора Національного фармацевтичного університету. Рішення далося нелегко, але воно було виваженим і відповідальним.
Проведення виборів ректора — це був достатньо
новий досвід для колективу університету. Ми опрацьовували і саму процедуру, і документальне підґрунтя, причому у досить стислі терміни, маючи лише два місяці у запасі.
Підготовка до виборів стала справжнім марафоном. Чимало днів було проведено у дискусіях, сумнівах, за роботою. У результаті моя передвиборча програма охопила всі напрями розвитку університету, розставила акценти, за якими сформувалися 11 стратегічних цілей, що поступово реалізовувалися.

За моєї каденції, відповідно до задекларованих цілей, здійснювалася робота за всіма напрямами роботи. Нарешті вітчизняна фармація має затверджений освітній стан-
дарт; кваліфікаційна назва фахівця гармонізована з європейським простором — тепер наші випускники — фармацевти, а не провізори; ми суттєво просунулися у питаннях безперервного професійного розвитку. Це одні з ключових завдань, які ставив перед собою НФаУ у контексті впливу на формування системи вищої фармацевтичної освіти України.
В університеті створено студентоцентричний простір, де студент — головна фігура, для забезпечення потреб якої працює увесь колектив. Заплановані за цією стратегічною ціллю заходи здійснені. Це й суто утилітарні проєкти, як скажімо, запровадження портфоліо студента з метою формування пакету його особистісних досягнень для подальшого працевлаштування та спрощення алгоритму оплати за навчання. Це також і особливі проєкти, як наприклад, стипендіальний. Він стартував до 100-річчя НФаУ і реалізований у партнерстві з роботодавцями. Здібній молоді університету призначаються іменні стипендії. До проєкту долучилися найпотужніші фармацевтичні компанії та виробники України.
«В університеті створено студентоцентричний
У питаннях удосконалення змісту та якості освіти створено гнучку систему управління змістом освітніх програм з урахуванням думок стейкхолдерів. Університет відкрив низку авторських магістерських програм на вимогу часу, наприклад, «Клінічні дослідження», «Оцінка технологій охорони здоров’я», «Фітотерапія та нутриціологія», «Управління охороною здоров’я та фармацевтичним бізнесом» та інші. Перш ніж оголосити набір за ними, нами ретельно вивчено потребу ринку праці у таких фахівцях. Тож сьогодні маємо чимало охочих навчатися за актуальними освітніми програмами.
УНІВЕРСИТЕТ
8 Журнал «Сучасна фармація» • modern-pharmacy.com.ua • 2023 / лютий • Пульс часу • Інтерв’ю
простір, де студент — головна фігура, для забезпечення потреб якої працює увесь колектив»
Стосовно підтримки дослідницьких ініціатив молоді як одного з напрямів стратегічної цілі № 1, а саме створення студентоцентричного простору, то нами, зокрема, запроваджено конкурс на кращий науковий студентський гурток. Також молодь може випробувати
власні сили у конкурсах «Кращий студент факультету» та «Кращий студент університету». Звісно, що в основі методології цих конкурсів лежать знаннєві критерії, однак має вагу й позанавчальна активність студента.

Так само першочергово підтримується зовнішнє науково-дослідницьке представництво молоді. Наші студенти беруть участь у багатьох конкурсах і проєктах. Із нещодавніх — участь у IV конкурсі стартап-проєктів «Спробуй і ти!». Національний фармацевтичний університет був представлений командою «MycoFuture» зі студентів факультету фармацевтичних технологій та менеджменту спеціальності «Біотехнології та біоінженерія», які розробили бізнес-модель проєкту «Біоматеріал на основі грибного міцелію MycoSub».
Грибний міцелій — екологічна та ресурсоощадна альтернатива іншим видам матеріалів, яка може застосовуватись у виробництві одягу, меблів, інвентарю, обладнання, а також у будівництві та у якості пакувальних матеріалів тощо.
У фіналі конкурсу команда НФаУ представила прототип, на виготовлення якого отримала співфінансування у півфіналі, — біоматеріал з міцелію грибів, отриманий за допомогою експериментальних прес-форм, який пропонується застосовувати як будівельний та пакувальний матеріал. За результатами конкурсу команда НФаУ посіла ІІ місце.
Сьогодні можу сказати, що задекларовані 5 років тому вектори розвитку НФаУ реалізовані на 90 %. Попри зовнішні виклики — спочатку прогнозовані, як, наприклад, погіршення демографічної ситуації, потім
форс-мажорні, пандемія COVID та повномасштабна війна — НФаУ працює. Колектив збережено. Бачення подальшого розвитку є.


— У вересні 2021 року Національний фармацевтичний університет урочисто і гідно відсвяткував поважну дату — свій 100-річний ювілей. НФаУ відомий як законодавець освітніх і наукових традицій, основоположник професійного свята — Дня фармацевтичного працівника України. Чи вдається зберігати давні традиції, а можливо, і створювати нові традиції зараз, під час війни?
— Так, дійсно, у 2021 році наш університет відзначив свій 100-річний ювілей, до якого було реалізовано низку іміджевих заходів: від відкриття скульптурної композиції «Феномен наук про здоров’я» та закладення «Капсули часу НФаУ» до видання ювілейної медалі та створення «Генетичного коду НФаУ». Цього ж року ми відзначали 150-річчя від дня народження ідеолога й засновника НФаУ Миколи Валяшка та 75-річчя Фахового коледжу НФаУ, який разом із ще одним потужним структурним підрозділом — Інститутом підвищення кваліфікації спеціалістів фармації НФаУ — утворюють замкнутий цикл підготовки фармацевтів.
Нагадаю, що у 2019 році ми виступили організаторами проведення урочистостей до 20-річчя Дня фармацевтичного працівника України. Це одна із консолідуючих традицій — шанобливе ставлення до значущих етапів та подій вітчизняної фармації. Інформаційну вагу таких традицій важко переоцінити. Сформована багато років тому, й нині зберігається традиція участі та впливу на діяльність фармацевтичного простору України. НФаУ — серйозний «гравець» на цьому ринку, оскільки забезпечує експорт знань та компетентностей від освітньої спільноти назовні до сфери практичної фармації.

Інтерв’ю
Пульс часу

2023 / лютий
modern-pharmacy.com.ua

•
Не нова традиція — волонтерство, але суттєво употужнена за два минулих роки. Наш колектив багато •
Журнал «Сучасна фармація» •
• 9
років опікується допомогою Харківському спеціальному навчально-виховному комплексу № 8, дитячому хоспісу Харківської міської дитячої лікарні № 5, гематологічному
відділенню КНП «Харківська



«До 2020 року університет не зазнавав такого відчутного впливу, який завдали пандемія COVID та повномасштабна війна. Колектив зміг швидко відкоригувати свою діяльність.
І це, напевно, також нова традиція — стійкість і непохитність».
міська багатопрофільна лікарня № 25». Підтримку надають як
працівники, так і студенти НФаУ.
У 2020 та 2021 роках році ми співпрацювали у питаннях волонтерства з Харківським обласним центром заготівлі та переробки плазми «Харків Плазма», центром вакцинації від COVID-19 у ТЦ «Нікольський», КО «Харківський зоологічний парк».
Під час російсько-української війни, від 24 лютого 2022 року, місія і внесок волонтерів у перемогу стали надзвичайно важливими. У реаліях війни вітчизняні фармацевти здійснюють освітній процес, забезпечують цілодобову роботу аптек, працюють за «першим столом» та на виробництві, сортують ліки, розвантажують гуманітарку, долучаються до роботи волонтерських штабів.
Наприкінці лютого у нашому університеті був утворений і розпочав роботу волонтерський штаб НФаУ.
Його першочерговими задачами були визначені такі: забезпечення продуктами й гігієнічними засобами студентів та їхня евакуація. За зверненнями підтримка надавалася викладачам і співробітникам університету. Здійснювалася фармацевтична опіка навчально-виховного комплексу № 8, надавалася підтримка родині засновника НФаУ Миколи Валяшка. У питаннях гуманітарного забезпечення Волонтерський штаб НФаУ працював у тісному співробітництві з ГО «SOME PEOPLE». До волонтерського руху університету доєдналися викладачі, співробітники і студенти, які продемонстрували активну позицію. Від травня 2022 року викладачі та співробітники НФаУ на волонтерських засадах почали працювати на 2-му регіональному складі лікарських засобів. Безперечно, університет зберігає традиції якості освіти, високого рівня наукових досліджень. Ми пере-
лаштували освітній процес та адміністрування університету на функціонування у дистанційному форматі без втрати якості. Крім освітньої підготовки, звичними стали проведення у ZOOM-конференціях засідань Вчених рад, ректорату, захистів наукових робіт, участь у форумах, конференціях… До речі, у нас створено, апробовано й запроваджено процедуру онлайн-голосувань при ухваленні колегіальних рішень, скажімо, при проведенні конкурсу на посади НПП. Процедура легітимна, прозора, таємність волевиявлення забезпечено.
Збережено традиції проведення рейтингу кафедр та НПП, щоправда, так само онлайн. «Безконтактне» життя змусило нас пришвидшити роботу над системами автоматизованого управління, зокрема, створення модуля з портфоліо викладачів, яке задумане як інструмент автоматичного обліковування результатів роботи НПП. Це також поява нової традиції — електронне рейтингування НПП та кафедр.
До 2020 року університет не зазнавав такого відчутного впливу, який завдали нам пандемія COVID та повномасштабна війна. Колектив зміг швидко відкоригувати свою діяльність. І це, напевно, також нова традиція — стійкість і непохитність.


— Нове сторіччя для НФаУ розпочалося з надзвичайно складних викликів — повномасштабного військового вторгнення країни-агресора. Які рішення Вам як ректору університету фронтового міста довелося ухвалювати у перші дні війни? Які першочергові завдання вирішувати?
— Першочерговим завданням стала безпека наших студентів! Це було головним у перші дні війни. У ході підготовки евакуації нашої молоді університет організував укриття у гуртожитках, забезпечив харчуван-

10 Журнал «Сучасна фармація» • modern-pharmacy.com.ua • 2023 / лютий • Пульс часу • Інтерв’ю
ням
і всім необхідним. Тим
часом вирішувалися
питання, як, куди, яким чином евакуювати студентів?
Три головні питання, на які нашаровувалися ціла низка інших, дотичних до них.
Кожен десятий студент НФаУ — іноземець. Це понад тисяча громадян інших держав. Тож на порядку денному гостро стояло питання щодо їхньої евакуації. Вони потребували особливої підтримки й допомоги, бо доправити їх додому було ще складніше, аніж вітчизняних студентів.
Необхідно було звірити кадровий склад, вирішити питання щодо відновлення освітнього процесу дистанційно. Був проведений аудит щодо критично необхідних для забезпечення життєдіяльності університету працівників. Із деякою частиною працівників, це переважно навчально-допоміжний персонал, університет був вимушений тимчасово призупинити трудові договори. Цього вимагали економічні чинники.
Крім того, серед першочергових рішень було збереження матеріально-технічної бази, зокрема, серверної інфраструктури.
Попри все, у 2022 році університет здійснив два випуски фахівців. Взимку ми традиційно вручаємо дипломи випускникам, які навчалися заочно, влітку — молоді, які вчилася за денною формою. Цьогоріч випуск — вагома як для молодого фахівця, так і для університету подія — став достатньо серйозним випробуванням. Проректорський корпус, деканати, центр інформаційних технологій ретельно опрацювали це питання. Для випускників були підготовлені електронні версії дипломів та забезпечено централізоване отримання дипломів із використанням хмарної платформи Google-диск. Для випускників денної форми, які складали державну атестацію влітку, вона була організована з використанням онлайн та дистанційних технологій, із забезпеченням надійної автентифікації. Тут нам допоміг досвід «ковідного» 2020-го.
Це були непрості завдання, які розв’язувалися спільними зусиллями колективу. Рішення необхідно було ухвалювати «з коліс», оперативно. Швидко змінювана ситуація потребувала утримання під контролем,
ухвалення відповідальних, ефективних адміністративних рішень. Саме тому, як ректор, я навіть не розглядала інші варіанти, крім залишатися працювати у Харкові. Так є і сьогодні.


— Завдяки чому НФаУ вдалося швидко відновити освітній процес?

— У цьому допоміг досвід роботи з дистанційними технологіями.

У 2007 році у НФаУ стартував педагогічний експеримент щодо впровадження очно-дистанційного навчання для здобувачів вищої освіти освітньої програми «Фармація» спеціальності 226 Фармація, промислова фармація за заочною формою підготовки.
До 2015/2016 навчального року, коли ми здійснили перший набір студентів, було створено підґрунтя у вигляді організаційного, матеріально-технічного та кадрового забезпечення. До речі, за цей час підготовлено майже 150 фахівців, які навчалися із застосуванням дистанційних технологій.
Цей досвід допоміг нам у 2020 році, коли світ переживав пандемію COVID. Тоді ми призвичаїлися до роботи у «безконтактних» комунікаціях, разом із усієї системою вищої школи опрацьовували нові формати. В університеті були забезпечені суворі заходи щодо запобігання поширенню коронавірусу. Вважаю, що наш колектив упорався із цим гідно, оперативно реагуючи на вимоги державних установ. До речі, саме Національний фармацевтичний університет став першим у системі медичних ЗВО, який здійснив повну вакцинацію працівників.
У 2020 році ми максимально посилили увагу до дистанційного навчання й охопили дистанційними курсами усі спеціальності. Всупереч невизначеності, навесні 2020 року університет упевнено перелаштувався на дистанційний освітній процес, влітку провів онлайн державну атестацію.

«Наші викладачі — це золотий фонд освітньої фармації. Тож і студенти, і колеги чекають всіх додому до рідного університету»
Вже наприкінці 2020 року розробкою дидактичного наповнення, педагогічних сцена-
Журнал «Сучасна фармація» • modern-pharmacy.com.ua • 2023 / лютий • Пульс часу • Інтерв’ю 11
ріїв, методичних рекомендацій до дистанційних курсів опікувалися всі кафедри, і приблизно половина НПП пройшли підготовку або підвищення кваліфікації з питань навчання із застосуванням дистанційних технологій.



На сьогодні ми суттєво просунулися у цьому напрямі й маємо дійсно унікальний досвід, сертифікованих т’юторів, відповідне методичне забезпечення.
Саме тому суто організаційно відновити освітній процес навесні 2022 року, у турбулентній ситуації, нам вдалося досить швидко.
— Чи вдалося зберегти колектив науково-педагогічних працівників?
— Так, колектив НПП НФаУ збережено. Частина наших професорів і доцентів були змушені покинути рідні домівки. Хтось втратив житло, комусь довелося перевозити у більш безпечне місце дітей та батьків. Ті, хто знаходиться в Україні, працюють дистанційно. Щодо перебування за кордоном — за межами нашої держави знаходиться незначна кількість НПП.
Однак дехто вже повернувся, дехто планує найближчим часом. Наші викладачі — це золотий фонд освітньої фармації. Тож і студенти, і колеги чекають всіх додому — до рідного університету.
— Які рішення Вам доводиться ухвалювати зараз, коли війна ще триває?
— Сьогодні доводиться ухвалювати рішення переважно із площини кризового менеджменту, головні виміри якого «вчора-сьогодні-завтра». Як і інші ЗВО, маємо певні фінансові труднощі. Але наш колектив зробив усе можливе, щоб здійснити набір студентів на поточний навчальний рік. Вступна кампанія здійснювалася у кілька «хвиль». Наша спеціальність завжди була затребуваною, а у нинішніх умовах вона є критично необхідною, тож ми були зобов’язані утримати безперервність забезпечення кадрами фармації.
Задля забезпечення кадрами фармації, яка сьогодні цього гостро потребує, ми взаємодіяли з МОН та МОЗ
України щодо збільшення місць державного замовлення на підготовку фармацевтів, брак якого протягом багатьох років відчувала фармацевтична освіта. Наприклад, у 2018 та 2019 роках, як і тривалий час до цього, державне замовлення знаходилося у межах 10 місць. На кількість місць державного замовлення впливав той факт, що в Україні неухильно зменшувалася кількість аптек комунальної власності. Це негативна тенденція, яка продемонструвала хибність державної політики вже у 2020 році. Ми неодноразово зверталися до МОЗ України з обгрунтуванням необхідності збільшити державне замовлення, а також зберегти мережу комунальних аптек. Лише з 2020 року почалося поступове збільшення обсягу державного замовлення, спочатку до 20 місць. У 2021-му — до 50 місць. 2022 рік беззаперечно визначив необхідність функціонування комунальних аптек та підготовки для них кадрового потенціалу. На противагу приватним, значна частина яких згорнула свою діяльність, саме комунальні аптеки продовжили працювати в умовах воєнного стану, забезпечуючи населення ліками та виконуючи головну соціальну функцію — бути закладом охорони здоров’я.

У 2022 році НФаУ отримав державне замовлення на підготовку кадрів у обсязі 120 місць: за спеціальністю 226 Фармація, промислова фармація — 105, за спеціальністю 227 Фізична терапія, ерготерапія — 10 місць, за спеціальністю 224 Технології медичної діагностики та лікування — 5 місць.
Хочу висловити вдячність МОЗ України за посилення уваги до фармацевтичного сектора, розуміння щодо необхідності відновлення мережі комунальних аптек, підтримку фармацевтичної освіти.

Національний фармацевтичний університет виконав державне замовлення у повному обсязі. Думаю, це промовистий факт.
— 2022 рік — це рік важких випробувань.
Але цей рік багато чому навчив українців: об’єднуватися, допомагати один одному і вірити в свою державу. Що вдалося і що не вдалося зробити НФаУ і особисто Вам у 2022 році?
12 Журнал «Сучасна фармація» •
• 2023 / лютий • Пульс часу • Інтерв’ю
modern-pharmacy.com.ua
— НФаУ живе і працює в умовах воєнного стану. Частина наших студентів і співробітників захищають країну на фронті. На жаль, гіркі втрати не оминули наш університет.
Війна дещо змістила пріоритети, деякі цінності посилила, деякі, що видавалися важливими, зробила дрібними й не вартими уваги. Ми змінилися. Ми об’єдналися. Ми маємо спільне для всіх бажання і працюємо, щоб воно здійснилося.
Викладачі, що знаходяться у Харкові чи тимчасово переїхали до інших регіонів України, проводять дистанційно заняття, продовжують наукові дослідження на основі договорів про співпрацю з іншими університетами та фармацевтичними виробництвами. Студенти готові отримувати знання, викладачі готові працювати — онлайн, в умовах обмеженого доступу до зв’язку та електроенергії. Треба вийти на лекцію — заряджають ноутбуки від автомобільних акумуляторів. Поки є світло, проводять заняття, потім їдуть по родичах та знайомих, у яких на даний момент є електропостачання, у інші райони міста. Що це, як не патріотизм викладачів? Нам вдалося зберегти неперервність фармацевтичної освіти і свій університет.
У 2022 році завершилася моя каденція, сплив термін мого перебування на посаді ректора НФаУ, і наразі НФаУ мав уже провести нові вибори. На сьогодні маємо «в.о. ректора», оскільки, як визначено чинною нормативною базою, під час воєнного стану вибори не можуть бути проведені. Поточна ситуація у країні, на жаль, не дозволяє поки що прогнозувати, скільки часу це триватиме.

— Національний фармацевтичний університет відомий в Україні та за її межами як флагман фармацевтичної науки. Що зробили науковці університету для захисників України?
— Національний фармацевтичний університет має у своєму портфелі цілу низку лікарських засобів, які визнані національними брендами. І наукові дослідження не припиняються. Свої знання для допомоги захисникам України університет трансформував у два нових препарати.

Мова йде про кровоспинний засіб місцевої дії з антисептичним ефектом «Plantor» та засіб для про-
філактики відморожень «Глюцинковіт». Розробниками ліків виступили завідувач кафедри фармакології та фармакотерапії НФаУ, професор, доктор медичних наук Сергій Штриголь та доктор фармацевтичних наук, професор кафедри фармакогнозії НФаУ Олег Кошовий.

«Plantor» — оригінальний представник нової фармакологічної групи гемостатиків контактної дії (гемостопів). Препарат рятує життя в польових умовах, коли утруднений процес евакуації пораненого до шпиталю. Особливість ефекту цього препарату полягає в тому, що швидко утворений згусток крові добре утримується в рані, запобігаючи кровотечі, залишається в ній тривалий час без запальної реакції і легко видаляється при подальшій хірургічній обробці. Час зупинки кровотечі при застосуванні «Plantor» становить у середньому 4 хв. при нормативі для подібних засобів до 13 хв. Препарат зареєстрований в Україні й виготовляється виключно для потреб захисників України на фронті. «Глюцинковіт» — препарат нової групи фригопротекторів, що збільшує опірність організму до впливу холоду. Він містить глюкозаміну гідрохлорид, що має виразні фригопротекторні властивості, три вітаміни, що доповнюють дію глюкозаміну (аскорбінова кислота, рутин, рибофлавін), і цинку піколінат, який має імуномодулювальні властивості.
За розробку цих ліків у рамках реалізації міжнародного благодійного проєкту щодо забезпечення українських військових необхідними ліками Сергій Штриголь та Олег Кошовий отримали подяки від Благодійного фонду «Волонтери світу».

— Національний фармацевтичний університет має потужне студентське самоврядування. Як працює студентське самоврядування під час війни?
— Студентське самоврядування НФаУ — це сильна, розумна, активна молодь, як власне, студентство НФаУ в цілому. Представники студентського самоврядування практично з перших днів війни долучилися до проведення інформаційної кампанії НФаУ, почали писати власні есе у соцмережах, підтримувати один одного, тому, з оглядом на певні організаційні труднощі, швидко повернулися до щоденних тур-
Журнал «Сучасна фармація» • modern-pharmacy.com.ua • 2023 / лютий • Пульс часу • Інтерв’ю 13
Інтерв’ю
•
Пульс часу
•
2023 / лютий
•
modern-pharmacy.com.ua
•
бот. Їхня самоорганізованість, ініціативність радують. Ця молодь знає, у якому напрямі рухається, й має чітке уявлення щодо того, чого прагне. Вона має вірні цінності й цілі!

Студентське самоврядування
в нашому університеті завжди було


впливовим і активним. Спільнота студентів представлена в усіх колегіальних ор-

ганах НФаУ, як того й вимагає чинне законодавство.

Незважаючи на важкий час, 12 жовтня 2022 року у онлайн-форматі були проведені чергові вибори делегатів серед здобувачів вищої освіти до конференцій студентського самоврядування та трудових колективів факультетів, Вчених рад факультетів.
Як і до війни, студентське самоврядування активно працює, ініціює проведення флешмобів та конкурсів, інформаційних заходів, допомагає у презентації
НФаУ та професії фармацевта.
Пишаємося тим, що наші студенти стали переможцями та лауреатами конкурсу «Молода людина року 2022», який проводиться у межах реалізації міської програми «Молодь Харкова». Наші студенти гідно представили НФаУ в номінаціях «Студенти закладів вищої освіти І-ІІ рівнів акредитації», «Студенти (курсанти) закладів вищої освіти ІІІ-ІV рівнів акредитації», «Наукова діяльність», «Волонтерська діяльність». Це є демонстрацією активної життєвої позиції нашої молоді. Це не може не надихати.
«Студентське самоврядування НФаУ це сильна, розумна, активна молодь, як власне, студентство НФаУ в цілому» Журнал «Сучасна фармація»
На задоволення запитів студентської молоді, НФаУ завжди організовував різноманітні зустрічі з представниками практичної фармації. Це можливість прямих діалогів студентів із роботодавцями, які, за відгуками молоді, є корисними для орієнтації у професії. Останнім часом ці зустрічі відбуваються онлайн. Так, восени відбулася онлайн-зустріч із фахівчинею відділу підбору та адаптації АТ «Фармак» Іриною Воскрес, у ході якої студенти мали нагоду ознайомитися з діяльністю вітчизняного фармацевтичного гіганта, зокрема, й навчальними проєктами для молодих фахівців та можливостями кар’єрного росту на підприємстві.
Вважаю, що партнерство нашого університету із провідними фармацевтичними підприємствами, зокрема у освітньо-інформаційних питаннях — запорука успішного функціонування і університету, і практичної фармації.
Студентське самоврядування НФаУ ініціювало проведення заходів до Міжнародного дня студента. Відбувся онлайн «Farm battle», до якого долучилися всі факультети. Організатори провели інтелектуальну гру Quiz із запитаннями з історії України, історії фармації та НФаУ. Учасники команд отримали сертифікати на онлайн семінар-тренінг зі стратегічного менеджменту, онлайн-екскурсію до інтерактивного музею «D.S. Таємна аптека», онлайн-тренінг з надання першої домедичної допомоги.
До Міжнародного дня студента відбулася також зустріч студентського самоврядування з ректором, у рамках якої було обговорено низку нагальних питань, та вручення подяк фармацевтичній молоді від Харківської міської ради — за активну громадянську позицію і формування інтелектуального потенціалу України. Подяками відзначено 4 студентів НФаУ. Двоє студентів отримали подяки особисто. Подяки ж для двох студенток, які стали до лав ЗСУ та не були присутніми на зустрічі з мером Харкова Ігорем Тереховим, отримала ректор. Ми урочисто вручимо їх нашим дівчатам-захисницям, коли вони повернуться на навчання. Студентське самоврядування — активна і дуже креативна молодь. До Міжнародного дня студента вони ініціювали проведення електронного флешмобу #ястудентнфау. Наші соціальні мережі вибухнули яскравими, змістовними відеосюжетами та світлинами студентського життя. Це ілюстрація любові до свого університету, фармації, України. Переконана, що ми маємо дякувати нашій фармацевтичній молоді за те, що дає привід пишатися нею, змушує поглянути на те, чим вона живе, з іншого ракурсу.
Незвичайним виявився ще один проєкт до Міжнародного дня студента — «Чародійна школа науки «Pharmaceutical Hogwarts» за мотивами «Гаррі Поттера». Креативна фармацевтична молодь представи14
ла роботи на тему «Нефармацевтичні винаходи фармацевтів». Проєкт відбувся онлайн, конкурсні відеороботи та есе розміщувалися у соцмережах, а переможець визначався за кількістю «вподобайок» під кожною роботою.
За ініціативи студентського самоврядування у нашому університеті вже кілька років поспіль відбуваються зустрічі ректора зі студентами першого курсу «100 днів в НФаУ: мотивація та її реалізація». Ми не відступили від традицій проведення цієї зустрічі, однак цьогоріч вона відбулася також онлайн.
Вважаю таку взаємодію з молоддю надзвичайно важливою. Це змістовні та результативні зустрічі, під час яких обговорюються питання, що хвилюють студентство. І повірте, цих питань завжди було чимало, а наразі стало ще більше — через інші формати навчання, роботи, дозвілля. Університет і я особисто не полишаємо поза увагою потреби студентства.

— Слово «фармація» жіночого роду. Ви ж перша жінка-ректорка, лідерка, яка надихає багатьох. А що надихає особисто Вас?
— Так, справді, за 100-річну історію біля «керма» університету були переважно ректори-чоловіки. Але у часи другої світової війни нашу Alma Mater вже очолювала жінка — Марія Волинська.
Сьогодні Україна протистоїть відкритій агресії сусідньої держави. Надважкий час, який зцементував українців, висунув на перший план спільні орієнтири — свободу, незалежність, патріотизм. Маємо засвоювати історичні уроки та йти власним шляхом. І ми це робимо, бо гідні бути вільними.
Якби у мене запитали, які головні слова року 2022, мабуть, я б віддала перевагу таким: «запас міцності». Про це свідчать загальні суспільні тенденції та сила прагнення до Перемоги. Про це свідчить і єдність команди НФаУ. Відтак, відповідь на запитання «Що надихає мене?», є такою: «Колектив університету».
Він надихає та надає впевненості. «Спільнота студентів». Вони діляться своєю енергією та цілеспрямованістю. «Фармацевтичний університет». Це моє місце сили.
— Зараз всі українці впевнені, що 2023 рік стане переможним. Які плани має НФаУ після Перемоги України?

Думаю, що вітчизняна вища школа тривалий час відчуватиме певну анемію й потребуватиме відновлення. Необхідно буде вибудовувати таргетну «терапію» — за кожним напрямом, у взаємодії держави та освітянської спільноти.
Якщо ми говоримо про цілі саме НФаУ, то, насамперед, це повернення до аудиторій та лабораторій студентства і викладачів. Потребуватиме чималих зусиль відновлення контингенту іноземних студентів. І це не до питання про суто Національний фармацевтичний університет. Це до питання про відновлення статусу Харкова як студентської столиці та іміджу України у міжнародному освітньому просторі.
Важливо забезпечити швидке повернення до довоєнного рівня наукових досліджень та поширення наукових знань й масштабувати їх. Маємо також завершити роботу щодо представленості єдиного вітчизняного фармацевтичного університету у міжнародних рейтингах. Не встигли у 2022-му.

Вважаю, що потрібно буде вшанувати фармацевтів, які захищали Україну. Можливо, у вигляді меморіального комплексу. Але незалежно від формату — обов’язково! Це звитяжне покоління стрижневої професії охорони здоров’я.
Не втомлюся повторювати, що колектив НФаУ — не просто особовий склад університету чи колектив фахівців, які об’єднані спільністю діяльності. Це команда, у якій три чверті — випускники НФаУ, які, як і я, виросли у цьому університеті, люблять його, віддані йому. Саме тому вирішення завдань будь-якої складності з такою командою є швидким, конструктивним, результативним.
«Якби у мене запитали, які головні слова року 2022, мабуть, я б віддала перевагу таким: “запас міцності”. Про це свідчать загальні суспільні тенденції та сила прагнення до Перемоги. Про це свідчить і єдність команди НФаУ»

Все залежить від нас, бажання і сили будувати майбутнє. Ми їх маємо, і всі втрачені можливості обов’язково надолужимо після війни.
ВСЕ БУДЕ УКРАЇНА!
В.о. ректора НФаУ Алла Котвіцька
Журнал «Сучасна фармація» • modern-pharmacy.com.ua • 2023 / лютий • Пульс часу • Інтерв’ю 15
КАР’ЄРА І НОВІ
ЗНАННЯ:
які можливості
відкриває для
молоді програма
«Подорожник START»
У мережі аптек «Подорожник» понад рік діє платформа можливостей для
молоді «Подорожник START». Над
програмою працює окрема команда, а
участь в ній взяли близько 706 студентів.
Менеджери мережі відзначають плідні результати роботи. Адже 25 студентів уже
працевлаштувалися в центральному офісі
компанії у Львові, ще понад 250 — по мережі.
Мета дії платформи — надати молоді можливості для професійного розвитку та показати перспективи фармацевтичної сфери. Адже під час стажування
учасники програми «Подорожник START» здобувають
цінний досвід і знання від провідних фахівців мережі.
Подорожник START співпрацює з понад 30-ма закладами вищої освіти України, щоб залучати студентів. Серед них Львівський національний університет імені Івана Франка, Національний фармацевтичний університет, Міжнародний гуманітарний університет м. Одеса, Національний університет «Львівська політехніка», Київський національний університет ім. Тараса Шевченка та інші.
«Ми хочемо, щоб до програми могли долучатись студенти по всій країні. Адже наші аптеки є повсюди і талановита

молодь потрібна. У нас вони мають
можливість пізнати бізнес-середовище
під керівництвом топових спеціалістів і професійно реалізуватись. Ми вкладаємо у стажування студентів багато сил і залучаємо найкращих своїх фахівців, адаптовуємось до змін в освіті. Плекаємо лідерів фарміндустрії в майбутньому, які розвиватимуть галузь разом з Подорожником», — розповів СЕО мережі аптек «Подорожник» Тарас КОЛЯДА.
ТАРАС КОЛЯДА, виконавчий директор мережі аптек «Подорожник»
Платформа надає кожному однакові умови для розвитку свого потенціалу. У рамках «Подорожник START» є програма стажування «Облік і аудит», стажування в юридичному відділі компанії, можливість пройти практику та інтернатуру. Cтуденти подають заявку, проходять співбесіду і за результатами відбору потрапляють до програми.
«Шукаємо вмотивованих студентів і тих, хто готовий вчитися. При цьому ми відкриті до молоді в будь-якому департаменті компанії. З радістю їх заохочуємо відповідно до талантів і зацікавлень. Також ділимось різними порадами, як скласти резюме, пройти
співбесіду. Рекомендуємо корисну літературу для розвитку, фільми, розвіюємо міфи про професію», — сказав Коляда.
СЕО найбільшої мережі аптек «Подорожник» особисто зустрічається зі студентами програми стажування. Він пригадує, що колись сам був таким, як вони і починав з нуля.
16 Журнал «Сучасна фармація» • modern-pharmacy.com.ua • 2023 / лютий • Пульс часу • Подорожник START
Учасники
програми стажування
«Облік та аудит 2.0»

«Хочу, щоб на моєму прикладі та досягненнях вони побачили, що праця й навчання дають результати. Переконаний, що з «Подорожник START» ми отримаємо професіоналів найвищої кваліфікації. У найближчому майбутньому вони піднімуть фармринок на новий рівень разом з мережею аптек «Подорожник», — поділився Тарас Коляда.
По закінченню програми, окрім можливості працевлаштуватися, кожному студенту вручають рекомендаційний лист і сертифікат. Програма «Подорожник START» розвивається і працює. Студентів запрошують випробувати свої сили. Долучитись до платформи можна, заповнивши форму реєстрації на сторінці Instagram @podorozhnyk_start.
CEО Тарас Коляда разом з командою та учасниками платформи для молоді «Подорожник START»
ДОВІДКА ПРО КОМПАНІЮ: Група компаній мережі аптек «Подорожник» на фармацевтичному ринку понад 23 роки. Група налічує понад 1500 аптек, розташованих у всіх областях України. Постійними клієнтами мережі є понад 7 мільйонів українців, щодня аптеки відвідує близько 300 тисяч покупців.


Журнал «Сучасна фармація» • modern-pharmacy.com.ua • 2023 / лютий • Пульс часу • Подорожник START 17
ГАЛУЗІ У ФАРВАТЕРІ ГАЛУЗІ
c.20
Компанія «Фармак» визнана кращим роботодавцем 2022 року

c.21
Панжест — мікробні ферменти для лікування органів травлення


c.28
Як зберегти та активізувати життєві ресурси в умовах війни?
c.31
Неовітам® — надійний помічник у боротьбі з хронiчним болем






c.36
Аптечна мережа 9-1-1: Під опікою не тільки люди, а й тварини

Fides facit fidem Довіра викликає довіру

У ФАРВАТЕРІ ГАЛУЗІ У ФАРВАТЕРІ

Компанія «Фармак»
визнана кращим
роботодавцем



2022 року
за версією Спілки Українських Підприємців
Цього року війна по-справжньому випробувала та загартувала український бізнес, який вже десятий місяць поспіль демонструє світу свою стійкість.
Спілка Український Підприємців, найбільша в
Україні платформа, що об’єднує голос понад
1000 український бізнесів, оголосила переможців
«Премії СУП 2022: незламний бізнес». В номінації
«Найкращий роботодавець року» нагороду отримала фармацевтична компанія «Фармак».
ПРЕМІЯ СУП — це щорічна відзнака проривних
бізнес-практик серед учасників спілки.
Голосування за номінантів було відкритим та проходило на офіційному сайті СУП. Наступним

етапом відбору стало голосування експертних
членів журі.
Під час війни особливо важливою є організація безпеки співробітників та всебічна підтримка команди. Так, попри знищення ворогом складу із готовою
продукцією та пакувальними матеріалами на суму понад 1,5 млрд грн, «Фармак» продовжив фінансові виплати, а у жовтні 2022 року збільшив зарплати всім працівникам компанії.
Працівники, що втратили житло через воєнні дії, отримали додаткову допомогу від підприємства. На це компанією було виділено понад 4 млн грн. Також «Фармак» релокував своїх фахівців із Харкова, де у компанії була дослідницька лабораторія, до Києва. Медичних працівників з окупованих територій, регіонів, де ведуться активні бойові дії, було працевлаштовано в більш безпечних містах України. Тих співробітників, які відправилися захищати Батьківщину на фронт, а їх 60, компанія повністю забезпечила військовою амуніцією.
«Фармак» також докладав всіх можливих зусиль для створення безпечних умов роботи на підприємстві в умовах війни. Компанією оснащені сучасні укриття на заводах у Києві та Шостці, що здатні витримати бомбовий чи ракетний удар, а також, завдя-
ки потужним фільтраційним системам, захистити від хімічної, бактеріологічної та радіаційної небезпеки. Крім того, компанія організовує транспортні засоби для доставки в умовах воєнного стану працівників з дому до підприємства та з підприємства додому.
Навіть під час війни співробітники компанії мають хороший соціальний пакет з 2-х ступеневим медичним страхуванням, можливості професійного та особистісного розвитку, щорічного скринінгу здоров’я та програми з підтримки ментального здоров’я. «Головне завдання і досягнення цього року — те, що нам вдалося зберегти нашу команду. Наші люди — це не просто професіонали з великої літери, а і фундамент компанії «Фармак». Це українці, які виготовляють ліки для українців. З перших днів війни вони виходили працювати під обстрілами, щоб не допустити дефіциту лікарських засобів у країні. І те, що не зважаючи на всі втрати, які ми понесли через ворога, нас визнали кращим роботодавцем — найважливіша відзнака, яку ми б хотіли отримати у 2022 році», —
зазначає виконавчий директор «Фармак»
Володимир Костюк.
20 Журнал «Сучасна фармація» • modern-pharmacy.com.ua • 2023 / лютий • У фарватері галузі • Події
ПАНЖЕСТ

мікробні
ферменти для
лікування органів
травлення
Проблема функціональних захворювань органів травлення в останні роки набуває все більшої актуальності, що обумовлено великою поширеністю цієї патології і пов’язаними з нею чисельними проблемами. За результатами багаточисельних епідеміологічних досліджень, до 50–60 % дорослих та до 30–40 % дітей, які звертаються до лікарів-гастроентерологів, мають ті чи інші функціональні розлади травної системи. Кожен другий мешканець нашої планети страждає на такі захворювання, як невиразкова диспепсія, дисфункція жовчовивідних шляхів, синдром подразненого кишківника, які значно обмежують соціальну і трудову діяльність. У всьому світі на діагностику і лікування функціональних захворювань шлунково-кишкового каналу щорічно витрачаються сотні мільйонів доларів [1, 2].
Функціональні розлади травного каналу — це різноманітні комбінації хронічних та/або рецидивуючих симптомів, які часто свідчать про порушення рухової функції і чутливості шлунково-кишкового каналу. Не створюючи загрози для життя, вони суттєво погіршують його [2].
AМарина Остапець, кандидат медичних наук, доцент кафедри нормальної та патологічної
фізіології Національного фармацевтичного



університету

Що спричиняє функціональні розлади травлення?
Серед можливих факторів ризику, що призводять до виникнення функціональної диспепсії, розглядають спадковість, порушення моторної функції шлунково-кишкового каналу, інфікування гелікобактерною інфекцією, психосоціальні чинники. Певну роль відіграють зловживання алкогольними напоями, міцною кавою і харчовими продуктами, що викликають порушення процесу травлення. Власне, варто пам’ятати наскільки велике значення для організму людини має склад раціону, а також кількість і якість продуктів, з яких готуються страви. І якщо деякі з чинників змінити не можна, то характеристики продуктів харчування можуть бути повністю контрольованими [3, 4].
На сьогодні відмічається недостатня інформованість пацієнтів з функціональними розладами органів травлення щодо принципів раціонального харчування та впливу продуктів харчування на стан здоров’я.
Журнал «Сучасна фармація» • modern-pharmacy.com.ua • 2023 / лютий • У фарватері галузі • Фармакотерапія 21
ЦЕ ЦІКАВО!!!
У дорослої людини довжина підшлункової
залози становить 14–18 см, ширина — 3–9 см, товщина — 2–3 см, вага — 70–80 г. Підшлункова
залоза — залоза змішаної секреції: вона
продукує гормони інсулін та глікоген, які надходять безпосередньо у кров і регулюють вуглеводний та жировий обміни в організмі, а також низку ферментів, які беруть безпосередню

участь в процесі травлення.
Близько 300 р. до н. е. Герофіл першим назвав панкреас залозою. Втім свою назву цей орган
отримав лише через 400 років, коли інший
грецький хірург і анатом Рупос назвав залозу
підшлунковою, що означає «все м’ясо»ймовірно, через відсутність у ній кісток і хрящів.
«Черевна слинна залоза» — так називали підшлункову залозу сто років тому. А ще раніше ця залоза вважалася м’якою «подушкою»
для шлунку, придатком печінки («печінковим
пальцем»). У ІІ ст. н.е. її взагалі вважали м’язом. Плутали її і з лімфатичними вузлами черевної порожнини. Плуталися до того, що стали називати навіть «безіменним органом».
Хоча давні греки знали про підшлункову залозу, її функція і будова були не повністю зрозумілі протягом століть. Це змінилося у 1642 р., коли німецький анатом Йоганн Георг Вірсунг виявив протоку підшлункової залози після розтину людини, страченої за вбивство. Вірсунг був
NOTA BENE!!!
Герофіл — давньогрецький анатом і хірург
Йоганн Георг Вірсунг (1589, Аугсбург, Німеччина)


- німецький анатом. Тривалий час працював прозектором у Падуї.
убитий наступного року, ймовірно, через
розбіжності з приводу того, хто насправді був «першовідкривачем» анатомії залози.
В XVII ст. підшлункову залозу нарешті детально
описали, а Клод Бернар — великий французький
фізіолог XIX ст. — відкрив її роль у травленні.
Поступово накопичувалося все більше даних, що вона виробляє не слину, а іншу за хімічним складом рідину — підшлунковий сік.

Протягом доби підшлункова залоза людини
виробляє 1,5–2,0 л соку, який починає виділятися

через 2-3 хв. після початку їди. Цей сік містить
усі необхідні ферменти, які допомагають

перетравленню білків, жирів і вуглеводів у кишечнику.
Підшлункова залоза щодоби виділяє 2,5 л панкреатичного соку, який містить 3 групи травних ферментів:
протеази, ліпази амілази.
Протеолітичні ферменти (трипсин, хімотрипсин, еластаза, карбоксипептидаза А і В) є ендопептидазами, що розривають внутрішні зв’язки між амінокислотами.
Ліполітичні ферменти — ліпаза, фосфоліпаза А2, коліпаза, карбоксилестераза. Ліпаза розщеплює тригліцериди, коліпаза є її каталізатором, а фосфоліпаза гідролізує фосфатидилхолін. Субстратом карбоксилестерази є ефіри холестерину. Альфа-амілаза розщеплює крохмаль і глікоген.
22 Журнал «Сучасна фармація» • modern-pharmacy.com.ua • 2023 / лютий • У фарватері галузі • Фармакотерапія
Екскреторна недостатність підшлункової
залози виникає внаслідок порушення гідролізу білків, жирів і вуглеводів панкреатичними ферментами у порожнині дванадцятипалої
кишки. Причин виникнення цього синдрому багато: хронічний панкреатит, муковісцидоз, резекція підшлункової залози, резекція шлунку, печінкова недостатність та ін.
Залежно від механізму розвитку можна виділити 3 форми екскреторної недостатності підшлункової залози. Первинну поділяють на абсолютну (коли відбувається справжнє зниження синтезу ферментів і бікарбонатів панкреатичного соку) та відносну (за повної або часткової обструкції панкреатичних протоків і порушення надходження соку до дванадцятипалої кишки — хронічний панкреатит, муковісцидоз). Вторинна обумовлена патологією інших органів і порушенням дії ферментів на відповідні субстрати за нормального синтезу та надходження панкреатичного соку до дванадцятипалої кишки [1, 3, 5].
ЦІКАВІ ФАКТИ!!!
• Довжина тонкої кишки становить близько 7 метрів, а ширина — приблизно 2,5 см у діаметрі. Тобто площа поверхні тонкого кишечника становить близько 0,6 м². Насправді його площа — близько 250 кв. м, що можна порівняти з площею тенісного корту.
• Кишкові гази є поєднанням поглиненого повітря і газів, що виникають при ферментації бактерій у шлунковокишковому тракті. Травна система не може поглинати лише певні компоненти їжі — деякі речовини просто потрапляють у товстий кишечник, де починають працювати цілі полчища кишкових бактерій, виділяючи різні гази, у тому числі вуглекислий газ, водень, метан і сірководень.
• Ендоскоп — це інструмент, що використовується для вивчення органів та порожнин усередині тіла. На початку XIX ст. французький хірург Антуан Жан Дезормо
• 2023 / лютий • У фарватері галузі • Фармакотерапія
modern-pharmacy.com.ua


Фармакотерапевтичні підходи до лікування функціональних розладів травної системи
Одним із пріоритетних напрямків у лікуванні і профілактиці функціональних розладів шлункового-кишкового тракту є застосування як в монотерапії, так і в комбінації з іншими лікарськими засобами ферментних препаратів [6, 7].
Ферментні препарати використовуються в гастроентерологічній практиці близько 100 років з однією метою — як засоби замісної терапії для корекції екскреторної недостатності підшлункової залози, найчастіше за наявності хронічного панкреатиту.
Сьогодні на фармацевтичному ринку України є широкий вибір поліферментних препаратів, що ста-
вить перед лікарем складне завдання добору найефективнішого та доступного пацієнтові. Необхідно враховувати стандартні міжнародні вимоги, що висуваються до таких засобів [6, 7]:
стійкість до дії соляної кислоти; оптимальна дія в діапазоні рН 4–7;

вміст достатньої кількості активних ферментів, що забезпечують розщеплення нутрієнтів; рівномірне та швидке перемішування з їжею; одночасний пасаж з їжею через пілоричний сфінктер до дванадцятипалої кишки; швидке вивільнення у просвіті дванадцятипалої кишки; безпечність, відсутність токсичності.

• 23

розробив інструмент для вивчення сечовивідних шляхів і сечового міхура, який він назвав «ендоскоп». У 1868 р. німецький лікар Адольф Куссмауль використав ендоскоп, щоб уперше зазирнути всередину шлунку живої людини. На відміну від сьогоднішніх ендоскопів, інструмент Куссмауля не був гнучким, отже ним було важко управляти. Тому Куссмауль використовував досвід людей, здатних легко заковтувати шпагу довжиною близько 47 см і шириною 1,3 см — саме такого розміру розроблений ним прилад. Журнал «Сучасна фармація»
На українському фармацевтичному ринку представлений інноваційний ферментний комплекс, що виготовляється з мікробіологічної сировини. Це ПАНЖЕСТ® виробництва AORA HEALTH S.L., Іспанія для АТ «Фармак», який містить комплекс із восьми високоактивних ферментів. Ферменти у складі ПАНЖЕСТ® ретельно підібрані з урахуванням їх активності при різних значеннях рН шлунково-кишкового тракту.


Склад капсули
.Одиниці виміру ферментів: FIP (Міжнародна фармацевтична федерація), HUT (одиниці вимірювання гемоглобіну

на основі тирозину), DU (одиниці декстринізації), GalU (одиниці вимірювання активності галактозидази), AGU (одиниці вимірювання амілоглюкозидази), SAPU (одиниці вимірювання спектрофотометричної кислої протеази), PC (одиниці мікробної протеази).
Дослідження, які обґрунтовують використання мікробних ферментів для лікування розладів травлення [8]
Проведене дослідження на базі університету La Universidad Politecnica de Valencia Espana (Валенсія, Іспанія, 2016 р.) дозволило оцінити гідролітичну активність мікробних ферментів. Методологія базувалась на перетравленні стандартної порції їжі (55,6 г згідно з Minekeus et al. 2014 р.), що містить жир, вуглеводи, білки та клітковину in vitro. З цією метою використовувалась стандартизована система відтворення травлення у шлунку та кишечнику. Цей підхід дозволив підтвердити повний розпад зовнішньої капсули в кислих умовах шлунку та внутрішньої капсули при більш лужному рН кишечника. У цьому дослідженні порівнювали травлення під впливом ПАНЖЕСТ® та препарату на основі панкреатину тваринного походження, що має галенову форму кишкорозчинних гранул. З точки зору перетравлювання жирів суміш ПАНЖЕСТ® ефективніша, ніж панкреатин тваринного походження, в індукції ліполізу. Перетравлювання жирів стало більш ефективним через 2 години процесу травлення. Це важливо, оскільки це допоможе запобігти розладу травлення після надходження їжі в кишечник. Як і очікувалось, тваринний панкреатин був неактивним при цих значеннях рН, оскільки його доставка відбувається у кишковорозчинних гранулах, щоб уникнути інактивації кислотою. Крім того, посилення ліполізу на вході в дванадцятипалу кишку (+19 разів) свідчить про те, що мікробні ліпази є високоефективними та стабільними в цих умовах травлення. З точки зору перетравлювання вуглеводів, амілази та глюкоамілази продемонстрували активність

у кислих умовах шлунку. Як і очікувалось, тваринний панкреатин був неактивним при цих значеннях рН, оскільки його доставка відбувається у кишковорозчинних гранулах, щоб уникнути інактивації кислотою. Гліколіз, індукований сумішшю ПАНЖЕСТ®, розпочався через 20 хв. початку процесу травлення, а через 2 год. у шлунку він був ефективнішим (+7 разів), ніж при застосуванні панкреатину тваринного походження. Крім того, стабільність ферментів у кишечнику була очевидною, а швидкість травлення зберігалася протягом 2 год. перебування у кишечнику.
Ефективність протеолізу під впливом суміші ПАНЖЕСТ® була очевидною після 2 год. травлення у шлунку, хоча існувала можливість насичення ферменту під час перебування у кишечнику, при цьому ферменти зберігали протеолітичну активність протягом 2 год. у кишечнику. Слід зазначити, що травлення, яке спостерігається в умовах шлунку під впливом панкреатину тваринного походження, зумовлене нормальним протеолізом, індукованим пепсином, присутнім в аналізі для імітації шлункового соку.
Ці результати вказують на ефективність ПАНЖЕСТ®, який слід використовувати як добавку для перетравлення їжі у людей із порушеннями травлення та/або з екзокринною недостатністю підшлункової залози. Крім того, переважне перетравлення їжі в шлунку забезпечить добре перетравлений хімус дванадцятипалої кишки, що буде запобігати відчуттям розладу шлунку і переповнення шлунку..
Фермент Зовнішня капсула Внутрішня капсула Загалом Ліпаза 3200 FIP 4500 FIP 7700 FIP Амілаза 1720 DU 2250 DU 3970 DU Глюкоамілаза 11,2 AGU 6 AGU 17,2 AGU Альфа-галактозидаза 62,5 GaIU 62,5 GaIU Протеаза 4.5 2496 HUT 500 HUT 2996 HUT Протеаза 3.0 12 SAPU 12 SAPU Протеаза 6.0 1500 HUT 1500 HUT Нейтральна протеаза 1500 PC 1500 PC Примітка
ПАНЖЕСТ® [8]
24 Журнал «Сучасна фармація» • modern-pharmacy.com.ua • 2023 / лютий • У фарватері галузі • Фармакотерапія
Переваги використання мікробних ферментних засобів над тваринними [8]


Мікробні ферменти мають переваги (стабільність
при нагріванні та інактивації шлунковою кислотою) перед травними ферментами тваринного походження. Крім того, мікробні ферменти мають більшу ефективність і стабільність та ширшому діапазон активності рН. Саме це дає можливість обирати конкретні ферменти для впливу на рН шлунку, а інші — на рН кишечника. Ці переваги використовувались для покращення якості життя людей з диспептичними розладами.
Кислотостійка мікробна ліпаза використовувалась у дослідженнях за участі людей, а результати вказують на те, що застосування цих ферментів зменшує відчуття переповнення шлунку після вживання жирної їжі у здорової людини. Крім того, застосування комбінації мікробних ферментів у людей з диспептичними розладами протягом 2 тижнів забезпечило полегшення усіх симптомів функціональної диспепсії (таких як метеоризм, здуття живота, відрижка, диспепсія, відчуття переповнення шлунку, дискомфорт у животі, печія та втрата апетиту). Крім того, прийом травного ферменту альфа-галактозидази зменшує утворення кишкових газів після прийому
їжі з високим вмістом клітковини.
Дослідження на тваринах in vivo та випробування за участі людей підтверджують використання мікробних травних ферментів для коригування недостатності підшлункової залози. Мікробні ферменти є більш потужними та ефективними, ніж панкреатин тваринного походження, завдяки чому менша кількість одиниць мікробних ферментів дозволяє досягти еквівалентних результатів порівняно з панкре-

атичним ферментом тваринного походження. Було встановлено, що збільшення засвоєння жиру та білків під впливом цих мікробних ферментів має значущий вплив на соматичний ріст та ліпідний профіль. Крім того, ці мікробні ферменти оцінювали у клінічних випробувань фази II та III у пацієнтів з екзокринною недостатністю підшлункової залози та муковісцидозом. Для цих досліджень був встановлений період вимивання замісної терапії панкреатичними ферментами, а результати показали, що застосування цих ферментів збільшує засвоєння жиру та білків У ході клінічного випробування за участю 40 пацієнтів з функціональною диспепсією встановлено, що застосування травних ферментів з метою полегшення симптомів диспепсії є ефективним і не викликає побічних ефектів. Ферменті добавки забезпечили ефективне полегшення симптомів порівняно з плацебо, а щоденна доза становила 147 DU амілази, 900 PC нейтральної бактеріальної протеази, 180 FIP ліпази та ін 35. Перевагами складу ПАНЖЕСТ® порівняно є ширший діапазон травних ферментів, більша кількість специфічних ферментів, щоб уникнути надмірного утворення кишкових газів. Крім того, він створений за технологією Cap In Cap (капсула в капсулі), що дозволяє виділяти окремі ферменти для перетравлення в шлунку та кишечнику. До того ж було відзначено подібний корисливий вплив мікробних ферментів на харчування, при цьому 75 % дози припадає на панкреатичний фермент з кишковорозчинним покриттям і 20 % дози на панкреатичний фермент без кишковорозчинного покриття, внаслідок чого для ферментного препарату було потрібно менше мікробного ферменту.
РЕКОМЕНДАЦІЇ ДО ЗАСТОСУВАННЯ ПАНЖЕСТ® [8]
функціональний розлад травлення внаслідок дефіциту чи дисбалансу травних ферментів: такі симптоми, як диспепсія, дискомфорт після їжі, відчуття переповнення в області епігастрію та метеоризм; при захворюваннях, пов’язаних з ендокринною недостатністю підшлункової залози, таких як: муковісцидоз, хронічний панкреатит, хірургічні операції на верхніх відділах шлунково-кишкового тракту.
ПАНЖЕСТ® приймають по 1–2 капсули в день на початку основного прийому їжі.
Фармакотерапія
У фарватері галузі
•
2023 / лютий
•
modern-pharmacy.com.ua

•
Журнал «Сучасна фармація»
• 25
Фармакотерапія
•
У фарватері галузі
•
2023 / лютий
•
modern-pharmacy.com.ua


Зовнішня капсула розпадається після потрапляння в шлунок, а травні ферменти, що вивільняються у шлунку, розщеплюють їжу на менш складні та легко засвоювані поживні речовини. Ці ферменти є активними і стабільними в умовах кислого середовища шлунку. Попереднє перетравлення їжі в шлунку запобігає розвитку розладів шлунку та відчуттю переповнення у шлунку, оскільки до тонкого кишечника доставляється належний добре засвоюваний хімус. Внутрішня капсула виготовлена з рослинного полімеру, що розчиняється у кишечнику. Унікальні властивості полімеру протистоять кислому середовищу шлунку і захищають внутрішню капсулу
від розпаду у цій ділянці. Як результат, усі ферменти внутрішньої капсули потрапляють у тонкий кишечник, де викликають перетравлення їжі замість панкреатичних ферментів. Ферменти внутрішньої капсули підібрані для забезпечення активності у широкому діапазоні рН тонкого кишечника.
Різноманітні ферменти у складі інноваційного
поліферментного комплексу ПАНЖЕСТ® перетравлюють жири, вуглеводи і білки, що містяться у щоденному раціоні людини, сприяють зменшенню газоутворення під час перетравлення їжі.
ПАНЖЕСТ® – ІННОВАЦІЯ:
КАПСУЛА В КАПСУЛІ [8]
Інноваційна система доставки діючих речовин забезпечує активність
ферментів ПАНЖЕСТ® у необхідних ділянках шлунково-кишкового тракту. Мікробні ферменти у складі ПАНЖЕСТ® ретельно підібрані і розподілені у зовнішній капсулі та внутрішній капсулі таким чином, щоб виявляти активність при різних значеннях рН шлунково-кишкового тракту. Отже, система Cap In Cap дозволяє доставляти необхідні ферменти до середовища з оптимальним рН, це робить препарат ефективним
нутрицевтиком.
•
Література
1. Drossman D. Functional gastrointestinal disorders: history, pathophysiology, clinical features, and Rome IV. Gastroenterol. 2016. Vol. 150 (6). P. 1262–1279.


2. Гріднєв О. Є. Сучасні можливості замісної терапії за допомогою травних ферментів мікробного походження. Медична газета « Здоров’я України 21 століття». 2022. № 1 (518). С. 12-16.
ПАНЖЕСТ® — гарне рішення для поліпшення травлення у пацієнтів із функціональною диспепсію за рахунок двох важливих компонентів. По-перше, ПАНЖЕСТ® містить мікробні ферменти, що мають більшу ефективність і стабільність та ширший діапазон активності рН, а це надає змогу обирати одні ферменти для рН шлунку, інші — для рН кишечника. По-друге, нова технологія «капсула в капсулі» дає можливість доставляти мікробні ферменти за певних значень рН, зокрема у шлунку або кишечнику, щоб гарантувати травлення в шлунково-кишковому тракті. Журнал «Сучасна фармація»
3. Палій І. Г. Функціональна диспепсія: сучасні уявлення про механізми виникнення й тактику ведення пацієнтів. Практикуючий лікар. 2013. № 3. С. 25-30.
4. Oshima T. Genetic factors for functional dyspepsia. J. Gastroenterol. Hepatol. 2011. Vol. 26(3). P. 83-87.

5. Маев И. В., Дичева Д. Т., Щегланова М. П. и др. Функциональная диспепсия в свете Римских критериев IV пересмотра (2016 г.). Гастроэнтерология. Приложение к журналу Consilium Medicum. 2016. № 2. С. 5-10.
6. Шманько В.В., Мерецька І. Клініко-фармакологічні аспекти застосування ферментних препаратів у гастроентерології. Ліки України. 2008. № 3 (119). С. 82-84.
7. Тяжка О. В., Джуринська О. М., Товмаш Р. М. Раціональне застосування ферментних препаратів у дітей. Медицина залізничного транспорту України. 2004. № 2. С. 74-80.
8. Інструкція до застосування ПАНЖЕСТ® - https://farmak.ua/ru/ drugs/panzhest/ 26



ЯК ЗБЕРЕГТИ ТА
АКТИВіЗУВАТИ
ЖИТТЄВі РЕСУРСИ
В УМОВАХ ВіЙНИ?
AЛюбов ПЛЯКА, кандидат психологічних наук, практичний психолог вищої категорії, Національний фармацевтичний університет
Війна є надзвичайним психологічним подразником для людини та суспільства. Сьогодні важко залишатись продуктивним і знаходити сили для роботи, продовження навчання, волонтерства, коли
наша країна у війні і ми всі переживаємо втрати щодня. Страх за сьогодні та нерозуміння майбутнього заганяють у ті кути думок, у яких ми раніше не бували.
Все частіше можна помітити, як оптимізм
змінюється розпачем, радість — страхом, а

піднесення — панікою. Виникає психологіч-

на втома, основними ознаками якої є:
почуття знесилення, коли людина відчуває, що не в змозі належним чином продовжувати роботу;
зниження здатності концентрувати увагу;
втрата глибини і критичності мислення;
страхи, тривожність, негативні думки;
погіршення сну;

часті хвороби або хворобливі стани, як-от біль у м’язах, головний біль, проблеми з травленням


порушення харчування — емоційне переїдання або недоїдання

тощо.
Сьогодні вона може виникати від
того, що ми просто втомилися від війни, втомилися від негативних новин, сирен, які лунають щодня, від труднощів і болю, яких завдала війна, від того, що рідні в небезпеці чи на війні. Ми не маємо природного імунітету, здатного захистити від стресу, що спричиняють бойові дії. Проте постійний стрес негативно впливає на продуктивність, пам’ять та прийняття рішень, нам стає важко зосереджуватись на конкретних завданнях. Це абсолютна нормальна реакція для реалій, у яких ми опинилися. Втім ми можемо активізувати життєві ресурси, зберегти фізичне здоров’я та душевну рівновагу.
Що ж таке ресурси людини?
Ресурси людини — це комплекс особистісних властивостей, потенціал та сила, які дозволяють людині зберігати відчуття впевненості та щастя, забезпечувати свої основні потреби: безпеку, виживання, фізичний комфорт, залученість в соціум та самореалізацію. Це такі своєрідні запаси, якими ми можемо скористатися у потрібний для нас час. Особистісний ресурс є в кожного і кожному він потрібен, бо як і будь-який заряд, він з часом має здатність виснажуватись.
Всі ресурси поділяють на внутрішні та зовнішні, що допомагають людині жити продуктивно й ефективно. Звичайно, що цей поділ умовний. Внутрішні ресурси — це потенціал особистості та її особливості, фізичне здоров’я, характер, цінності, самооцінка, стресостійкість, знання людини і багато іншого, що забезпечує здатність особистості відновлюватись при втраті зовнішніх ресурсів. Це те, наскільки добре, впевнено і цілісно людина може відчувати себе без будь-якої підтримки соціуму, чітко усвідомлюючи реальний стан справ, але витримуючи стрес і зберігаючи себе. На одних внутрішніх ресурсах людина довго існувати не може, вона повинна знайти відповідне середовище і вступити з ним у взаємообмін, забезпечувати з його допомогою всі свої потреби, від нижчих до вищих, інакше через якийсь час внутрішній потенціал буде вичерпано.
Зовнішні ресурси — це енергія, яку ми черпаємо ззовні та, здатні за допомогою неї відновитися: матеріальні цінності, соціальні статуси (ролі) і соціальні зв’язки, заняття танцями, спорт, музика, спогад тощо. Надійні зовнішні ресурси забезпечують збереження внутрішніх ре-
28 Журнал «Сучасна фармація» • modern-pharmacy.com.ua • 2023 / лютий • У фарватері галузі • Поради психолога
сурсів, але тільки в тому випадку, якщо ці внутрішні ресурси вже є. Ті та інші ресурси тісно пов’язані і при втраті зовнішніх ресурсів поступово відбувається втрата ресурсів внутрішніх.
Мозок сприймає війну як стихійне лихо. Ресурсний стан допомагає нам, особливо зараз у стані постійних стресів, тривог та втоми не вигоріти, а дати сили та розуміння як жити далі і в якому напрямку рухатися. Тому важливим є вчитися раціонально розподіляти свій ресурс та шукати джерела наповнення.
ЗВІДКИ ЧЕРПАТИ РЕСУРС?
Згадайте свої цінності. Де б ми не були, які б зміни в нашому житті не відбувались, ми завжди можемо спиратися на наші цінності: свобода, здоров`я, турбота про рідних, саморозвиток, доброта, допомога іншим тощо. Цінності — це комплекс. Напишіть, що для вас є важливим та цінним в житті. Те, що раніше вважалося важливим, втрачає свою привабливість
і з точки зору сьогодення бачиться нікчемним. І знайдіть спосіб діяти зараз, де б ви не були, з тими обставинами, що є.

Слідкуйте за здоровим харчуванням.
Саме через їжу людина поповнює свої енергетичні запаси. Чи помічали ви коли-небудь, що після того, як поїли щось конкретне, настрій різко покращується? Правильне харчування — одне з найважливіших знарядь боротьби з енергетичними втратами. Збалансуйте свій раціон харчування, щоб в ньому було більше свіжих фруктів і овочів. Вони є джерелами корисних мінералів і вітамінів, які поповнюють ваш запас енергії. У достатній кількості варто пити воду, соки й молоко Здорове харчування дозволяє зберегти ресурс для подальших дій.


Намагайтеся багато рухатися. Будьяка фізична активність: зарядка, біг, плавання, катання на велосипеді принесе заряд бадьорості та позитивних емоцій. Не любите спортом займатися — танцюйте під улюблену музику. З’являться гормони радості, пришвидшаться обмінні процеси. Головне, щоб такі заняття були регулярними.
Енергія сну. Сон — це відпочинок, потужне джерело енергії.
Виділяйте на нього 7-9 годин. Новітні дослідження сну довели, що міні-сон в обід (від 10 до 30 хвилин) за цінністю відповідає двом годинам нічного сну. Тож якщо є можли-

вість, подрімайте вдень і почувайтеся сильними. У зонах активних бойових дій та в разі надзвичайних ситуацій краще недоспати й піти в укриття, а потім доспати вдень. Краще менше, але якісно. Якщо ви живете не самі, зробіть позмінне чергування сну. Це не ідеальний варіант, проте кращий, ніж не спати взагалі. Правила здорового сну: щоденні прогулянки, гігієнічні процедури, облаштуйте зручне спальне місце, прохолодна і темна кімната, для поліпшення якості сну намагайтесь лягати і прокидатися в один і той же час, не їжте перед сном.
Якісний сон = спокійний. Ви в безпеці, але не можете спати через тривогу? Спробуйте медитувати, протестуйте спеціальні дихальні практики. Це дасть змогу перетягнути увагу від стресових думок до простих речей. Якщо такі техніки не допомагають, проконсультуйтесь із лікарем та психологом щодо доцільності приймання заспокійливих.
Армія США використовує спеціальну техніку, яка дозволяє людині заснути у складних ситуаціях. Її вперше описав Бад Вінтер у книзі «Розслабся та виграй» у 1981 році. Секрет полягає у повному розслабленні м’язів та «очищенні думок». Варто починати із повного розслаблення м’язів обличчя, включаючи язик і щелепу. Потім слід опустити і розслабити плечі, груди, руки, живіт і ноги.
Автор також радить очистити думки, використовуючи один із трьох образів:
ви лежите у човні на спокійному озері і над
вами лиш чисте небо;
ви лежите у чорному оксамитовому гамаку у
темній кімнаті;



ви лежите й повторюєте про себе: «Не думай, не думай, не думай».

Журнал «Сучасна фармація» • modern-pharmacy.com.ua • 2023 / лютий • У фарватері галузі • Поради психолога 29
Попри простоту, згадана методика працює у більшості випадків. Декому знадобиться трішки більше практики, щоб навчитися швидко розслаблятися, втім за кілька тижнів буде відчутний прогрес.
Залишайтеся на зв’язку. При виснаженні зазвичай немає ресурсів на спілкування. Втім ізоляція — не вихід. На самоті ваше відчуття втоми здатне тільки поглиблюватися. Тому не припиняйте проводити час з сім’єю чи друзями.
Зміна діяльності: прибирайте квартиру, готуйте їжу, садіть розсаду тощо. Це дозволяє створити ілюзію контролю над ситуацією та подолати стрес у конкретний момент.
Оберіть хобі для душі. Улюблені та цікаві захоплення наповнюють день радістю і сенсом.



Енергію дарує музика. Давно відомо, що музика може впливати на настрій і деякі процеси людського організму. Музика — це звуки, хвилі, які володіють певними вібраціями. Саме ці вібрації і впливають на людину. Для підйому енергії, в звуки необхідно вслухатися, пропускати їх через себе. Це можна зробити в танці, підспівуючи чи релаксуючи. Тільки в цих випадках музика може творити справжні чудеса!
Позитивне мислення. Позитивне мислення є тією зв’язною ланкою, яка дозволяє об’єднати і використовувати всі інші внутрішні ресурси людини. При такому типі мислення переважають зосередження особистості: на чеснотах, а не на недоліках; на успіхи, життєві уроки, а не на помилки і невезіння; на можливостях, а не на перешкоди. Людина з позитивним мисленям добре підготовлена до життєвих випробувань, впевнено дивиться у майбутнє. Якщо ви не вірите в успішне вирішення проблеми, то ви підсвідомо відмовляєтеся використовувати всі свої вроджені механізми та набуті знання. Позитивне мислення пов’язане зі здатністю підтримувати в собі надію і зацікавленість, що б не сталося.

Не соромтеся звернутися за допомогою. Якщо ви розумієте, що самостійно вирівняти емоційний стан не вдається, зверніться до психолога чи психотерапевта. Разом ви зможете визначити такі інструменти боротьби із психологічною втомою, які найбільше підходять саме для вас. Професійний психолог допоможе знайти та впровадити ті невеликі зміни у звичних речах, які сприятимуть покращенню Вашого емоційного стану.
і
зовнішньому. Якщо не відновлювати сили, встигатимете менше і знизиться рівень якості життя. Тому робіть те, що хочете і можете.

30 Журнал «Сучасна фармація» • modern-pharmacy.com.ua • 2023 / лютий • У фарватері галузі • Поради психолога
Бережіть себе, турбуйтеся про здоров’я
свій внутрішній світ, щоб мати змогу допомогти
НЕОВІТАМ®

надійний помічник
у боротьбі з
ÕÐÎÍI×ÍÈÌ ÁÎËÅÌ
Еволюційно біль призначений для того, щоб ми взаємодіяли з навколишнім світом і не
завдавали собі шкоди. Саме завдяки цьому ми уникаємо травм, боїмося диких звірів та вчасно звертаємося до лікаря. На жаль, біль не завжди виконує захисну функцію. При ряді захворювань
він може тривати безперервно і порушувати якість життя хворого.
Дослідження показали, що жінки відчувають біль сильніше, ніж чоловіки [1].
Надія Бойко, лікар-невролог
ЯКИМ БУВАЄ БІЛЬ?
Виділяють наступні види болю [2]:
1. Ноцицептивний біль, який виникає у відповідь на прямий вплив зовнішнього подразника і відіграє захисну роль. Саме цей вид болю виникає при ударах, порізах та опіках.
2. Запальний біль, який виникає після операцій, травм та інших захворювань, зумовлений активацією імунної системи в результаті пошкодження тканин або інфекцій. Цей біль спрямований на забезпечення спокою хворого органу, що знижує подальший ризик пошкодження і сприяє одужанню.
3. Патологічний біль, який не має ніякої захисної функції і викликаний порушеннями з боку нервової системи. Його поділяють на:
дисфункціональний, при якому нерви не пошко-
джені, проте існує аномально висока чутливість
до болю, наприклад, при фіброміалгії і синдромі
подразненого кишечнику;

нейропатичний, який виникає через пошкодження або запалення нервів.
!Хронічний біль турбує щонайменше
1 з 10 людей у світі, хоча у деяких країнах ця цифра у 2–2,5 рази вища [3].


Які захворювання найчастіше викликають

патологічний біль?
Біль є симптомом цілого ряду захворювань. Так, запалення чи травма будь-якого органу супроводжується гострим болем. Серед причин хронічного болю найбільша частка припадає на біль, викликаний захворюваннями кістково-м’язової та нервової систем, які тісно пов’язані між собою.
Хронічний нейропатичний біль — досить часте явище, його поширеність коливається від
7 до 10 % від загальної чисельності населення
[4, 5]. Біль, який часто викликає тяжкі страждання
і навіть непрацездатність пацієнта, може бути єдиним проявом захворювання, як, наприклад, при постгерпетичній невралгії.
Основними причинами нейропатичного
болю є:
поліневропатії різної етіології (у тому числі діабетична, алкогольна);
гострий та хронічний неврит і невралгія;
ішіас і люмбаго;
корінцевий синдром, спричинений дегенеративними ураженнями хребта;
плексити;
міжреберна невралгія;
невралгія трійчастого нерва.
A
Журнал «Сучасна фармація» • modern-pharmacy.com.ua • 2023 / лютий • У фарватері галузі • Думка фахівця 31
Основна частка тягаря
хвороб кістково-м’язової
та нервової систем припадає на біль у попереку (люмбаго), від якого страждають 568 млн. людей у світі [6].
ЧОМУ НЕ ВАРТО ТЕРПІТИ БІЛЬ?
Гострий біль значно погіршує якість життя, порушує звичний режим роботи, навчання і сну. Якщо біль стає постійним, до цих ускладнень додається підвищений ризик депресій, хронічної втоми, тривожності, зловживання алкоголем і наркотиками та зниження лібідо [7, 8].
ЩО ВПЛИВАЄ НА ФУНКЦІОНУВАННЯ НЕРВОВОЇ СИСТЕМИ ТА РОЗВИТОК НЕЙРОПАТИЧНОГО БОЛЮ?
Наряду з багатьма іншими факторами, нейротропні вітаміни групи В, зокрема, вітамін В1 (тіамін), В6 (піридоксин) і В12 (кобаламін), відіграють важливу роль у роботі нервової системи. Відомо, що дефіцит даних вітамінів пов’язаний з розвитком багатьох неврологічних захворювань. У той самий час результати досліджень показують, що вони покращують перебіг певних неврологічних станів навіть у людей без дефіциту [9].
В1
Роль вітамінів групи В у функціонуванні нервової системи
ТІАМІН (В 1)
Вітамін В1 потрібен для адекватної роботи центральної і периферичної нервової систем.
Критична нестача вітаміну В1 призводить до
хвороби бері-бері або енцефалопатії ВернікеКорсакова. Хвороба бері-бері характеризується
симптомами слабкості, тремору, втрати апетиту та підвищеного ризику раптової смерті і паралічу. Енцефалопатія Верніке-Корсакова протікає у вигляді психозу, який поєднується з втратою пам’яті (амнезією). Випадки критичної нестачі вітаміну В1 описані серед біженців в Східній Азії, що вимушено їли виключно рис [10, 11].
Загалом, тіамін необхідний для багатьох фізіологічних функцій і, крім іншого, бере участь у [12–14]:
метаболізмі глюкози;
підтримці функції нервових оболонок;
синтезі мієліну, ліпідної оболонки нервів, яка за-
ПІРИДОКСИН (В 6)
Вітамін В6 був відкритий в 1934
році і на сьогодні відомо більш ніж 140
функцій цього вітаміна в ролі коен-
зима [16–18]. Важливість піридоксину
у функціонуванні нервової системи
зумовлена його участю в синтезі нейро-



медіаторів, зокрема:
дофаміну з леводопи;
серотоніну з 5-гідрокситриптофану;
гамма-аміномасляної кислоти (ГАМК) з глутамату.
безпечує їхню ізоляцію та швидкість передачі нервових імпульсів; виробленні кількох типів речовин, які потрібні для передачі нервового імпульсу між клітинами (нейромедіаторів), наприклад, ацетилхоліну, серотоніну та амінокислот.
Нейрони використовують глюкозу як джерело енергії і брак вітаміну В1 може призвести до їхньої загибелі. В результаті порушується короткотривала пам’ять і координація рухів.
На сьогодні критичний дефіцит тіаміну практично не виникає. Значно частіше зустрічається субклінічна картина браку вітаміну В1. Її досить важко розпізнати. Основними симптомами є [15]:
збільшення серця і тахікардія;
фіброміалгія, яка характеризується хронічним білем та підвищеною чутливістю шкіри, розладами сну та вираженою втомою;
хронічна втома і «туман в голові»;
поступова втрата м’язової маси;

відсутність апетиту.
Крім того, піридоксин має нейропротекторні властивості, зумовлені його здатністю регулювати глутаматергічну систему і, відповідно, рівні ГАМК і глутамату. Оскільки ГАМК є основним гальмівним нейромедіатором, його дефіцит може призвести до виникнення судом. Те саме відбувається при підвищенні рівня попередника глутамату ГАМК, який є збудливим нейромедіатором. В експериментальних дослідженнях показано, що застосування ГАМК або піридоксину у пацієнтів з судомами може припинити судомну активність [16, 19, 20].
!
Вітамін В6 необхідний для нормального розвитку мозку дитини як під час вагітності, так і після пологів [21].
В6
32 Журнал «Сучасна фармація» • modern-pharmacy.com.ua • 2023 / лютий • У фарватері галузі • Думка фахівця
КОБАЛАМІН (В 12)
Незважаючи на те, що кобаламін став відомий завдяки своєму впливу на кровотворення, він також відіграє важливу роль у процесах підтримки
В12
та відновлення здоров’я нервової системи.
Вітамін В12 незамінний для синтезу ДНК олігодендроцитів, клітин, які виробляють мієлін [22–25]. Утворення і відновлення мієліну потрібне регенерації нервів після травм. Окрім цього, кобаламін бере участь у [9]:
метаболізмі гомоцистеїну;

метаболізмі нервових клітин (процесах трансметилювання);
синтезі жирних і нуклеїнових
кислот;
процесах дозрівання клітин;
підтримці цілісності слизової оболонки шлунково-кишкового тракту.
Слід підкреслити, що вітаміни групи В, швидше за все, відіграють синергічну, тобто взаємодоповнюючу біохімічну роль у функціонуванні нервової системи, тобто жоден з них не може замінити іншого [9]. Саме тому при захворюваннях нервової системи варто використовувати комплексні препарати, які б містили В1, В6 та В12. Одним із таких засобів є НЕОВІТАМ® виробництва "Київського Вітамінного Заводу".
ЧОМУ САМЕ НЕОВІТАМ®?
ЗБАЛАНСОВАНИЙ СКЛАД
1 таблетка НЕОВІТАМу®
містить тіаміну гідрохлориду 100 мг, піридоксину
гідрохлориду 200 мг та вітаміну В12 0,2 мг. Подібна комбінація дозволяє комплексно
впливати на біохімічні процеси в нервах, забезпечуючи їхнє відновлення та
зменшуючи симптоми.
ВИСОКА
ЯКІСТЬ
Процес виробництва НЕОВІТАМу® повністю відповідає вимогам стандартів Належної
виробничої практики (GMP), що по праву робить його препаратом європейської якості.

ПРИВАБЛИВА ЦІНА Доступність лікарського засобу повинна обов’язково враховуватися при виборі ліків. Відносно невисока вартість НЕОВІТАМу® підвищує прихильність
хворих до лікування, а разом з цим і його ефективність.
З РУЧНІСТЬ ДОЗУВАННЯ НЕОВІТАМ® можна приймати в дозі 1 таблетка 1 раз на добу. Це зручно для пацієнта. Відповідно, вірогідність проходження повного курсу лікування вища.
ЕФЕКТИВНІСТЬ ТА БЕЗПЕКА ДОВЕДЕНА РЕЗУЛЬТАТАМИ ДОСЛІДЖЕНЬ
Ефективність та безпека як комбінації, так і окремих компонентів, що входить до складу НЕОВІТАМу®, вивчалася у ряді клінічних досліджень, представлених нижче.
НЕОВІТАМ®: що говорять результати досліджень
Вітамін В1, який входить до складу НЕОВІТАМ®, у клінічній практиці найчастіше застовується в комплексній терапії діабетичної та алкогольної полінейропатії (тіамінова недостатність виникає у кожного четвертого алкоголіка) [26]. Дані полінейропатії характеризуються больовим синдромом. В ряді клінічних досліджень вивчався вплив тіаміну на вираженість болю. Аналіз 13 клінічних досліджень ефективності та безпеки тіаміну при алкогольній та/або діабетичній полінейропатії за участі 741 пацієнта виявив, що високі дози тіаміну забезпечують короткочасне зменшення вираженості болю і парестезій (відчуття поколювання або повзання мурашок), а також покращують температурну та вібраційну чутливість [27].
Думка фахівця
У фарватері галузі
•
2023 / лютий
modern-pharmacy.com.ua



•
Журнал «Сучасна фармація»
• 33
•
2023
modern-pharmacy.com.ua







Ще одна складова НЕОВІТАМу®, вітамін В6 , є доведено ефективним у лікуванні тунельних синдромів. Так, в дослідженні за участі 994 пацієнтів із синдромом зап’ясного каналу показано, що базове лікування з додатковим призначенням вітаміну В6 зменшує вираженість симптомів у 68 % хворих, а аналогічне лікування без піридоксину — у 14,3 % пацієнтів [28]. Ще 8 робіт підтверджують аналогічне покращення симптоматики та електрофізіологічних показників на фоні терапії синдрому зап’ясного каналу вітаміном В6. Дані результати можуть бути пов’язані як із прихованим дефіцитом вітаміну, так як при його дефіциті можуть з’явитися парестезії та оніміння в кистях, так і з його знеболюючими властивостями [29].
Останній компонент НЕОВІТАМу®
ціанкобаламін (В12) — вітамін, якому
присвячено більше 90 досліджень, спрямованих на оцінку його ефективності у зменшенні вираженості больового синдрому. В одному з них ефективність В12
у пацієнтів із діабетичною нейропатією
порівнювалася з дією нортриптиліну і
виявилася вищою останнього. Крім того, відзначалося достовірне зменшення відчуття печіння, мерзлякуватості і парестезій [30]. У експериментальних дослідженнях показано, що вітамін В12 відіграє ключову роль в регенерації нервових волокон, що пов’язано з відновленням мієлінової оболонки і поліпшенням
провідності. Ця особливість вітаміну В12 активно використовується в клінічній практиці для лікування нейропатичних синдромів. Велике рандомізоване клінічне дослідження за участі пацієнтів з хронічним болем в спині продемонструвало зниження інтенсивності больового синдрому та покращення рухових функцій на фоні введення В12 [31].
Ще одне плацебо-контрольоване дослідження, проведене в 2011 році, підтверджує ефективність та безпеку застосування В12 при болях у хребті, причому автори відзначають, що В12 діє на різні види болю — ноцицептивний та нейропатичний [32].
У дослідженні Eckert та співавторів оцінювали ефективність аналогічного НЕОВІТАМу® комплексу вітамінів групи В (піридоксин, тіамін, ціанокобаламін) при лікуванні 1149 пацієнтів з больовими синдромами та парестезіями, обумовленими поліневропатіями, невралгіями, радикулопатіями, мононевропатіями протягом 3 тижнів. В результати дослідниками було відмічено значне зменшення інтенсивності болю [33].
В огляді робіт з вивчення знеболюючої дії комплексу вітамінів В (В1, В6, В12) I. Jurna, проаналізувавши доступні результати експериментальних та клінічних досліджень, дійшов до висновку, що їхнє застосування здатне зменшити як скелетно-м’язові, так і корінцеві болі в спині. Особливо була відзначена ефективність комплексу вітамінів групи В у комбінації з нестероїдними протизапальними препаратами (НПЗП) [34].

Таким чином, експериментальні та клінічні дослідження дії вітамінів групи В при ноцицептивних та невропатичних болях дозволяють вважати, що окремі вітаміни цієї групи (В1, В6, В12) та комплексні препарати вітамінів групи В мають виражений знеболюючий ефект.
Як та коли приймати НЕОВІТАМ®?
НЕОВІТАМ® застосовують
для лікування захворювань нервової системи, зокрема:
поліневропатій різної етіології (у тому числі діабетичної, алкогольної);
гострого та хронічного неврита
та невралгії;
ішіаса і люмбаго;
корінцевого синдрому, спричи-
неного дегенеративними ураженнями хребта;
плекситах;
міжреберній невралгії;
парезі лицьового нерва;
невралгії трійчастого нерва.
НЕОВІТАМ® можна застосовувати дорослим і дітям віком від 3 років.
Рекомендоване дозування:
дітям віком 3–7 років 1 таблетка на добу;
віком 8–14 років — від 1 до 3 таблеток на добу;
дорослим та дітям віком від 14 років від 1 до 4 таблеток на добу.
Рекомендований курс лікування — 2–4 тижні.
Жоден з процесів життєдіяльності людини не проходить без вітамінів і мінералів. А вітаміни групи В, які входять до складу НЕОВІТАМ® — це основа здоров’я нервової системи та надійний помічник у боротьбі з болем.
34
Журнал «Сучасна фармація» •
фахівця
•
/ лютий • У фарватері галузі • Думка
Відвідувач просить порадити вітаміни групи В.
Рекомендуйте НЕОВІТАМ®. Його збалансований склад ліквідує дефіцит вітамінів групи В та підтримає здоров’я нервової системи.
Додатково
до основних
засобів рекомендуйте НЕОВІТАМ®.
Він ліквідує дефіцит вітамінів групи В, зменшить
біль та прискорить
відновлення нервової системи.
Відвідувач
просить
порадити вітаміни для підтримки нервової системи.
Список літератури
Відвідувач просить порадити
засіб, який би допоміг при зниженій працездатності пам’яті та втомі.
1. Ellermeier W., Westphal W. Gender di erences in pain ratings and pupil reactions to painful pressure stimuli. Pain. 1995;61(3): Р 435–439.
2. What is this thing called pain?. e Journal of clinical investigation, 120(11), 3742–3744.
3. Tracy P. Jackson, Victoria Sutton Stabile, K.A. Kelly McQueen; e Global Burden Of Chronic Pain. ASA Newsletter 2014; 78: Р 24–27
4. van Hecke O, Austin SK, Khan RA, Smith BH, Torrance N. Neuropathic pain in the general population: a systematic review of epidemiological studies. Pain. 2014;155(4): Р 654–662.
5. Nahin RL. Estimates of pain prevalence and severity in adults: United States, 2012. J Pain. 2015;16(8): Р 76–80.
6. ВОЗ. Заболевания опорно-двигательного аппарата. URL: https://www. who.int/ru/news-room/fact-sheets/detail/musculoskeletal-conditions (дата звернення — 4.11.2021)
7. Gan T. J. (2017). Poorly controlled postoperative pain: prevalence, consequences, and prevention. Journal of pain research, 10, Р 2287–2298.
8. Manish K. Singh, Stephen Kishner. What complications are associated with chronic pain syndrome (CPS)? URL: https://www.medscape.com/ answers/310834-18936/what-complications-are-associated-with-chronicpain-syndrome-cps (дата звернення 4.11.2021)
9. Calderón-Ospina CA, Nava-Mesa MO. B Vitamins in the nervous system: Current knowledge of the biochemical modes of action and synergies of thiamine, pyridoxine, and cobalamin. CNS Neurosci er. 2020;26(1): Р 5–13.
10. Zempleni J, Suttie JW, Gregory JF III, Stover PJ. Handbook of Vitamins. Boca Raton, Florida, USA: CRC Press; 2013.
11. Isenberg‐Grzeda E, Kutner HE, Nicolson SE. Wernicke‐Korsako ‐syndrome: under‐recognized and under‐treated. Psychosomatics. 2012;53(6): Р 507‐516.
12. World Health Organization. iamine De ciency and its Prevention and Control in Major Emergencies. Geneva, Switzerland: World Health Organization; 1999.
13. Expert Group on Vitamins and Minerals . Covering Note for EVM 00/14/P‐Review of iamin; 2000.
14. Martin P. Molecular mechanisms of thiamine utilization. Curr Mol Med. 2001;1(2): Р 197‐207.
15. МОЗ України. Що треба знати про тіамін — вітамін В1. URL: https:// moz.gov.ua/article/health/scho-treba-znati-pro-tiamin---vitamin-v1 (дата звернення: 04.11.2021)
16. Zempleni J, Suttie JW, Gregory JF III, Stover PJ. Handbook of Vitamins. Boca Raton, Florida, USA: CRC Press; 2013.
17. Parra M, Stahl S, Hellmann H. Vitamin B6 and its role in cell metabolism and physiology. Cells. 2018;7(7): Р 84.
Відвідувач
купує НПЗП
від болю в спині.
Відвідувач
страждає від
хронічного болю
і часто купує знеболюючі засоби.
18. Bernstein AL. Vitamin B6 in clinical neurology. Ann N Y Acad Sci. 1990;585(1): Р 250‐260.

19. Bender DA. B vitamins in the nervous system In: Osborne NN, eds. Selected Topics from Neurochemistry. Amsterdam, Netherlands: Elsevier; 1985: Р 397‐423.
20. Spinneker A, Sola R, Lemmen V, Castillo M, Pietrzik K, Gonzalez‐Gross M. Vitamin B6 status, de ciency and its consequences‐an overview. Nutr Hosp. 2007;22(1): Р 7‐24.
21. Stephens M, Havlicek V, Dakshinamurti K. Pyridoxine de ciency and development of the central nervous system in the rat. J Neurochem. 1971;18(12):2407‐2416.

22. Herrmann W, Obeid R. Causes and early diagnosis of vitamin B12 de ciency. Dtsch Ärztebl Int. 2008;105(40): Р 680‐685.
23. Kumar N. Neurologic aspects of cobalamin (B12) de ciency In: Biller J, Ferro JM, eds. Handbook of Clinical Neurology Vol 120 Amsterdam, Netherlands: Elsevier; 2014: Р 915‐926.
24. Adamo AM. Nutritional factors and aging in demyelinating diseases. Genes Nutr. 2014;9(1):360.
25. Briani C, Dalla Torre C, Citton V, et al. Cobalamin de ciency: clinical picture and radiological ndings. Nutrients. 2013;5(11): Р 4521‐4539.
26. Gibson GE, Blass JP. iamine-dependent processes and treatment strategies in neurodegeneration. Antioxid Redox Signal 2007; 9: 1605–10
27. Ang CD, Al viar MJ, Dans AL et al. Vitamin B for treating peripheral neuropathy. Cochrane Database Syst Rev 2008; 3: CD004573

28. Kasdan M, Janes C. Carpal tunnel syndrome and vitamin B6. Plast Reconstr Surg 1987; 79: 456–8

29. Au ero E, Stitik T, Foye M et al. Piridoxine hydrochloride treatment of carpal tunnel syndrome: a review. Nutr Rev 2004; 3: 96–104

30. Talaei A, Siavash M, Majidi H et al. Vitamin B12 may be more e ective than nortriptyline in improving painful diabetic neuropathy. Int J Food Sci Nutr 2009; 60 (Suppl. 5): 71–6.
31. Mauro GL, Martorana U, Cataldo P et al. Vitamin B12 in low back pain: a randomised, double-blind, placebo-controlled study. Eur Rev Med Pharmacol Sci 2000; 4 (3): 53–8.
32. Chiu CK, Low TH, Tey YS et al. e e cacy and safety of intramuscular injections of methylcobalamin in patients with chronic nonspeci c low back pain: a randomised controlled trial. Singapore Med J 2011; 52 (12): 868–73

33. Eckert M., Schejbal P. erapy of neuropathies with a vitamin B combination. Symptomatic treatment of painful diseases of the peripheral nervous system with a combination preparation of thiamine, pyridoxine and cyanocobalamin// Fortschr Med. 1992; 110: 29: 544–548
34. Jurna I. Analgetic and analgesia-potentiating action of B vitamins // Schmerz. 1998; 12: 2: 136–141
КОЛИ
ВАРТО РЕКОМЕНДУВАТИ НЕОВІТАМ®: ФАРМАЦЕВТИЧНИЙ АЛГОРИТМ
Журнал «Сучасна фармація» • modern-pharmacy.com.ua • 2023 / лютий • У фарватері галузі • Думка фахівця 35
АПТЕЧНА МЕРЕЖА 9-1-1:

Під опікою


не тільки люди, а й тварини
Війна зламала наше життя, але не зламала нас. «Якщо ти людина, то маєш піклуватися про тих, кому зараз найскладніше і хто не може подбати про себе», — під таким девізом вже рік живе і працює Аптечна мережа 9-1-1. У зоні її особливої уваги люди і тварини звільненої Харківщини.
Колаборація фармації та ветеринарії


Місцеві жителі, які не залишили свої домівки навіть під час війни, розповідають, що коти відчувають ракетний обстріл за добу до того, як він станеться. Пухнастики намагаються попередити своїх власників будь-яким способом. Одні починають нявкати, інші тягнуть у коридор чи льох, але жоден не біжить рятуватися сам, забуваючи про людину, яка його годує та доглядає.

На жаль, люди не завжди згадують про братів своїх менших, коли виникає небезпека. Дитина, старенькі батьки, речі на місті?
Поїхали! Так в містах і селах, які зазнали обстрілів та окупації, безхатьками стали сотні тварин. Вчора вони ще мали дах над головою, а сьогодні залишились наодинці з війною, голодом і хворобами, які чатують на них на вулиці.

Часто таких чотирилапих
безхатьків прихищають сусіди, в яких повна хата своїх пухнастих «діточок», але кинути бідолаху напризволяще не дозволяє совість. Коли наші воїни заходили у звільнені села і містечка, вони бачили бабусь та дідусів, які зустрічали визволителів разом зі своїм численним прайдом. І старенькі просили їжу не для себе, а для своїх вихованців.


Працівники Аптечної мережі 9-1-1 першими, як тільки дозволяли обставини, приїжджали розбитими дорогами з пакунками ліків і продуктами для жителів звільненої Харківщини. І теж бачили сльози і простягнуті за допомогою руки, які тут же ділили навпіл пиріжок чи печиво і годували своїх Шариків та Мурок.
Залишатися байдужими вони не могли, тому вирішили взяти під опіку людей і тварин, які пережили страшні часи. Так народилася ідея колаборації Аптечної мережі 9-1- і компанії ProVET.

36 Журнал «Сучасна фармація» •
• 2023 / лютий • У фарватері галузі • Добрі справи
modern-pharmacy.com.ua
Аптека, де лікують тварин
В Аптеці 9-1-1 у звільнених Липцях, що першою відновила свою роботу в цьому населеному пункті, 17 лютого провели благодійну акцію для власників тварин. Працівники компанії ProVET у приміщенні аптеки роздали місцевим жителям, які опікуються своїми та покинутими кішками і собаками, антигельмінтні, інсектоакарицидні препарати, а також ліки проти екто- та ендопаразитів і вітамінно-мінеральні комплекси «Профілайн».


Кожний власник тварин отримав докладну консультацію від ветеринарів щодо застосування цих засобів, можливих алергічних реакцій та необхідної допомоги у разі виникнення проблем зі здоров’ям їхніх улюбленців. Пухнастики, які вижили завдяки турботі небайдужих сільчан, і своєю чергою стали для них психологічною підтримкою у страшні часи окупації, тепер зможуть пройти необхідне лікування й отримати профілактику, щоб не наражати на небезпеку людей, які їх оточують.
Пожежна частина — рідний дім
Липці потрапили під окупацію у перший день повномасштабного вторгнення. З майже 14 тисяч мешканців залишилося менше тисячі. Без світла, тепла і води люди намагалися вижити під обстрілами, що нищили домівки, магазини, лікарню та школу.
Коли відбувався черговий прильот ворожої ракети чи снаряд потрапляв в будинок, виникала пожежа, яка руйнувала все. На допомогу прибували рятувальники. І часто знаходили поруч з руїнами наляканих собак та кішок. Вони забирали їх у свою пожежно-рятувальну частину, яка перетворилася для пухнастиків на домівку. Вогнеборці опікувалися своїми чотирилапими «колегами», а ті проводжали і зустрічали їх після небезпечного чергування.




Тож не дивно, що після благодійної акції в аптеці працівники Аптечної мережі 9-1-1 та ветеринари з ProVET відвідали пожежно-рятувальну частину в с. Липці. Тут на них чекали мужні рятувальники зі своїми не менш мужніми «вихованцями».
Корм, тарілочки для годування, будиночки, матрацики і навіть дряпки для кігтів — ветеринари знають потреби своєї «цільової аудиторії»! Але найбільшу цінність, безумовно, являли ліки та профілактичні засоби від різних захворювань, зокрема вітаміни.

Аптечна мережа 9-1-1 з перших днів повномасштабного вторгнення опікувалася харків’янами. Тоді «передачі» з ліками для дорослих і дітей, а також кормом для котиків і песиків привозили в харківське метро, де люди рятувалися від масованих обстрілів.
Згодом їжу та ліки для тварин представники мережі розвозили по різних районах міста та в передмістя. Їх роздавали власникам пухнастиків, годували котиків і песиків, що жили в підвалах та на вулиці.

У фарватері галузі
•
2023 / лютий
•
modern-pharmacy.com.ua

Історія добрих справ продовжується! •
• Добрі справи 37
Коли звільнили Харківську область, туди насамперед доставили лікарські засоби для людей і корм для чотирилапих. В Аптечної мережі 9-1-1 знайшлися надійні помічники-ветеринари, і «фармопіка» набула нового сенсу і нових форм. Завдяки цій колаборації в історії добрих справ з’явиться ще багато нових сторінок. Ми ж люди, отже, хто як не ми має опікуватися тваринами? Журнал «Сучасна фармація»
c.40
Пробіз® Імуно — природній захист організму
c.48 Стифімол Плюс покращує метаболічні процеси
c.54 Як підтримати імунітет дитини в період застуди?
c.60
В Україні удосконалюють систему післядипломної освіти та безперервного професійного розвитку фармацевтичних та медичних фахівців
Summum bonum medicīnae sanĭtas Найвище благо медицини – здоров’я











ЗНАНЬ
АРСЕНАЛ ЗНАНЬ АРСЕНАЛ

ПРОБІЗ® ІМУНО
природній захист
організму

Прості істоти зустрічаються частіше, ніж складні організми. На Землі живуть мільярди людей, і ми вважаємо, що це дуже багато, поки ми не згадаємо, що звичайна колба може вмістити бактерій в десять і навіть в сто разів більше. Майкл Крайтон
Катерина Лугова, аспірантка відділення кардіоревматології Державної установи «Інститут охорони здоров’я дітей та підлітків Національної академії медичних наук України»

Наш організм — окремий всесвіт. В ньому поєднується сила та здатність до боротьби у різних умовах. Колись ми перемогли натуральну віспу, вперше зустрілися з вірусами SARS та MERS, а зараз вчимося жити в нових умовах, які диктує нам пандемія COVID-19. Постійне протистояння інфекційним захворюванням, боротьба за виживання з вірусами і бактеріями — все це невпинно говорить про те, що актуальність цих форм життя лише росте. Вони маскуються, стають резистентними до ліків, мутують та кожного разу забирають сотні та мільйони життів. Наша захисна зброя проти агресивних форм життя — імунітет.
Наприкінці ХХ-го — початку ХХІ століття з’явилися сотні кінофільмів та серіалів виробництва США, Великобританії та деяких інших країн, які попереджали людство про небезпеку виникнення смертельної пандемії, викликаної невідомим вірусом. На жаль, ці пророцтва збулися в 2019–2020 рр., коли світом поширилася пандемія нової, ще небаченої вірусної інфекції COVID-19, збудником якої став коронавірус SARS-CoV-2. Дуже швидко пандемія охопила майже
всі країни світу. Станом на початок лютого 2023 р. у світі захворіло більше 675 мільйонів, а померло майже 7 мільйонів людей. Але і досі ми маємо стосовно нього мало інформації, протоколи діагностики та лікування ще недосконалі, а а жодна сучасних вакцин не надає надійного захисту.

ЦЕ ЦІКАВО!
Імунітет — це складна система захисних реакцій організму, які направлені на підтримання сталості організму та забезпеченні його адаптації до умов довкілля, що постійно змінюються.
Дивлячись на умови, в яких нам зараз необхідно жити, ще більшої актуальності набуває підтримка імунітету на найвищому рівні. Досягти цього можливо лише за умови дотримання загальноприйнятих догм: фізична активність, свіже повітря, загартовування і найголовніше — підтримання балансу мікрота макронутрієнтів, вітамінів, а також корекція дисбіотичних порушень.
Оптимальний нутрітивний статус є запорукою злагодженої роботи як імунітету, так і організму в цілому. Не менш важливий регуляторний вплив на імунну систему має нормальна мікрофлора кишківника.
Враховуючи сучасні особливості харчування, швидкий темп життя, економічні труднощі, постійне емоційне перевантаження, люди все частіше відчувають на собі послаблення імунного захисту. Таким чином, одним з раціональних варіантів вирішення цієї проблеми є використання дієтичних добавок. Проте слід обов’язково враховувати кількісний та якісний склад будь-якого вибраного засобу.
40 Журнал «Сучасна фармація» • modern-pharmacy.com.ua • 2023 / лютий • Арсенал знань • Професійний конкурс
A
Бактерія Вacillus coagulans під мікроскопом
BACILLUS COAGULANS

сприяє перетравлюванню лактози;
має протизапальну і
антиоксидантну активність;
володіє гіпохолестеринемічною дією
У ФОРМІ СПОР
добре переносить всі технологічні
процеси, тривале зберігання і заморожування;
зберігає активність під впливом шлункового соку, жовчі і антибактеріальних препаратів.
ПРОБІОТИКИ ТА ІМУНІТЕТ
Пробіотики, згідно з визначенням Всесвітньої організації охорони здоров’я (ВООЗ), — це живі мікроорганізми, застосування яких в адекватних кількостях покращує здоров’я організму господаря [1].
Одним із найбільш перспективних пробіотичних мікроорганізмів є спороутворююча лактобактерія Bacillus coagulans. Так, наприклад, Bacillus coagulans володіє доведеною імуностимулюючою дією [3]. Неодноразово досліджувалася терапевтична дія Bacillus coagulans при синдромі роздратованого кишківника [4] та функціональних закрепах [5]. Зважаючи на це, на її основі вже зараз представлена низка лікарських засобів та дієтичних добавок з клінічно доведеною ефективністю [2].
ЦЕ ЦІКАВО!
Спори Bacillus coagulans, вперше в якості пробіотика були виділені в 1915 році в США вченим B. W. Hammer і задепоновані в американській колекції клітинних культур.



Вacillus coagulans — це грампозитивна ендоспороутворююча, рухлива, непатогенна, нетоксигенна бактерія. У формі спор вона, на відміну від більшості інших пробіотиків, які не мають вегетативної спорової форми (а це, як мінімум, усі лакто- та біфідобактерії) добре переносить всі технологічні процеси, тривале зберігання і навіть заморожування, зберігає свою активність під впливом шлункового соку, жовчі і антибактеріальних препаратів [6–9]. Bacillus coagulans
сприяє перетравлюванню лактози, чинить протизапальну і антиоксидантну активність, а також володіє гіпохолестеринемічною дією.
Комплексом, що має в своєму складі вищезазначений пробіотик, є ПРОБІЗ® ІМУНО компанії ORGANOSYN. Також цей засіб містить 9 рослинних компонентів, полівітамінний та мінеральний комплекс, що робить цю композицію незамінною на фармацевтичному ринку, адже, незважаючи на багатий склад, комплекс є цілком натуральним та безпечним, а кожна складова потенціює та синергізує загальний корисний ефект.
ВІТАМІНИ У СКЛАДІ ПРОБІЗ® ІМУНО

Вітаміни — група незамінних для організму людини і тварин органічних сполук, які мають високу біологічну активність, наявні в малих кількостях у продуктах харчування. Основна їх кількість надходить в організм з їжею і лише деякі синтезуються мікроорганізмами в кишечнику. Вітаміни є обов’язковими компонентами ферментних систем і гормонів, вони забезпечують нормальне функціонування нервової системи, м’язів та інших органів. Від рівня вітамінної забезпеченості харчування залежить рівень розумо-
вої і фізичної дієздатності, витривалості й опірності організму.
Вітамін C бере участь в окисно-відновних процесах, регуляції вуглеводного обміну, впливає на обмін амінокислот, метаболізм тироксину, біосинтез катехоламінів, стероїдних гормонів та інсуліну; необхідний для забезпечення нормального згортання крові, синтезу колагену та проколагену, регенерації сполучної та кісткової тканин. Нормалізує проникність капілярів. Сприяє абсорбції заліза в кишечнику та бере участь

Журнал «Сучасна фармація» • modern-pharmacy.com.ua • 2023 / лютий • Арсенал знань • Професійний конкурс 41
у синтезі гемоглобіну. Підвищує неспецифічну резистентність організму, має антиоксидантні властивості. Для дорослої людини добова потреба у вітаміні С становить 70–100 мг.

Цинк – один із життєво необхідних мікроелементів. Дефіцит цинку визнано проблемою охорони здоров’я у багатьох країнах, що розвиваються [43]. Навіть незначний дефіцит цинку призводить до серйозної депресії імунної системи. Підвищена сприйнятливість до інфекції пов’язана із порушенням розвитку та диференціювання Т- та В-лімфоцитів та їх зниженою активністю [44]. Дослідження показали, що навіть незначний дефіцит цинку призводить до зменшення кількості лімфоїдних органів і зменшення кількості імуноглобулінів [45]. Зазвичай боротьба організму з патогенними мікроорганізмами ініціюється активацією системи

комплементу, а також природних клітин-кілерів та поліморфноядерних лейкоцитів. Усі ці захисні механізми
пригнічуються у випадку дефіциту цинку, що призводить в майбутньому до хронізації запалення. Крім того, цинк допомагає захищати організм від гіперактивної
імунної відповіді, яка призводить до серйозної алергії


та аутоімунних захворювань [46]. Добова потреба людини в цинку становить 10-15 мг. Вітамін Е є активним антиоксидантом, гальмує перекисне окиснення ліпідів, яке посилюється при багатьох захворюваннях, запобігає пошкодженню клітинних структур вільними радикалами. Бере участь у процесах тканинного дихання, біосинтезі гему та білків, обміну жирів та вуглеводів, проліферації клітин та інших метаболічних процесах. Потреба дорослої людини в цьому вітаміні складає 12–15 мг на добу.

Вітамін А (ретинол) має нормалізуючу дію на процеси росту, в тому числі на ріст та формування скелету, забезпечує оптимальний структурний та функціональний стан епітеліальних клітин шкіри, залоз та слизових оболонок, які вистилають поверхню та порожнини тіла. Важливим є входження його в хімічні структури рецепторів органів зору, що дає можливість бачити у сутінках та забезпечує швидку адаптацію в темряві. Вітамін А підвищує опірність організму до різних екстремальних чинників та витривалість під час навантажень. В поєднанні з вітаміном С чинить протисклеротичну дію. Потреба дорослої людини у вітаміні А становить до 1,5 мг на добу. Вітамін В6 входить до складу ензимів, які беруть участь у процесах декарбоксилювання та переамінування амінокислот. Необхідний для нормального функціонування периферичної та центральної нерво-
вої системи. Піридоксин належить до ліпотропних речовин, які запобігають виникненню жирової інфільтрації печінки, що призводить до цирозу. Піридоксин стимулює шлункову секрецію, сприяє підвищенню кислотності шлункового соку, відіграє роль у профілактиці атеросклерозу. Добова потреба дорослої людини в піридоксині становить 1,5–3 мг, для дитини — 0,4–2 мг.
Пантотенова кислота є субстратом для синтезу коензимів ацетилювання. Бере участь у вуглеводному та жировому обмінах, синтезі ацетилхоліну, кортикостероїдів. Оптимізує енергетичне забезпечення міокарда, покращує процеси регенерації. Добова потреба людини в пантотеновій кислоті становить близько 10 мг.
Інтерес до ролі вітаміну D3 в організмі людини неухильно росте з часу його відкриття. В останні роки активно вивчається вплив вітаміну D на імунітет і запалення. Наприклад, Fairchok M. та ін. у своїй науковій роботі наводить дані про зв’язок між низьким рівнем 25-OH вітаміну D у сироватці крові та частотою респіраторних захворювань [47]. Наукові дані свідчать про зв’язок між рівнем забезпеченості організму вітаміном D й синтезом антимікробних пептидів, зокрема дефензинів та кателіцидину [48]. Імуномодулююча дія вітаміну D на Т-лімфоцити призводить до зниження синтезу прозапальних і продиференційних інтерлейкінів, а також до підвищення синтезу антизапальних цитокінів, що зумовлює терапевтичний ефект вітаміну D на лікування хронічних аутоімунних захворювань (зокрема, псоріазу) [49]. Потреба в кальциферолі залежить від віку: для дорослих становить 1000 МО, а для дітей 500–600 МО на добу..
Вітамін В12 має високу біологічну активність та бере участь у вуглеводному, білковому, ліпідному обмінах. Підвищує регенерацію тканин, нормалізує кровотворення, функції печінки та нервової системи. Орієнтовна потреба в ньому 3 мкг.
42 Журнал «Сучасна фармація» • modern-pharmacy.com.ua • 2023 / лютий • Арсенал знань • Професійний конкурс
ТЕРАПЕВТИЧНІ ВЛАСТИВОСТІ РОСЛИН У СКЛАДІ ПРОБІЗ® ІМУНО
Екстракт шпинату володіє антиоксидантними та гепатопротекторними властивостями [11].
Екстракт алое вера використовується як ефективний рослинний імуностимулюючий засіб, посилює фагоцитоз, а також впливає на рівень циркулюючих моноцитів та макрофагів. Він має в основі антибактеріальну, фунгіцидну, репаративну, протизапальну, гепатопротекторну, антиоксидантну, антидіабетичну та протиалергічну дію [12–13].



Екстракт базиліку в багатьох дослідженнях розглядають як безпечний антибактеріальний та протигрибковий засіб.
У Південній Азії базилік дуже популярний. Він здобув репутацію цілющої рослини. За останні десятиліття були підтверджені наступні терапевтичні ефекти базиліка: адаптогенні, антимікробні, протизапальні, кардіо- і гепатопротекторні, імуномодулюючі, метаболічні, протиракові, антиоксидантні, радіозахисні, антидіабетичні, спазмолітичні. Базилік, завдяки унікальній комбінації фармакологічних характеристик, здатний справлятися зі стресом.
Систематичне споживання базиліку знижує ризик порушення роботи серцево-судинної системи та кровообігу в головному мозку [14]. Він також захищає нейрони від пошкоджень, запобігає їх загибелі, відновлює поведінкові та когнітивні функції [15]. Завдяки вживанню листя базиліка активізуються пізнавальні процеси і зміцнюється пам’ять, покращується нервово-м’язова координація [16–17]. Екстракти базиліка перешкоджають утворенню тромбів, мають судинорозширювальну дію, що можна ефективно використовувати в терапії судинних захворювань [18]. Також вони попереджають ураження клітин міокарду при інфаркті [19]. Базилікова олія проявляє антибактеріальну дію, особливо по відношенню до стафілококів, сальмонели, кишкової палички, посилює дію антибіотиків [20]. В експерименті «in vitro» виявлена антивірусна активність по відношенню до збудників вірусної діареї, а також ДНК-РНК вірусів, ентеровірусу (EV 71), вірусу герпесу, гепатиту В, аденовірусу [21–22].

В останні роки зростає інтерес до соку з паростків пшениці як до компоненту лікувального харчування. Терапевтичні властивості соку обумовлені його складом, зокрема високим вмістом хлорофілу, каротину, вітамінів (А, С і Е), біофлавоноїдів, заліза, мінеральних речовин (кальцію, калію, натрію, цинку, міді, алюмінію і магнію), сірки, фосфору і 17 амінокислот, 8 з яких є незамінними [23–28]. Сік з паростків пшениці використовується в комплексній терапії таких захворювань, як таласемія, гемолітична і хронічна анемія, артрит, тканинна гіпоксія, захворювання травної системи, виразковий коліт, атеросклероз, рак [29–30].
Інтерес вчених до моринги підтверджується 931 публікацією на PubMed, 76 % з яких були опубліковані в останнє десятиліття [31]. Усі частини моринги маслянистої — ароматні квітки, яскраво-зелене листя, коричневі плоди, заповнені маслянистим насінням, стовбур, кора і коріння — мають лікувальні властивості. Але особливо цікаве листя моринги. Фітохімічний аналіз показав, що воно особливо багате вітамінами і мінералами, незамінними амінокислотами, флавоноїдами, каротиноїдами, токоферолами (α, γ, δ), поліненасиченими жирними кислотами та іншими речовинами, в цілому 35 корисними сполуками [32]. Завдяки такому складу біологічно активних речовин ця рослина проявляє різноманітні корисні ефекти, в тому числі впливає на вуглеводний і ліпідний обміни. Антиоксиданти кверцетин, феноліни, що містяться в моринзі маслянистій, поглинають вільні радикали, які утворюються в надмірній кількості при гіперглікемії і захищають β-клітини підшлункової залози від апоптозу. Морингінін сприяє поліпшенню чутливості тканин до інсуліну. Хлорогенова кислота знижує глюконеогенез і глікогеноліз у печінці [33]. З огляду на вплив на вуглеводний і ліпідний обмін, листя цієї цілющої рослини рекомендують як доповнення до дієтотерапії особам з преддіабетом і цукровим діабетом 2-го типу. М’ята та лемонграс проявляють антисептичні та протизапальні властивості.
ЦІКАВІ ФАКТИ! Батьківщиною базиліку вважається Південна Азія, де він більше відомий під назвою тулсі (на мові хінді). На території Стародавньої Індії базилік вважають священною рослиною. У духовноматеріальних практиках аюрведи за допомогою базиліку люди звільняються від матеріальних бажань, відкривають розум для мудрості, а серце — для щастя і всепоглинаючої любові.


Журнал «Сучасна фармація» • modern-pharmacy.com.ua • 2023 / лютий • Арсенал знань • Професійний конкурс 43
Хлорела — одноклітинна зелена водорость. До складу Chlorella входять протеїн, хлорофіл, харчові волокна, жирні кислоти, каротиноїди, сульфітовані полісахариди, глікопротеїни, антиоксиданти, нуклеїнові кислоти, мікроелементи, вітаміни тощо, що пояснює її значну біологічну активність [34]. У зв’язку з цим зростає кількість робіт, що вивчають Chlorella vulgaris не тільки як джерело корисних речовин для використання в функціональному харчуванні, але і можливості її застосування в лікувальних і профілактичних цілях [35]. Так, є дані про позитивний вплив хлорели на ступінь кардіоваскулярного ризику, її виражений гіпотензивний ефект [36]. Результатами досліджень відзначено зниження рівня глюкози в крові, підвищення кількості глутатіон-позитивних клітин при цукровому діабеті, підвищення відсотку інсулін-продукуючих бетаклітин і глюкагон-продукуючих клітин [37]. Також доведено вплив Chlorella vulgaris на регуляцію рівня лімфоцитів, гранулоцитів та інших імунокомпетентних клітин [38]. Є дані про позитивні зміни рівня білірубіну і ферментів печінкового метаболізму [39]. Досить велику кількість робіт присвячено впливу прийому хлорели на ліпідний обмін [40]. Деякими авторами отримані цікаві дані про вплив вживання хлорели при окисному



стресі: дослідниками виявлено значне підвищення
антиоксидантної здатності сироватки крові, знижен-
ня загальної втомлюваності, тощо [41]. При вживанні водної суспензії хлорели (Chlorella vulgaris) здоровими людьми протягом 28 днів спостерігалася позитивна динаміка САН (опитувальник для оцінки загального стану — самопочуття, активність, настрій). По закінченню курсу жоден із обстежених не відчував погіршення самопочуття. Навпаки, позитивна динаміка спостерігалася у 84,3 %:
46,7 % відзначили підвищення загального тонусу, зменшення тривалості необхідного для відновлення сну;
30 % відзначили нормалізацію роботи кишечника; зареєстровано достовірне зменшення обсягів талії і стегон;
зареєстрована чітка тенденція до зниження величини вмісту вісцерального жиру як у жінок, так і у чоловіків; зареєстровано суттєве підвищення ефективності гемодинаміки за рахунок зниження показників систолічного і діастолічного тиску, що виявляється як в стані м’язового спокою, так і при забезпеченні виконання фізичного навантаження;
показаний вплив живого екстракту хлорели на стимуляцію першої лінії імунного захисту;
під впливом курсового прийому хлорели поліпшується функціональний стан печінки, на що вказує зменшення коефіцієнту де Ритиса (співвідношення АсТ/АлТ) [42].
ПРОБІЗ® ІМУНО — СИЛА ПРИРОДНИХ КОМПОНЕНТІВ
Пробіотично-вітамінна композиція з екстрактами трав ПРОБІЗ® ІМУНО випускається у зручній формі шипучих таблеток, що містять цілий комплекс перелічених раніше компонентів та допомагають задовольнити щоденні потреби організму. При цьому дорослим та дітям, старшим за 14 років, достатньо всього 1 таблетки на добу. Актуальність імуномодуляторів під час пандемії коронавірусу, сезонних гострих респіраторних вірусних інфекцій (ГРВІ) та грипу в якості засобів профілактики та комплексної терапії просто беззаперечна. У зв’язку з цим важливим питанням
фармації і медицини є розробка нових технологій лікарських препаратів і методів лікування, що поєднують безпеку і ефективність. Резюмуючи всю інформа-


цію, що відома про окремі складові комплексного засобу ПРОБІЗ® ІМУНО, можна стверджувати, що він підтримує адекватну імунну відповідь та володіє доведеною ефективністю. ПРОБІЗ® ІМУНО проявляє імуномодулюючу дію, володіє противірусною активністю, підвищує клітинну резистентність.
У складі комплексної терапії може бути застосований для лікування герпесвірусної інфекції, преддіабету та цукрового діабету 2-го типу, атеросклерозу, призначається при явищах дисбіозу, гіпо- та авітамінозах, при стресі, в період застуд та вірусних інфекцій в якості профілактичного та імуномодулюючого засобу.
44 Журнал «Сучасна фармація» • modern-pharmacy.com.ua • 2023 / лютий • Арсенал знань • Професійний конкурс
Використана література
1. Petschow B., Doré J., Hibberd P. et al. Probiotics, prebiotics, and the host microbiome: the science of translation // Ann. N.Y. Acad. Sci. — 2013. — Vol. 1306. — P. 1–17.
2. Adami A. Biomass production, preservation and characteristics of a strain of Bacillus coagulans as probiotic[Text]/ A.Adami, V. Cavazzoni // Microbiologie Aliments Nutrition.–1993.– Vol. 11.- P. 93-100.
3. Babar V. Immunomodulatory activity of Lactobacillus sporogenes [Text] / V. Babar, R. omas, M. Bhaskar // International Journal of erapeutic Applications.– 2012,–Vol.3.– P.32–38.
4. Ratna Sudha, Madempudi, Jayesh, J. Ahire, Jayanthi, Neelamraju, Anirudh Tripathi & Satyavrat Nanal. Randomized clinical trial: the e ect of probiotic Bacillus coagulans Unique IS2 vs. placebo on the symptoms management of irritable bowel syndrome in adults//Article number: 12210 (21 August 2019).
5. Ratna Sudha Madempudi, Jayanthi Neelamraju, Jayesh J Ahire, Sandeep K Gupta, Vineet K Shukla. Bacillus coagulans Unique IS2 in Constipation: A Double-Blind, Placebo-Controlled Study//Probiotics Antimicrob Proteins. 2020 Jun;12(2):335–342.doi: 10.1007/s12602–019–09542–9.
6. Kodali V.P. Antioxidant and free radical scavenging activities of an exopolysaccharide from a probiotic bacterium/ V.P. Kodali, R. Sen // Biotechnol J.– 2008.–Vol.3.– P. 245–251.
7. Kumar O.R.M. Feeding of L. sporogenes to rabbits/ O.R.M. Kumar, K.J. Christopher // Ind. Vet. J.– 1989. — Vol.66.– P.896–898.
8. Mohan J.C. Short term hypolipidemic e ects of oral Lactobacillus sporogenes therapy in patients with primary dyslipidemias [Text] / J.C. Mohan, R. Arora, M. Khalilullah // Indian Heart Journal. – 1990. – Vol.42. – P.361–364.
9. Ratna Sudha, Madempudi, Jayesh, J. Ahire, Jayanthi, Neelamraju, Anirudh Tripathi & Satyavrat Nanal. Randomized clinical trial: the e ect of probiotic Bacillus coagulans Unique IS2 vs. placebo on the symptoms management of irritable bowel syndrome in adults//Article number: 12210 (21 August 2019).
10. Ratna Sudha Madempudi, Jayanthi Neelamraju, Jayesh J Ahire, Sandeep K Gupta, Vineet K Shukla. Bacillus coagulans Unique IS2 in Constipation: A Double–Blind, Placebo-Controlled Study//Probiotics Antimicrob Proteins. 2020 Jun;12(2):335–342.doi: 10.1007/s12602–019–09542–9.

11. Никифорук А. Я., Фіра Л. С., Лихацький П. Г. Дослідження антиоксидантних властивостей екстракту зі шпинату городнього листя на моделі тетрахлорметанового ураження печінки // Ужгородський національний університет, тернопільський державний медичний університет імені І.Я. Горбачевського. Медична та клінічна хімія. — 2018. — Т. 20. — № 4.
12. Mary D Boudreau, Frederick A Beland. An Evaluation of the Biological and Toxicological Properties of Aloe Barbadensis (Miller), Aloe Vera//May 2006 Journal of Environmental Science and Health Part C 24(1):103–54.
13. Tesfaye Fatalo Falaro, Sitota Tesfaye. Review on Pharmacological Activities of Herbal Plants: Aloe vera and Guava//Global Journal of Pharmacology 14 (2): 17–27, 2020.
14. Bora K.S., Arora S., Shri R. Role of Ocimum basilicum L. in prevention of ischemia and reperfusion-induced cerebral damage, and motor dysfunctions in mice brain — J.Ethnopharmacol. 2011, Oct 11, 137 (3), 1360– 1365.
15. Цывунин В.В., Штрыголь С.Ю., Прокопенко Ю.С. Нейропротекторные свойства сухих экстрактов дымянки шлейхера и базилика камфорного. Обзоры по клинической фармакологии и лекарственной терапии. — 2013, 11, 3,66–71. DOI: 10.17816/RCF11366–714.
16. Sarahroodi S., Esmaeili S., Mikaili P., Hemmati Z., Saberi Y. e e ects of greenOcimum basilicum hydroalcoholic extract on retention and retrieval of memory inmice — Anc. Sci. Life. 2012, Apr., 31(4), 185–189. DOI: 10.4103/0257–7941.1073545.
17. Zahra K., Khan M.A., Iqbal F. Oral supplementation of Ocimum basilicum has thepotential to improves the locomotory, exploratory, anxiolytic behavior and learningin adult male albino mice. — Neurol. Sci. 2015, Jan., 36(1), 73–78. DOI:10.1007/s10072–014–1913–36.
18. Tohti I., Tursun M., Umar A., Turdi S., Imin H., Moore N. Aqueous extracts of Ocimum basilicum L. (sweet basil) decrease platelet aggregation induced by ADPand thrombin in vitro and rats arterio-venous shunt thrombosis in vivo — romb. Res. 2006, 118(6), 733–739. DOI: 10.1016/j.thromres. 2005. 12.0117.
19. Fathiazad F., Matlobi A., Khorrami A., Hamedeyazdan S., Soraya H., Hammami M.,Maleki–Dizaji N., Garjani A. Phytochemical screening and evaluation ofcardioprotective activity of ethanolic extract of Ocimum basilicum L. (basil) againstisoproterenol induced myocardial infarction in rats – Daru 2012, Dec 5, 20(1), 87.DOI: 10.1186/2008–2231–20–87.
20. Hossain M.A., Kabir M.J., Salehuddin S.M., Rahman S.M., Das A.K., Singha S.K.,Alam M.K., Rahman A. Antibacterial properties of essential oils and methanolextracts of sweet basil Ocimum basilicum occurring in Bangladesh – Pharm. Biol.2010, May, 48(5), 504–511 DOI: 10.3109/138802009031909779.
21. Kubiça T.F., Alves S.H., Weiblen R., Lovato L.T. In vitro inhibition of the bovine viral diarrhoea virus by the essential oil of Ocimum basilicum (basil) andmonoterpenes — Braz. J. Microbiol. 2014, Apr 11, 45(1), 209–214. DOI:10.1590/ S1517–83822014005000030.
22. Chiang L.C., Ng L.T., Cheng P.W., Chiang W., Lin C.C. Antiviral activities ofextracts and selected pure constituents of Ocimum basilicum – Clin Exp PharmacolPhysiol. 2005, Oct, 32(10), 811–816. DOI: 10.1111/j.1440–1681.2005.04270.x.
23. Bar-Sela G., Tsalic M., Fried G. Wheatgrass Juice May Improve Hematological Toxicity Related to Chemotherapy in Breast Cancer Patients: APilot Study // Nutrition and Cancer. — 2007. — vol 58 (2). — pp. 43–48.
24. Kothari S., Jain A.K., Mehta S.C. Hypolipidemic e ect of fresh triticum aestivum (Wheat) grass Juice in hypercholesterolemic rats // Acta Poloniae Pharmaceutica. — 2011. — vol. 68(2). — pp.291–294.
25. Priyabrata D., Ashis M. In vitro Studies of Iron Chelation Activity of Puri ed Active Ingredients Extracted from Triticum aestivum Linn. (Wheat Grass) // European Journal of Medicinal Plants. — 2012. — vol. 62 (2). — pp.113–124.
26. Padalia S., Drabu S., Raheja I. Multitude potential of wheatgrass juice (Green Blood): An overview // Chronicles of Young Scientists. — 2010. — vol. 1(2). — pp. 23–28.
27. Ashok S.A. Phytochemical and pharmacological screening of wheatgrass juice // International Journal of Pharmaceutical Sciences Review and Research. — 2011. — vol. 9(1). — pp.159–164.
28. Singh N., Verma P., Pandey B. R. erapeutic Potential of Organic Triticum aestivum Linn. (Wheat Grass) in Prevention and Treatment of Chronic Diseases: An Overview // International Journal of Pharmaceutical Sciences and Drug Research. — 2012. — vol. 4(1). — pp.10–14.
29. Singh K., Pannu M.S., Singh,P, Singh J. E ect of Wheat Grass Tablets on the Frequency of Blood Transfusions in alassemia Major // e Indian Journal of Pediatrics. — 2010. — vol. 77(1). — pp.90–91.
30. Reynolds. C. DNA–technology-based cellular assay used to measure speci c biological activity in a wheatgrass extract // Australasian Integrative Medicine Association. — 2005. — vol. 7(1). — pp.37–39.
31. URL: https://www.ncbi.nlm.nih.gov/pubmed/?term=moringa

32. Ayon Bhattacharya [et al.]. A Review of the Phytochemical and Pharmacological Characteristics of Moringa oleifera // J. Pharm. Bioallied. Sci. — 2018. — № 10 (4). — Р. 181–191. DOI: 10.4103/JPBS.JPBS_126_18.
33. Lakshmipriya Gopalakrishnan [et al.]. Moringa oleifera: A review on nutritive importance and its medicinal application // Food Science and Human Wellness. — 2016. — № 5. — Р. 49–56.
34. Hsu H.Y., Jeyashoke N., Yeh C.H., Song Y.J., Hua K.F., Chao L.K. Immunostimulatory Bioactivity of Algal Polysaccharides from Chlorella pyrenoidosa Activates Macrophages via Toll–Like Receptor,

35. Ebrahimi-Mameghani M, Sadeghi Z, Farhangi MA, Vaghef-Mehrabany E, Aliashra S. Glucose homeostasis, insulin resistance and in ammatory biomarkers in patients with non-alcoholic fatty liver disease: Bene cial e ects of supplementation with microalgae Chlorella vulgaris: A double-blind placebo-controlled randomized clinical trial. Clinical Nutrition. 2017; 36(4): 1001‒6. PMID: 27475283. doi: 10.1016/j.clnu.2016.07.004.
36. Zhao C, Wu YJ, Yang CF, Liu B, Huang YF. Hypotensive, hypoglycaemic and hypolipidaemic e ects of bioactive compounds from microalgae and marine microorganisms. International Journal of Food Science and Technology. 2015; 50(8): 1705‒17. doi: 10.1111/ijfs.12860.
37. Amin A., Lotfy M. Mahmoud-Ghoneim. Pancreas-protective e ects of chlorella in STZ-induced diabetic animal model: insights into the mechanism. Journal of Diabetes Mellitus. 2011; 1: 36‒45. doi: 10.4236/jdm.2011.13006.
38. Kubota H., Amat N., Yimit D. Single Cellular Algae Digestive Supplement Designed by Yeast & Lactobacillus Rearranged Leukocyte Subsets through Activation of Complement Components. OJI. 2015; 5(3). doi: 10.4236 / oji.2015.53011 Фізичне виховання і спорт 260 Український журнал медицини, біології та спорту. — 2020. — Том 5, № 2 (24).
39. Shibata S., Hayakawa K., Egashira Y., Sanada H. Hypocholesterolemic mechanism of Chlorella: Chlorella and its indigestible fraction enhance hepatic cholesterol catabolism through up-regulation of cholesterol 7alpha-hydroxylase in rats. Biosci Biotechnol Biochem. 2007; 71(4): 916‒25. PMID: 17420587. doi: 10.1271/bbb.60566
40. Kim S., Kim J., Lim Y., Kim Y.J., Kim J.Y., Kwon O. A dietary cholesterol challenge study to assess Chlorella supplementation in maintaining healthy lipid levels in adults: a double-blinded, randomized, placebo-controlled study. Nutrition Journal. 2016; 15. PMID: 27177615. PMCID: PMC4866071. doi.org/10.1186/ s12937-016–0174–9.

41. Amin A. Chemopreventive e ect of chlorella on the antioxidant system in DMBAinduced oxidative stress in liver. International Journal of Pharmacology. 2008; 4: 169‒76. doi: 10.3923/ijp.2008.169.176.
42. Юшковська О.Г., Плакіда О.Л., Філоненко О.В. Дослідження впливу курсового прийому водної суспензії живої хлорели на фізичну працездатність і показники крові здорових людей // Одеський національний медичний університет Український журнал медицини, біології та спорту. — 2020. — Том 5, № 2 (24).
43. Kewcharoenwong, C., Sein, M.M., Nithichanon, A. et al. Daily preventive zinc supplementation increases the antibody response against pathogenic Escherichia coli in children with zinc insu ciency: a randomised controlled trial. Sci Rep 12, 16084 (2022).
44. Mulhern S.A., Vessey A.R., Taylor G.L., Magruder L.E. Suppression of antibody response by excess dietary zinc exposure during certain stages of ontogeny // Proceedings Society Ex. Biol. Med. 1985. Vol. 180, N. 3. P. 453–461.
45. Tetreault N.A., Hakeem A.Y., Jiang S. Microglia in the cerebral cortex in autism // J. Autism Developmental Dis. 2012. Vol. 42, N 12. P. 2569–2584.
46. Manish Dhawan, Talha Bin Emran, Priyanaka, Om Prakash Choudhary. Immunomodulatory e ects of zinc and its impact on COVID-19 severity. Annals of Medicine and Surgery, Volume 77, 2022.
47. Fairchok M., Scho eld C., Chen W., Pugh M., Bigg H. Inverse Correlation between 25-OH Vitamin D Levels and Severity of Viral Respiratory Illness in Infantsю Journal of Infectious Diseases and Epidemiology. 2017. vol. 3. no 2. Р. 1-7.
48. Chung C, Silwal P, Kim I, Modlin RL, Jo EK. Vitamin D-Cathelicidin Axis: at the Crossroads between Protective Immunity and Pathological In ammation during Infection. Immune Netw. 2020 Feb 11;20(2):e12.
49. Stanescu AMA, Simionescu AA, Diaconu CC. Oral Vitamin D erapy in Patients with Psoriasis. Nutrients. 2021 Jan 6;13(1):163.
Журнал «Сучасна фармація» • modern-pharmacy.com.ua • 2023 / лютий • Арсенал знань • Професійний конкурс 45
ФАХІВЦІ!
Оголошується професійний конкурс
на знання важливих аспектів використання
вітамінно-пробіотичного комплексу
ПРОБІЗ® ІМУНО
Серед учасників, які нададуть вірні відповіді, будуть рандомно обрані
10 переможців
1. Яку назву мають живі мікроорганізми, вживання яких в адекватних кількостях покращує стан здоров’я людини:
А. Симбіотики
B. Пробіотики
С. Пребіотики
D. Ксенобіотики Е. Антибіотики
2. Скільки видів рослинних екстрактів входять до складу ПРОБІЗ® ІМУНО:
А. 7
B. 12
С. 17
D. 9
3. Які переваги спорової форми бактерії Bacillus coagulans, що входить до складу ПРОБІЗ® ІМУНО?

А. Зберігає активність під впливом шлункового соку і жовчі
B. Стійка при тривалому зберіганні
С. Не пошкоджується під час технологічних процесів виготовлення препарату
D. Зберігає активність у присутності антибіотиків Е. Всі відповіді вірні
4. Якою дією на організм володіють пробіотичні
мікроорганізми Bacillus coagulans у складі ПРОБІЗ® ІМУНО? (дві відповіді)

А. Пребіотична дія
B. Імуномодулююча дія
С. Детоксикаційна дія
D. Гіпохолістеринемічна дія
ЯК ВЗЯТИ УЧАСТЬ?
Спосiб 1. Переходьте за QR-кодом та вiдповiдайте на запитання.

Спосiб 2. Шукайте посилання на конкурс на сторінці «Сучасна фармація» у Facebook
Спосiб 2. Вiдповiдi iз заповненою анкетою учасника надсилайте на електронну адресу редакцiї publicpharmacy@gmail.com
5. З якою метою рекомендується застосування ПРОБІЗ® ІМУНО? (дві відповіді)
А. Нормалізація вагінальної мікрофлори
B. Зниження ваги
С. Підтримка здорової мікрофлори кишечника
D. Підтримка нормального імунітету
6. До складу ПРОБІЗ ІМУНО® входить 7 вітамінів та мікроелемент…
А. Se
B. Ca С. Zn
D. Mn
7. Рекомендований курс застосування ПРОБІЗ® ІМУНО складає:
А. 21 день
B. 10 днів

С. 30 днів
D. 45 днів
8. В який час рекомендується застосовувати ПРОБІЗ® ІМУНО?
А. Разом з антибіотиками
B. Через 2 години після вживання антибіотиків, разом з їжею С. Незалежно від прийому їжі
9. Дітям з якого віку можна вживати ПРОБІЗ® ІМУНО?
А. Від 2 років
B. Від 6 років
С. Від 10 років
D. Від 14 років
10. Вкажіть режим дозування ПРОБІЗ® ІМУНО для дорослих і дітей старше 14 років:

А. 1 таблетка на добу
B. 2 таблетки на добу
С. 3 таблетки на добу
Анкета учасника
ПIБ ____________________________________________________
Населений пункт, область __________________________________
Мiсце роботи, посада ______________________________________ Телефон ________________________________________________ Чекаємо на Вашi вiдповiдi та бажаємо успiхiв!
ШАНОВНІ















































Кошовий Олег Миколайович , доктор фармацевтичних наук, професор, завідувач кафедри фармакогнозії
У 1985 р. S. Eaton і M. Konnor висунули гіпотезу, що зростання числа хвороб цивілізації в другій половині ХХ ст. зумовлене тим, що гени сучасної людини, адаптовані тривалим еволюційним процесом до харчової поведінки пращурів, не здатні забезпечити здоров’я в умовах різкої зміни способу життя за останні 100 років. Останній час їжа стала більш різноманітною та доступною, а деяким категоріям людей дуже важко самостійно контролювати свою харчову поведінку.
В економічно розвинених країнах метаболічні
порушення набули характеру епідемії, тоді як серед
етнічних груп населення, що зберігають традиційний

для них спосіб життя, практично відсутні аутоімунні



та алергічні захворювання, не фіксується зростання
цукрового діабету, нирково- та жовчно-кам’яної хвороби, ожиріння та артеріальної гіпертензії.
В першу чергу, дефекти ліпідного та вуглеводного обмінів провокують каскад генетичних, метаболічних, гормональних, нервових, запальних та інших реакцій і порушень у клітинах, тканинах та органах, що провокує метаболічний синдром та асоційовані з ним захворювання. Як самостійний симптомокомплекс клінічних проявів, метаболічний синдром вперше був описаний у 1980 р. (M. Hanefeld, W. Leonhardt).
Метаболічний синдром — це патогенетично взаємозв’язані метаболічні порушення у стані хворої людини. Великий комплекс факторів, які беруть участь у виникненні метаболічного синдрому, заважає точним науковим уявленням щодо його патофізіологічних механізмів, тому профілактичні заходи є дуже актуальними.
До факторів ризику розвитку метаболічного синдрому належать:
генетична схильність;
надмірне харчування;
інсулінорезистентність;
ожиріння;
шкідливі звички;

гіподинамія;
стресові впливи;

екологічні умови довкілля.
При збереженні негативних умов, які зумовлюють виникнення метаболічного синдрому, компенсаторні адаптивні резерви організму повністю вичерпуються, що надалі призводить до основних клінічних ускладнень (ожиріння, гіперглікемії, інсулінорезистентності, гіперінсулінемії, артеріальної гіпертензії та дисліпідемії). У разі незбалансованого харчування та дисбіозу функціональні порушення змінюються стійкими метаболічними, гемодинамічними та органними ушкодженнями.
A
48 Журнал «Сучасна фармація» • modern-pharmacy.com.ua • 2023 / лютий • Арсенал знань • Експертна думка
Епідеміологічні дослідження останніх років свідчать, що у пацієнтів із серцево-судинними захворюваннями часто діагностують, крім артеріальної гіпертензії та дисліпідемії, надмірну масу тіла, зсуви у толерантності до глюкози, гіперглікемію, гіперінсулінемію, інсулінорезистентність, гіперагрегацію тромбоцитів, мікроальбумінурію, підвищену активність симпатичної нервової системи та інші клінічні прояви у різних поєднаннях.
В умовах прогресуючого дефіциту макро- та мікронутрієнтів та їх метаболітів виникає дисбаланс у роботі базових регуляторних механізмів підтримки гомеостазу, що призводить до порушення у фізіологічних системах, метаболічних та поведінкових реакціях. Для їх усунення організм компенсаторно мобілізує імунологічні та нейрогуморальні системи збереження гомеостазу. Підвищений синтез та викидання у біологічні рідини різноманітних трансмітерів, гормонів, медіаторів імунних та оксидантно-антиоксидантних реакцій переводить резерви організму на забезпечення найважливіших систем життєдіяльності. У разі ліквідації факторів ризику, джерел стресу, додаткового постачання нутрієнтів їжі організм відновлює життєздатність у повному обсязі. Тому корекція харчової поведінки, використання функціональних та харчових добавок під наглядом лікарів, помірне фізичне навантаження дає змогу в багатьох випадках відновити або покращити стан здоров’я людини.

В усьому світі для корекції цих порушень активно створюються різні функціональні та харчові добавки. Багато українських виробників також дотримуються цього тренду та створюють сучасні якісні засоби. Так, АТ «Київський вітамінний завод» була розроблена дієтична добавка «СТИФІМОЛ ПЛЮС», яка дозволяє покращити метаболічні процеси та допомагає відкоригувати харчову поведінку людям, які контролюють свою вагу, за рахунок зменшення апетиту.


Ця дієтична добавка в своєму складі містить:
екстракт гарцинії камбоджійської;
L-карнітин;
L-тирозин;

куркумін;
калію йодид;
хрому пиколінат.
Шкірка фруктів Гарцинії камбоджійської (Garcinia gummi-gutta)

Екстракт гарцинії камбоджійської входить до складу багатьох дієтичних та функціональних добавок, які використовуються для корекції зайвої ваги. Популярність цієї рослини підтверджується більш ніж 11 мільйонами посилань, що відображаються під час пошуку терміну «Garcinia cambogia» у Google. На ринку України представлено більше 20 таких добавок, але більшість з них є однокомпонентними та вартість їх в 2–5 разів перевищує ціну добавки «СТИФІМОЛ ПЛЮС».
Шкірка фруктів Гарцинії камбоджійської (Garcinia gummi-gutta) традиційно використовується як ароматизатор у рибному каррі завдяки кислому смаку. Крім того, в етнічних регіонах поширення цієї рослини плоди застосовують як засіб для лікування шлунково-кишкового тракту, боротьби з кишковими паразитами та ревматизмі. На теперішний час ця сировина найбільш популярна і широко розрекламована як добавка для схуднення [1].

Дослідження показали, що така дія зумовлена значним вмістом у шкірці фрукта гідроксилимонної кислоти (ГЛК), яка має вплив на обмін ліпідів у організмі та ефективна при ожирінні, оскільки зменшує апетит, споживання їжі та рівень жиру в організмі шляхом регулювання рівня серотоніну, який впливає на відчуття ситості, підвищення окислення жирів та зниження ліпогенезу. ГЛК є потужним інгібітором аденозинтрифосфат-цитратної ліази, каталізатора у процесі конверсії цитрату до ацетил-коферменту А, який відіграє ключову роль у синтезі жирних кислотах, холестерину та тригліцеридів [1].
Попередні фітохімічні дослідження сировини та екстрактів з цієї рослини виявили присутність алкалоїдів, флаваноїдів, фенольних сполук, сапонінів, дубильних речовин, вуглеводів та білків. В індивідуальному стані з різних частин рослини було виділено кілька ксантонів (карбогіол), бензофенонів (гарцинол), органічних кислот (ГЛК) та амінокислот (гамма-аміномасляна кислота) [1].
традиційно використовується як ароматизатор у рибному
каррі завдяки кислому смаку. Крім того, в етнічних регіонах
поширення цієї рослини плоди застосовують як засіб для
лікування шлунково-кишкового тракту, боротьби з кишковими паразитами та ревматизмі.
На теперішний час ця сировина найбільш популярна і широко розрекламована як добавка для схуднення [1].
Журнал «Сучасна фармація» • modern-pharmacy.com.ua • 2023 / лютий • Арсенал знань • Експертна думка 49
Екстракт Гарцинії камбоджійської
активні речовини також виявляють гіполіпідемічну, протидіабетичну, протизапальну, протипухлинну, антигельмінтну, антихолінестеразну та гепатопротекторну активність у моделях in vitro та in vivo [1].
Дослідження на щурах-альбіносах лінії Wistar показало, що введення ГЛК та її лактону (ГЛКЛ) у
концентраціях 1.1, 3.7 та 5.5 ммоль на кг 1 раз на день
протягом 8 тижнів призвело до значного зменшення
споживання корму та зменшення приросту ваги щурів залежало від дози. Це вказує на те, що ГЛК та
екстракти Гарцинії камбоджійської є модуляторами
апетиту та здатні його знижувати [1, 2].
Ранджит та ін. [3] встановили, що ГЛК (300–1500 мг/кг, перорально) та її лактон (212–1063 мг/кг, перорально) потенційно знижують вживання їжі
та вагу тіла, не виявляючи токсичності у щурів.
При цьому виявлено, що ефект лактону був більш
виражений, ніж ефект ГЛК. Короткострокове


лікування за допомогою ГЛК (250 мг/день перорально
протягом 5 днів) у жінок підвищувало метаболізм
жиру та продуктивність фізичних вправ, було




помічено зниження коефіцієнту дихального обміну
та окислення вуглеводів під час фізичних вправ [4].
Антон та ін. [5] досліджували вплив ГЛК на
споживання їжі, ситість, втрату ваги і рівень окисного
стресу у людини. Вони використовували 2 дози
(2800 мг/день та 5600 мг/день) у осіб із ожирінням
та встановили, що обидві дози є безпечними та знижують апетит, що дозволяє коригувати вагу.
Дослідження in vitro Бландена [6] припустили, що екстракт плодів Гарцинії камбоджійської може
інгібувати накопичення ліпідів у жирових клітинах. Екстракт помітно зменшив масу тіла, вісцеральне накопичення жиру, концентрацію ліпідів у крові та печінці, рівень інсуліну та лептину в плазмі крові при дієті з високим вмістом жирів та ожирінням у мишей. Етанольний екстракт Гарцинії камбоджійської, що вводився щурам перорально у дозах 200 і 400 мг/кг 1 раз в день протягом 5 тижнів, значно знижував масу тіла та приводив до збільшення кількості еритроцитів [7]. Зниження рівня ліпопротеїдів дуже низької щільності у плазмі та ампліфікація рівня хіломікронів зафіксовано після лікування екстрактом. Рамос та співавтори [8] встановили, що ліофілізований екстракт Гарцинії камбоджійської (по 500 мг 3 рази на день протягом 8 тижнів) потенційно знижує масу тіла, рівень холестерину та тригліцеридів у людей із надмірною вагою, не виявляючи ніяких негативних наслідків [8]. Хаямідзу та ін. [9] встановили, що екстракт Гарцинії камбоджійської знижує накопичення вісцерального жиру у людини. У цьому дослідженні група людей вживали екстракт Гарцинії камбоджійської (1000 мг ГЛК на день) протягом 12 тижнів, при цьому спостерігалося помітне зменшення у вісцеральних, підшкірних та загальних жирових ділянках, зниження непереносимості глюкози і рівня резистину у плазмі крові після лікування.
Таким чином, наведені дані вказують про наукову обґрунтованість використання екстрактів Гарцинії камбоджійської для зменшення апетиту, боротьби з ожирінням та для допомоги при контролі за масою тіла.
Щоб отримати всього 1 грам чистого L-карнітину, вам потрібно
з’їсти:
0,5 кг яловичини;

більше 3-х кг свинини;
5 кг курятини;
10 кг сиру;
або 100 кг злаків.
L-карнітин — це ендогенна молекула, яка бере участь у метаболізмі жирних кислот, біосинтезується в організмі людини за допомогою амінокислот: L-лізину та L-метіоніну. L-карнітин знаходиться у багатьох продуктах харчування, таких як червоне м’ясо, а саме яловичина та баранина, риба, птиця та молоко. По суті, L-карнітин транспортує ланцюги
жирних кислот у матрикс мітохондрій, що дозволяє клітинам розщеплювати жир і отримувати енергію з накопиченого запасу жиру. Нещодавні дослідження почали висвітлювати корисні ефекти L-карнітину при використанні в різних клінічних терапіях. Так, L-карнітин та його ефіри допомагають зменшити окислювальний стрес; вони були запропоновані
ДЕ ЗНАХОДИТЬСЯ L-КАРНІТИН
та її біологічно
50 Журнал «Сучасна фармація» • modern-pharmacy.com.ua • 2023 / лютий • Арсенал знань • Експертна думка
для лікування багатьох станів, таких як серцева недостатність, стенокардія, втома та для збільшення





витривалості при фізичних вправах. L-карнітин є
безпечним та рекомендується як дієтична добавка
у певних категорій осіб, які не мають дефектів окислення жирних кислот [10]. Більше того, L-карнітин захищає клітину від збільшення ацил-КоА шляхом генерації ацилкарнітинів. М’язи людини містять велику кількість карнітину, але це залежить
від поглинання цієї сполуки з крові через неможливість м’язів синтезувати його. Окислення жирних
кислот у мітохондріях є важливим джерелом енергії
для м’язового обміну, особливо під час фізичних вправ. Однак, особливо під час високої інтенсивності вправ, цей процес, здається, обмежений
L-тирозин — умовно незамінна амінокислота, оскільки в нормальних умовах організм синтезує достатню кількість фенілаланіну. Однак для тих, хто має фенілкетонурію, дефіцит ферменту фенілаланінгідроксилази, яка запобігає перетворенню фенілаланіну в тирозин, робить тирозин незамінною амінокислотою для цієї популяції. Тирозин вбудовується в білки всіх форм життя і є попередником для синтезу тироксину, меланіну та нейромедіаторів: дофаміну і норадреналіну. Джерела тирозину в їжі включають рибу, соєві продукти, птицю, яйця, молочні продукти, боби, мигдаль, арахіс, кунжут, насіння гарбуза, зародки пшениці, овес, авокадо та банани. Клінічні умови, при яких добавки тирозину можуть мати терапевтичну користь, включають депресію, гіпертонію, стрес, когнітивні порушення, хворобу Паркінсона, фенілкетонурію та нарколепсію. Хоча L-тирозин має численні механізми дії, мабуть, найбільш клінічно значущим є його роль попередника у синтезі норадреналіну та дофаміну. Шляхом збільшення швидкості синтезу нейромедіаторів L-тирозин стимулює центральну нервову систему
Куркума — це спеція каррі, яка походить з Індії та викликала великий інтерес в останні десятиліття, оскільки вона містить біоактивні куркуміноїди (куркумін, деметоксикуркумін та бісдеметоксикуркумін).
Куркумін (1,7-біс- (4-гідрокси-3метоксифеніл) -гепта-1,6-дієн-3,5-діон) — ліпофільний поліфенол, який у дослідженнях in vitro, in vivo та клінічних випробуваннях показав протипухлинну, антибіотичну, протизапальну та протидіабетичну активність. У базі Scopus за останні п’ять років було опубліковано майже 10 000 статей щодо дослідження куркуміноїдів [14].

мітохондріальною доступністю вільного L-карнітину. Отже, окислення жирних кислот швидко знижується, збільшуючи інтенсивність фізичних вправ від помірної до високої. Враховуючи важливу роль жирних кислот у м’язовій біоенергетиці та обмежувальний вплив вільного карнітину на окиснення жирних кислот під час фізичних вправ на витривалість, припускають, що добавки L-карнітину збільшують витривалість та впливють на ліпідний обмін [11]. В дослідженнях Мадзена та співавторів [12] було показано, що лікування L-карнітином у безсимптомних пацієнтів з первинною недостатністю карнітину може не тільки запобігти серцевим ускладненням, а також посилити метаболізм жиру скелетних м’язів під час фізичних вправ.
та діє як антидепресант. L-Тирозин також служить попередником меланіну, пігменту кольору шкіри та волосся, що забезпечує захист проти шкідливих ультрафіолетових променів, і для гормону щитовидної залози — тироксину. Енкефаліни — пентапептиди, які мають знеболювальну дію, містять у своєму складі L-тирозин. На додаток, L-тирозин стимулює виробіток гормону росту і бере участь у функціях надниркових залоз та гіпофіза, діє як адаптоген, полегшуючи фізичні симптоми стресу, таких як високий кров’яний тиск, тривогу та перепади настрою. Через фенольну структуру тирозин є потужним антиоксидантом, знешкоджує численні вільні радикали та інгібує перекисне окислення ліпідів [13].
Журнал «Сучасна фармація» • modern-pharmacy.com.ua • 2023 / лютий • Арсенал знань • Експертна думка 51
Встановлено, що куркумін є ефективним при лікуванні діабету у пацієнтів та у моделях на тваринах. Арун і Наліні повідомили, що введення куркуми або куркуміну діабетичним щурам знижує рівень цукру та рівень гемоглобіну в крові [15]. Муруган і Парі в 2007 р. спостерігали зниження рівня загального
білка, альбуміну, глобуліну та співвідношення альбумін/глобулін у діабетичних щурів, що дозволило повернутися майже до норми після введення
куркуміну [16]. У діабетичних моделях пероральне введення куркуміну щурам призводило до значного зниження рівня глюкози у крові та збільшення рівня інсуліну в плазмі крові [16]. Автори дійшли висновку, що ефективність куркуміну, який міститься у нутрицевтиках, була добре продемонстрована
для кількох станів здоров’я, включаючи шкірні захворювання, пов’язані з артритом, метаболічні захворювання та депресивні розлади [14, 17].
Піколінат хрому — це харчова добавка, яка набирає популярності, особливо тих, хто прагне до зниження ваги. Хоча механізм, відповідальний за передбачувану дію піколінату хрому, не був ретельно досліджений, дослідження показують, що біохімічні, фізіологічні та поведінкові дії піколінату хрому можуть бути наслідком впливу піколінової кислоти на центральну нервову систему. Показано, що аналоги піколінової кислоти викликають глибокі зміни в метаболізмі серотоніну, дофаміну та норепнефрину в мозку. Піколінат хрому покращує різні метаболічні параметри та зменшує окислювальний стрес у щурів, знижуючи рівень глюкози, загального холестерину та тригліцеридів, малонового диальдегіду у сироватці крові та підвищує експресію транспортера глюкози печінки GLUT-2 та м’язів GLUT-4 [18].
Крім того, йод як мікроелемент покращує функціонування щитоподібної залози, активує метаболічні процеси та сприяє розщепленню ліпідів у жировій тканині.
Таким чином, дієтична добавка «СТИФІМОЛ ПЛЮС», спираючись на наукове обґрунтування її складу, у комплексі з корекцією харчової поведінки та помірним фізичним навантаженням дозволяє ефективно зменшити вагу та нормалізувати обмінні процеси в організмі, тим самим покращити стан здоров’я людини.
Література:
1. Semwal RB, Semwal DK, Vermaak I, Viljoen A. A comprehensive scienti c overview of Garcinia cambogia. Fitoterapia 2015, 102: 134–48.

2. Rao GV, Karunakara AC, Babu RRS, Ranjit D, Reddy GC. Hydroxycitric acid lactone and its salts: Preparation and appetite suppression studies. Food Chem. 2010, 120:235–9.
3. Ranjith D, Shiva Prakash S, Karunakara AC, Diwakar L, Chandrasekara Reddy G. Issue of testicular toxicity of hydroxycitric acid lactone. Curr Sci 2011, 100: 24–7.
4. LimK, Ryu S, Nho H-S, Choi S-K, Kwon T, Suh H, et al. Hydroxycitric acid ingestion increases fat utilization during exercise in untrained women. J Nutr Sci Vitaminol 2003, 49: 163–7.


5. Anton SD, Shuster J, Leeuwenburgh C. Investigations of botanicals on food intake, satiety, weight loss and oxidative stress: Study protocol of a double-blind, placebo-controlled, crossover study. J Chin Integr Med. 2011, 9: 1190–8.

6. Blunden G. Garcinia extract inhibits lipid droplet accumulation without a ecting adipose conversion in 3 T3-L1 cells. Phytother Res 2001, 15: 172–3.
7. Oluyemi KA, Omotuyi IO, Jimoh OR, Adesanya OA, Saalu CL, Josiah SJ. Erythropoietic and anti-obesity e ects of Garcinia cambogia (bitter kola) in Wistar rats. Biotechnol Appl Biochem 2007, 46: 69–72.
8. Ramos RR, Saenz JF, Aguilar MCFA. Control of obesity with Garcinia cambogia extract. Invest Med Int 1996, 22: 97–100.
9. Hayamizu K, Ishii Y, Kaneko I, ShenM, Okuhara Y, Shigematsu N, et al. E ects of Garcinia cambogia (hydroxycitric acid) on visceral fat accumulation: a double-blind, randomized, placebo-controlled trial. Curr er Res Clin Exp 2003, 64: 551–67.

10. Patkowska-Sokola PB, Bodkowski R, Jamroz D, Nowakowski P, Lochynski S, Librowski T. L-Carnitine — Metabolic Functions and Meaning in Humans Life. Jolanta Current Drug Metabolism, 2011, 12, 667-8.
11. Gnoni A, Longo S, Gnoni GV, Giudetti AM. Carnitine in Human Muscle Bioenergetics: Can Carnitine Supplementation Improve Physical Exercise? Molecules 2020, 25 (1): 182. https://doi.org/10.3390/ molecules25010182
12. Madsen DKL, Preisler N, Rasmussen J, Hedermann G, Olesen JH, Lund AM, Vissing J. L-Carnitine Improves Skeletal Muscle Fat Oxidation in Primary Carnitine. J Clin Endocrinol Metab, 2018, 103 (12): 4580–88.
13. L-Tyrosine. Alternative Medicine Review 2007, 12 (4): 364-368. PMID: 18069906
14. Kotha RR, Luthria DL. Curcumin: Biological, Pharmaceutical, Nutraceutical, and Analytical Aspects. Molecules 2019, 24(16): 2930. https://doi.org/10.3390/molecules24162930
15. Arun N., Nalini N. Ecacy of turmeric on blood sugar and polyol pathway in diabetic albino rats. Plant Foods Hum. Nutr. 2002, 57: 41–52.
16. Murugan P, Pari L. In uence of Tetrahydrocurcumin on Hepatic and Renal Functional Markers and Protein Levels in Experimental Type 2 Diabetic Rats. Basic Clin. Pharmacol. Toxicol. 2007, 101: 241–5.
17. Pagano E., Romano B, Izzo AA, Borrelli F. e clinical ecacy of curcumin-containing nutraceuticals: An overview of systematic reviews. Pharmacol. Res. 2018, 134: 79–91.
18. Pala R, Sari MA, Erten F, Er B, Tuzcu M, Orhan C, Deeh PBD, Sahin N, Cinar V, Komorowski JR, Sahin K. e e ects of chromium picolinate on glucose and lipid metabolism in running rats. J Trace Elem Med Biol. 2020, 58: 126434. doi: 10.1016/j.jtemb.2019.126434.
52 Журнал «Сучасна фармація» • modern-pharmacy.com.ua • 2023 / лютий • Арсенал знань • Експертна думка
СТИль, ФІгура, МОЛодість



ПЛЮС Здоров'я!
Інформація про лікарський засіб призначена для поширення серед медичних і фармацевтичних працівників на спеціалізованих семінарах, конференціях, симпозіумах з медичної тематики. www.vitamin.com.ua

NEW
З настанням холодів більшість батьків
занепокоєні щодо частих захворювань
на ГРВІ у своїх дітей. Здається, що
боротьба з застудою нескінченна. Як
тільки закінчується одна інфекція —

починається інша. Будь-які люблячі
батьки будуть хвилюватися за стан
здоров’я своєї малечі, що призводить
до постійних візитів як до лікаря, так і
до аптеки.
Вивченню стану здоров’я дітей, що
часто хворіють, присвячено багато
робіт, тому що такі пацієнти найбільш
часто зустрічаються в педіатричній

практиці. Кількість таких дітей як
в Україні в цілому, так і в окремих
регіонах коливається в залежності
від віку та умов виховання від 15
до 75 % [1]. Найвищі показники
захворюваності у дітей до 5 років, які мають приблизно 3–8 вірусних
респіраторних захворювань на рік, тоді як підлітки хворіють приблизно
2–4 рази на рік.
Термін «часто хворіючі діти» (ЧХД)
з’явився у вітчизняній медичній
літературі в першій половині 80-х
років ХХ ст. Він не використовується
закордонними школами і, відповідно,

не входить до Міжнародної
класифікації хвороб. Діти, що
часто хворіють — це не діагноз, цей термін використовується для
виділення категорії дітей в нашій країні для подальшої профілактичної
спрямованості.
Як підтримати імунітет дитини
Надія Бойко, лікар загальної практики.
Чому діти часто хворіють?

Найчастіше захворювання у дітей проявляються у вигляді інфекцій верхніх дихальних шляхів (риніти, фарингіти, ларингіти) та нижніх відділів дихального тракту (трахеїти, бронхіти, пневмонія). Основною причиною частих інфекцій у дітей є те, що вони постійно стикаються з новими вірусами. Існує понад 200 вірусів, здатних спровокувати в організмі людини ГРВІ. Серед вірусних збудників найчастіше виділяють віруси грипу, парагрипу, риновіруси, аденовіруси та ін. Інша причина — це незрілість імунної системи. Під час захворювань організм дитини створює імунітет проти цих вірусів, але для цього потрібен час. Для формування імунітету до вірусів потрібно багато років.
ЦЕ ЦІКАВО!
До 6-місячного віку респіраторні інфекції у дітей зустрічаються рідко, що зумовлено дією трансплацентарного імунітету. У крові дитини ще присутні материнські антитіла, що забезпечують захист від широкого спектра інфекцій, імунітет яких виробився у матері протягом життя. У міру дорослішання дитини цей механізм захисту слабшає і починається напрацювання власних імунних реакцій.
Тому діти, які відвідують дитячий садок або дошкільний заклад, та ті, які мають старших братів чи сестер, є в групі ризику по частим захворюванням на ГРВІ. Взимку частота застудних захворювань збільшується втричі. Це пов’язано з багатьма факторами. З одного боку, тому що вони частіше залишаються в опалювальних, закритих приміщеннях з низькою вологістю і підхоплюють хвороби — наприклад, крапельні інфекції. З іншого боку, тому що наша імунна система слабкіше взимку — ми їмо менше свіжих продуктів, тим самим зменшуючи природне постачання вітамінів. Крім того, взимку ми проводимо менше часу на свіжому повітрі. До кінця зими запас вітаміну D виснажується, тому
застуди?
в період
A 54 Журнал «Сучасна фармація» • modern-pharmacy.com.ua • 2023 / лютий • Арсенал знань • Фармакотерапія
що нашій шкірі важко синтезувати новий через недостатню кількість сонячного світла. Крім того, наша імунна система природним чином піддається впливу холодних температур, снігу і дощу.


Враховуючи це одним з основних методів профілактики ГРВІ, є додаткова суплементація (призначення альтернативних джерел нутрієнтів) у дітей даної групи.
Тому саме вітамінні комплекси можна розглянути як додаткове джерело мікронутрієнтів. Доппельгерц Кіндер Мультивітамінний комплекс від компанії
Queisser Pharma ефективно відновить потребу організму в необхідних вітамінах та мінералах, які підтри-

мують імунну систему дитини та забезпечують опірність організму до інфекцій.
Доппельгерц Кіндер Мультивітамінний комплекс вражає своїм складом. Він містить 13 компонентів. Завдяки спеціально підібраній оптимальній формі ці компоненти забезпечують найкраще всмоктування та біодоступність і задовольняють добову потребу організму в основних мікроелементах. Слід відмітити, що даний вітамінний комплекс випускається у формі смачних желейних пастилок у вигляді ведмедиків, які дуже полюбляють діти. Без штучних барвників, консервантів, глютену та лактози.
До складу Доппельгерц Кіндер Мультивітамінний комплекс входять вітамін А, вітаміни групи В (В6, В12, фолієва кислота, пантотенова кислота, холін та ніацин), аскорбінова кислота, вітамін D, вітамін Е, біотин та мінерали — йод та цинк.
Вітамін А — це натуральний антиоксидант, який допомагає боротись з раковими клітинами, стимулює вироблення білих кров’яних тілець та антитіл, які захищають організм від інфекцій. Він допомагає лейкоцитам ефективніше боротись зі збудниками захворювань.
Вітамін С відіграє важливу роль у контролі інфекцій та є потужним антиоксидантом: нейтралізує вільні радикали і бере участь у виробленні колагену, необхідного для здоров’я кісток, зубів і кровоносних судин. Також він допомагає організму боротися з багатьма запальними та інфекційними процесами. Вітамін С стимулює вироблення білих кров’яних тілець, які захищають організм від інфекцій [2]. В 2019 р. був опублікований метааналіз, в якому оцінювалась ефективність використання вітаміну С для профілактики ГРВІ у дітей. Автори дійшли висновку, що прийом вітаміну С скорочує тривалість ГРВІ на 14 % і додавання цього препарату до схеми лікування ГРВІ у дітей є виправданим [3].
Схожим по функціям з вітаміном С є вітамін Е, який також є потужним антиоксидантом, що запобігає руйнуванню клітин під впливом вільних радикалів. Його рекомендують як для підвищення імунітету, так і для уповільнення розвитку хронічних захворювань.
Вітаміни групи В — це комплекс вітамінів, який допомагає перетворювати їжу в енергію, посилюючи захисні функції організму і сприяючи зміцненню імунітету. Також вони приймають участь у процесах метаболізму, в енергетичному обміні (перетворюють вуглеводи і жири в енергію), збереженні функцій мозку і печінки. Цинк один з елементів із великою кількістю функцій в нашому організмі. Адекватне надходження цинку має велике значення для належної роботи багатьох органів та систем. Крім того, відомо, що цинк модулює противірусний та антибактеріальний імунітет та регулює запальну реакцію. Поліпшення противірусного імунітету за допомогою цинку може відбуватися завдяки стимуляції продукції інтерферону α та підвищенню його противірусної активності. Цинк виявляє протизапальну активність та модулює функції Т-клітин, що може обмежити масштаби «цитокінового шторму». Покращений статус щодо цинку може також знизити ризик розвитку бактеріальної коінфекції. Цинк може мати захисний ефект як профілактична та допоміжна терапія при респіраторних вірусних інфекціях за рахунок зменшення вираженості запалення, поліпшення мукоциліарного кліренсу, профілактики ураження легень, модуляції противірусного та антибактеріального імунітету [4].
Арсенал знань
2023 / лютий
modern-pharmacy.com.ua

«Сучасна фармація»

•
•
Вітамін D необхідний не тільки для здоров’я кісток, але і для здоров’я імунної системи. Він активізує нашу імунну систему і виконує ключові функції в управлінні нею. •
Журнал 55
•
Фармакотерапія
Ліквідація дефіциту йоду — одна з найважливіших проблем людства, яку намагаються вирішити

протягом багатьох десятиліть, але вона залишається актуальною і сьогодні, особливо в таких екологічно небезпечних регіонах, як більша частина України
після чорнобильської аварії. Йод повинен надходити
в організм людини постійно протягом всього життя.
Основні функції йоду в організмі:
зміцнення імунної системи;
зниження ризику розвитку ракових захворювань;
зменшення концентрації в організмі важких металів і радіонуклідів;
регуляція розумового розвитку у дітей;
регуляція температурного режиму організму;

організація всіх життєво важливих процесів в організмі людини.
Мінерально-вітамінний комплекс Доппельгерц
Кіндер Мультивітамінний комплекс показаний всім
дітям:
при дефіциті на фоні незбалансованого харчування;

при порушенні всмоктування та засвоєння вітамінів та мінералів;
при підвищеній потребі у вітамінах та мінералах (значні фізичні та розумові навантаження, захворювання, травми, післяопераційні стани, рецидивні інфекційні захворювання, ГРВІ).
Яка роль вітаміну D в
Вітамін D — це жиророзчинний вітамін, який природним чином присутній у дуже малій кількості продуктів і доступний як дієтична добавка. Він також виробляється ендогенно, коли ультрафіолетові промені
сонячного світла потрапляють на шкіру і запускають
його синтез.
Дані досліджень свідчать, що значний відсоток осіб у популяції мають дефіцит або недостатність вітаміну
D. Причому їхня частота серед дітей та дорослих молодого і середнього віку однаково висока у всьому світі, і навіть високорозвинені країни не є винятком [6].
Хоча досліджень, у яких оцінювали рівень вмісту вітаміну D в організмі та поширеність його дефіциту, не дуже багато, проте вони переконливо доводять, що дефіцит вітаміну D може бути наявний у значного відсотка дітей і підлітків у Європі. Так, низький рівень вітаміну D у крові виявляється у 30–50 % дітей і підлітків [7]. Подібною є ситуація у США та інших країнах. Добре відомо, що вітамін D необхідний для нормального росту скелета й мінералізації кісток, а його недостатність спричинює рахіт. Це захворювання досить часто виявляється у дітей першого року життя. І профілактика рахіту за допомогою призначення вітаміну D є одним із пріоритетних напрямків охорони дитячого здоров’я у всьому світі. Проте часи,
Також терапевтичний ефект полівітамінів має інтегральний характер: покращується самопочуття, нормалізується сон, підвищується фізична та розумова працездатність, посилюється детоксикуюча, зовнішньосекреторна та білоксинтезуюча функція печінки. Отже, підвищується ще й неспецифічна резистентність організму, нормалізується імунний статус [5].
Тому Доппельгерц Кіндер Мультивітамінний комплекс можна сміливо рекомендувати всім дітям дошкільного та шкільного віку для збагачення щоденного раціону:
дітям від 3 до 7 років по 1 жувальній пастилці 1 раз на добу;
дітям старше 7 років по 1 жувальній пастилці 2 рази на добу.
підтримці імунітету?
коли вітамін D пов’язували тільки з рахітом, відійшли в історію. Дослідженнями підтверджено, що, крім здоров’я кісткової системи, вітамін D відповідає ще за низку ефектів в організмі. Вітамін D запускає модуляцію росту клітин, нервово-м’язової та імунної функції та зменшує активності запальних процесів. Багато генів, що кодують білки, які регулюють проліферацію клітин, диференціювання та апоптоз, частково модулюються вітаміном D. Зокрема, у немовлят, дітей і підлітків він запобігає таким станам/ захворюванням [7]:
м’язова слабкість;
інфекційні захворювання респіраторного тракту; алергічна патологія;
цукровий діабет 1 типу; серцево-судинні захворювання.
Також вітамін D здатний індукувати продукцію антимікробних пептидів — низькомолекулярних захисних пептидів з активністю широкого спектра дії проти бактерій, вірусів та грибів. Кателіцидин та дефензин — це дві основні групи епідермальних антимікробних пептидів, які, як повідомляється, індукуються вітаміном D в імунних клітинах та в багатьох інших клітинах поза імунною системою.

56 Журнал «Сучасна фармація» • modern-pharmacy.com.ua • 2023 / лютий • Арсенал знань • Фармакотерапія
Клінічні дослідження показали, що додатковий прийом вітаміну D знижує ризик розвитку гострих респіраторних інфекцій, при цьому, що не дивно, найбільший ефект від його застосування виявлено в осіб із дефіцитом вітаміну D [8]. Доведено, що вітамін D виявляє імуномодулюючий ефект, впливає на функціонування ряду клітин імунної системи, а також, що дуже важливо, знижує рівень секреції прозапальних цитокінів [9].
Основним джерелом вітаміну D для більшості людей будь-якого віку є його утворення під впливом на шкіру сонячних променів, як правило, протягом 1000–1500 годин навесні, влітку і восени. Зміна зенітного кута сонця залежно від географічної широти, пори року або часу доби суттєво впливає на синтез вітаміну D. У місцевостях з широтою вище і нижче 33° вироблення вітаміну D в шкірі відбувається з дуже низькою інтенсивністю, а пізньої осені та взимку практично не відбувається.
Іншим джерелом вітаміну D є харчові продукти. Проте слід відзначити, що цей вітамін містять не так вже й багато природних продуктів. З огляду на те, що сонячне світло та природні харчові продукти переважно не забезпечують повною мірою організм вітаміном D, доцільним є його додатковий прийом.

Доппельгерц Kinder



Вітамін Д3 №30
ЦЕ ЦІКАВО!
У США і Канаді вітаміном D збагачують молоко, а також деякі хлібобулочні вироби, апельсиновий сік, крупи, йогурти, сири. У більшості країн
Європи молоко не збагачують
вітаміном D, оскільки в 1950
р. стався спалах інтоксикації
вітаміном D у дітей раннього
віку, внаслідок безконтрольного
споживання цих продуктів.
Тому були прийняті закони, що забороняють збагачення
продуктів харчування
вітаміном D.
Тому найоптимальнішим варіантом забезпечення достатнього вмісту вітаміну D є вживання спеціальних препаратів, які є на фармацевтичному ринку. Завдяки унікальній формі вітамінів Доппельгерц, у вигляді желейних пастилок зі смаком зеленого яблука, прийом вітамину D3 став простішим та приємнішим для дітей. Прийом Доппельгерц актив Kinder Вітамін D3 здатний задовольнити потреби дитячого організму в вітаміні D. З метою профілактики дефіциту вітаміну рекомендовано приймати Доппельгерц актив Kinder Вітамін D3 всім дітям дошкільного та шкільного віку для збагачення щоденного раціону:
дітям від 3 до 7 років по 1 жувальній пастилці 1 раз на добу;
дітям старше 7 років по 1 жувальній пастилці 2 рази на добу.
ЦЕ ЦІКАВО!
Вітамін D може використовуватися задля профілактики COVID-19, а також у складі комплексного лікування пацієнтів на початку прогресування коронавірусної інфекції.
Дослідження свідчать про те, що вірус SARSCov-2 потрапляє в клітини організму людини та з часом спричиняє гострий респіраторний дистрес-синдром. Водночас вітамін D відновлює баланс атакованої вірусом ренін-ангіотензинової системи (РАС). І навпаки, хронічний дефіцит вітаміну D викликає фіброз легенів через вплив на РАС. Окрім цього, вітамін D підвищує імунітет і зменшує запальну реакцію та ризики виникнення гострої інфекції дихальних шляхів [10]. Проте дане питання потребує додаткових досліджень.
• Фармакотерапія
Арсенал знань
•
2023 / лютий
•
modern-pharmacy.com.ua

•
Журнал «Сучасна фармація»
АКЦІЯ ЗА ЦІНОЮ УПАКОВКИ
57
Вплив омега-3 на дитячий організм щують функціонування рецепторів, розташованих на мембранах нейронів. Саме тому омега-3 вкрай необхідні для розвитку головного мозку плода і в ранньому дитячому віці.
Омега-3 абсолютно незамінні для нормального функціонування організму. Традиційно вони відомі завдяки істотному впливу на систему гемостазу. Завдяки основоположній ролі омега-3 статус за цими кислотами у матері і дитини є важливим фактором, що визначає здоров’я дитини в період раннього дитинства і в подальшому житті.
Омега-3 виявляють багато різних клінічних ефектів. Так, відомо, що достатня забезпеченість омега-3 є обов’язковою умовою для інтелектуального розвитку дитини. Омега-3 поглинаються мембранами нейронів, забезпечуючи передачу імпульсів між ними, і покраАльфа-лінолева кислота (АЛК). Вона міститься в рослинній їжі, наприклад, в насінні чіа та льону, а також таких рослинних оліях як конопляна, обліпихова, гірчична. Докозагексаєнова кислота (ДГК). Ця речовина є одним з основних елементів ліпідів. ДГК міститься в мембрані клітин мозку, сітківки ока та відіграє важливу роль для зорової функції та у когнітивному розвитку. Деякі вчені називають її найціннішою із трьох
До складу Омега-3 входять три важливі
Слід зазначити, що позитивний вплив омега-3 при синдромі гіперактивності та дефіциту уваги особливо важливий для нормального розвитку когнітивних здібностей дитини, оскільки збереження уваги є обов’язковою умовою для підтримки процесів мислення [11]. Дефіцит уваги і гіперактивність впливають на здатність дитини до навчання.
поліненасичені жирні кислоти, а саме:
поліненасичених кислот Омега-3. Основна група продуктів, в якій вона є — риба жирних сортів. Ейкозапентаєнова кислота (ЕПК). Споживання її знижує ризик розвитку захворювань судин та серця, наприклад, гіпертензії, ішемічної хвороби. Крім того, ЕПК сприяє зниженню кількості шкідливого холестерину в організмі. Ейкозапентаєновою кислотою багате м’ясо холодноводних риб (палтус, лосось, оселедець, скумбрія).
Зниження рівня дієтарної ДГК пов’язують з порушеннями когнітивних здібностей і поведінки у дітей, особливо якщо недостатнє споживання омега-3 припадає на ранній вік дитини, коли головний мозок активно розвивається.
Омега-3 підвищує імунітет, поліпшує опірність організму вірусних та бактеріальних захворювань, а також негативних впливів навколишнього середовища.
Позитивний ефект досягається за рахунок наступних
функцій:
підвищення активності лейкоцитів в боротьбі з чужорідними клітинами;
участь у формуванні клітинної мембрани;
підвищення захисту дихальних шляхів при попаданні в них хвороботворних мікроорганізмів.
Звичайно, Омега-3 надходить в організм людини з продуктами харчування, жирними видами риб та насінням деяких рослин, проте найчастіше цієї кількості недостатньо. Не кожна людина їсть 2–3 рази на тиждень рибу, а при деяких станах потреба в комплексі жирних поліненасичених кислот збільшується.

ЦЕ ВАЖЛИВО!
Вчені встановили, що навіть у відносно
забезпечених країнах (Франція, Німеччина, інші

країни Західної Європи, Австралія) значна частина
населення споживають їжу з низьким вмістом
найбільш важливих поліненасичених жирних
кислот — докозагексаєнової і ейкозапентаєнової.
Саме тому Омега-3 рекомендують приймати у формі біологічно активних добавок, які можна придбати у будь-якій аптеці. Тому вітамінно-мінеральний комплекс Доппельгерц Kinder Омега-3, який містить достатню кількість ПНЖК Омега-3 і додатково збагачений вітамінами А, D і Е, важливими для зростання і розвитку дитини.
Може бути рекомендований дітям з 7 років.
Основні компоненти Доппельгерц Kinder Омега-3 мають різнонаправлену дію: сприятливо впливають на нервову систему і зір дитини. Омега-3 входить до складу сірої речовини головного мозку. Ці поліненасичені жирні кислоти забезпечують нормальне харчування всіх клітин організму, допомагають у передачі нервових імпульсів, що важливо для правильної роботи всієї нервової системи, в тому числі і для зору.

покращують здібності до читання та письма і концентрацію уваги. Брак Омега-3 в раціоні може навіть сприяти розвитку у дитини розладом дефіциту уваги та гіперактивності (РДУГ).
захищають серцево-судинну систему дитини, сприяють зниженню рівня холестерину (особливо в тих випадках, якщо дієта незбалансована)
підвищують імунітет, що особливо важливо в період адаптації до школи і в сезони респіраторних інфекцій.
58 Журнал «Сучасна фармація» • modern-pharmacy.com.ua • 2023 / лютий • Арсенал знань • Фармакотерапія
Ще з радянських часів лікарі знали про важливість ПНЖК для укріплення організму дитини. Тому майже всі діти того часу мають неприємні спогади, коли доводилось приймати риб’ячий жир. Часи змінилися, проте не змінилась думка про необхідність додаткового споживання ПНЖК. Капсули Доппельгерц Kinder Омега-3 вкриті желатиновою капсулою та не мають неприємного смаку, що є неодмінною перевагою для дітей. Доппельгерц Kinder Омега-3 рекомендовано приймати дітям з 7 років по 2 капсули на добу.
Осінньо-зимово-весняний період — це справжнє
випробування на міцність для багатьох із нас. І йдеться
не лише про погану погоду та традиційне зростання
захворюваності на застуду та грип. Нестача вітамінів і
мікроелементів є дуже поширеною проблемою в цей період, коли доступність фруктів і овочів знижується. Тому доцільність призначення вітамінно-мінерального комплексу від компанії
Queisser Pharma має розглядатися індивідуально при кожному візиті дитини до лікаря або при зверненні до провізора.
Доброго дня! Чим я можу Вам допомогти?
Доброго дня! Моя донька ходить в садочок, але з приходом холодів вона почала дуже часто хворіти. Чи можете Ви порекомендувати якісь дієві вітаміни, щоб укріпити імунітет дитини?
Скільки років Вашій дитині і чи має вона якісь хронічні захворювання?
Їй 4 роки і вона не має хронічних захворювань!
Тоді можу Вам порекомендувати Доппельгерц Кіндер мультивітамінний комплекс від німецького виробника Queisser Pharma, який містить 13 компонентів. У період адаптації до школи і дитячого садка багато дітей часто хворіє. Нерідко причиною цьо-
Література:
1. Макарова З.С. Часто болеющие дети и их реабилитация в условиях детской поликлиники // Поликлиника. – 2005. – № 1. – С. 14-16.
2. Huijskens MJ, Walczak M, Koller N, et al. Technical advance: ascorbic acid induces development of double-positive T cells from human hematopoietic stem cells in the absence of stromal cells. J Leukoc Biol. 2014;96(6):1165-1175. doi:10.1189/jlb.1TA0214-121RR
3. Vorilhon P., Arpajou B., Vaillant Roussel H., Merlin É., Pereira B., Cabaillot A. E cacy of Vitamin C for the Prevention and Treatment of Upper Respiratory Tract Infection. A Meta-Analysis in Children. Eur J Clin Pharmacol. 2019;75(3):303–311. doi: 10.1007/s00228-018-2601-7.



4. Skalny AV, Rink L, Ajsuvakova OP, Aschner M, Gritsenko VA, Alekseenko SI, Svistunov AA, Petrakis D, Spandidos DA, Aaseth J, Tsatsakis A, Tinkov AA. Zinc and respiratory tract infections: Perspectives for COVID-19 (Review). Int J Mol Med. 2020 Jul;46(1):17-26. doi: 10.3892/ijmm.2020.4575. Epub 2020 Apr 14. PMID: 32319538; PMCID: PMC7255455.
5. Максимович Я.Б., Кресюн В.И. Витаминные препараты // Справочник по клинической фармакологии и фармакотерапии / Под ред. И.С. Чекмана и др. — К.: Здоров’я, 1986. — С. 423–448.
го стає брак вітамінів. Завдяки спеціально підібраній оптимальній формі ці компоненти забезпечують найкраще всмоктування та біодоступність, задовольняють добову потребу організму в основних мікроелементах, які підтримують імунну систему дитини та забезпечують опірність організму до інфекцій.
Як приймати даний комплекс?
Доппельгерц Кіндер мультивітамінний комплекс дуже зручний у використанні — дітям від 3 до 7 років по 1 жувальній пастилці 1 раз на добу. Слід відмітити, що даний комплекс випускається у вигляді смачних желейних пастилок у формі ведмедика, які так полюбляють діти.
Дякую Вам за рекомендацію! Це те, що нам потрібно!
ГАРНОГО ДНЯ! БУДЬТЕ ЗДОРОВІ!
6. Диагностика, лечение и профилактика дефицита витамина D. Рекомендации Американского общества эндокринологов (2011 г.). Дитячий лікар. 2012; 5: 67-76.
7. Braegger C., Campoy C., Colomb V. et al.; ESPGHAN Committee on Nutrition. Vitamin D in the healthy European paediatric population. J Pediatr Gastroenterol Nutr. 2013; 56 (6): 692-701.




8. Martineau AR, Jolli e DA, Hooper RL, et al.. Vitamin D supplementation to prevent acute respiratory tract infections: systematic review and metaanalysis of individual participant data. BMJ. 2017 Feb 15;356:i6583. doi: 10.1136/ bmj.i6583. PMID: 28202713; PMCID: PMC5310969.
9. Sassi F, Tamone C, D’Amelio P. Vitamin D: Nutrient, Hormone, and Immunomodulator. Nutrients. 2018 Nov 3;10(11):1656. doi: 10.3390/nu10111656. PMID: 30400332; PMCID: PMC6266123.
10. Arboleda, J. F., Urcuqui-Inchima, S. (2020). Vitamin D Supplementation: A Potential Approach for Coronavirus/COVID-19 erapeutics? Frontiers in Immunology, 11. doi:10.3389/ mmu.2020.01523
11. Cheng, Yu-Shian et al. “Supplementation of omega 3 fatty acids may improve hyperactivity, lethargy, and stereotypy in children with autism spectrum disorders: a meta-analysis of randomized controlled trials.” Neuropsychiatric disease and treatment vol. 13 2531-2543. 4 Oct. 2017, doi:10.2147/NDT.S147305
АЛГОРИТМ ДІЙ ПРОВІЗОРА:
Журнал «Сучасна фармація» • modern-pharmacy.com.ua • 2023 / лютий • Арсенал знань • Фармакотерапія 59
Особливістю медичної та фармацевтичної
професії є навчання впродовж усього періоду професійної діяльності. Дипломований
фахівець має регулярно поглиблювати

професійні знання, підвищуючи кваліфікацію
на циклах тематичного удосконалення або
інших заходах безперервного професійного розвитку (БПР) або проходячи післядипломну підготовку на циклах спеціалізації (здобуття вторинної спеціальності).
Для удосконалення системи післядипломної освіти та БПР медичних і фармацевтичних фахівців було затверджено відповідний наказ. Ця вимога поширюється не лише на лікарів та фармацевтів зі ступенем магістра, але й на медсестер, акушерок, фельдшерів, асистентів фармацевтів, лаборантів та зубних техніків, які мають ступінь фахового молодшого бакалавра, молодшого бакалавра або бакалавра. Медсестри також можуть здобувати ступінь магістра.
Наказ МОЗ № 198 від 7 вересня 1993 року «Про підвищення кваліфікації молодших спеціалістів з медичною та фармацевтичною освітою» вже не відповідав сучасним вимогам освітнього законодавства та тенденціям розвитку медичних і фармацевтичних професій.
Для удосконалення системи післядипломної освіти та БПР медичних і фармацевтичних фахівців було затверджено Наказ МОЗ України
від 10 листопада 2022 року №
2016 «Про подальше удосконалення системи післядипломної освіти та безперервного професійного розвитку
фахівців з фаховою передвищою, початковим рівнем (короткий цикл) та першим (бакалаврським) рівнем вищої медичної і фармацевтичної освіти та магістрів з медсестринства», зареєстрований у Міністерстві юстиції України.
Наказом № 2016 врегульовано порядок проходження циклів спеціалізації (за фахом та профілем роботи) та циклів тематичного удосконалення для даної категорії фахівців, затверджено переліки таких циклів.
Під час формування переліків враховувалися сучасні потреби галузі охорони здоров’я та пропозиції, що надходили від професійних спільнот під час громадського обговорення проєкту наказу.
Планування циклів спеціалізації та циклів тематичного удосконалення закладами фахової передвищої/вищої (післядипломної) освіти будуть розміщувати перелік назв циклів спеціалізації і тематичного удосконалення на своїх вебсайтах. Цикли спеціалізацій будуть проводитися у закладах фахової передвищої/вищої (післядипломної) освіти та включають 2 частини: теоретичну та практичну, а також лабораторні заняття.



В УКРАЇНІ УДОСКОНАЛЮЮТЬ
СИСТЕМУ ПІСЛЯДИПЛОМНОЇ ОСВІТИ ТА БЕЗПЕРЕРВНОГО ПРОФЕСІЙНОГО РОЗВИТКУ
ФАРМАЦЕВТИЧНИХ ТА
60 Журнал «Сучасна фармація» • modern-pharmacy.com.ua • 2023 / лютий • Арсенал знань • Новини
МЕДИЧНИХ ФАХІВЦІВ
Теоретичні заняття передбачатимуть обов’язкову особисту участь фахівців із медичною чи фармацевтичною освітою у місці їх проведення та/або дистанційну участь у режимі реального часу. Проєктом визначається, що дистанційне навчання має становити не більше 50 % усього циклу.
Що стосується практичних і лабораторних занять, то вони передбачатимуть лише особисту присутність
фахівців із медичною чи фармацевтичною освітою в симуляційно-тренінгових (тренінгових) центрах закладів фахової передвищої/вищої (післядипломної)



освіти, а також у закладах охорони здоров’я.
Окрім того, фахівці з фармацевтичною освітою матимуть право проходити спеціалізацію з кількох спеціальностей за наявності виробничої необхідності.
Також передбачається й можливість відновлення фармацевтичної практики фахівцем з відповідною освітою у разі, якщо він не працював більше 5 років за спеціальністю. Для цього потрібно повторно пройти у відповідних закладах цикли спеціалізації.
Щодо проходження циклів тематичного удосконалення, то, як і проходження циклів спеціалізації, вони передбачатимуть обов’язкову особисту присутність медичного або фармацевтичного працівника у місці їх проведення та/або дистанційну участь у режимі реального часу. Вони проводитимуться у формі виїзних циклів, тобто поза відповідними закладами освіти. Тривалість циклу тематичного удосконалення буде визначатися навчальним планом і програ-
мою такого циклу та складатиме 45–75 навчальних годин.
Тривалість циклу тематичного удосконалення визначається навчальним планом і програмою такого циклу та буде складати 45–75 навчальних годин.
Перелік циклів тематичного удосконалення передбачає список із 54 позицій, який також включає спеціальність «Фармація».
Стосовно ж Переліку циклів спеціалізації, то він передбачає: 16 спеціалізацій за фахом, серед яких «Фармація» (при перериванні стажу), передбачений контингент слухачів — асистенти фармацевтів; 18 спеціалізацій за профілем роботи. До переліку також внесено спеціальність «Фармація». Контингент слухачів — асистенти фармацевтів, а отримана спеціальність після прослуховування циклу спеціалізацій — лаборант («Фармація»).
Переліки циклів тематичного удосконалення не є вичерпними, тому заклади освіти у межах своєї автономії можуть змінювати та розширювати їх.
Особливої уваги заслуговує запровадження циклу спеціалізації за фахом «Фізична та реабілітаційна медицина» для підготовки медичних сестер з реабілітації — нової професії у галузі охорони здоров’я. Також впроваджуються цикли тематичного удосконалення з таких актуальних в умовах воєнного часу напрямів, як «Догляд за ранами» та «Психологічні і духовні аспекти сестринського догляду».

Концепція розвитку післядипломної освіти медичних та фармацевтичних фахівців, а також забезпечення їх неперервного навчання спрямовані на підвищення якості підготовки, інтеграцію медичної і фармацевтичної освіти та науки, вирішення кадрових проблем галузі з урахуванням потреб охорони здоров’я України, покращання медичної та фармацевтичної допомоги населенню, впровадження формулярної системи постачання, створення єдиного інформаційного простору у фармації, застосування фармакоекономічних підходів до раціонального використання ліків для підвищення якості життя населення та сприяння конкурентоспроможності фахівців із вищих навчальних закладів на вітчизняному та міжнародному ринках праці.
За матеріалами https://zakon.rada.gov.ua

Журнал «Сучасна фармація» • modern-pharmacy.com.ua • 2023 / лютий • Арсенал знань • Новини 61
c.63
Розкриття секретів вірулентності
Streptococcus A
c.64
Сучасні погляди на лікування міом. Досвід Ніжинського міського
пологового будинку
c.68
Міжнародний день жінок і дівчат у науці
c.72
Температура нашого тіла знижується, і причиною можуть бути кишкові бактерії
c.74
Українських ліків у Європі стане більше: «Фармак» будує завод в Іспанії
У Великобританії з’являться нові лікарські засоби від «Фармак»
c.76
Cхвалено перший генний препарат для лікування пацієнтів
з гемофілією В
Summum bonum medicīnae sanĭtas
Найвище благо медицини – здоров’я

У СВІТІ МЕДИЦИНИ У СВІТІ МЕДИЦИНИ
STREPTOCOCCUS A



Інвазивні стрептококові захворювання стають причиною понад 163 000 смертей щороку
в усьому світі, а останнім часом спостерігається збільшення випадків саме інвазивної форми стрептококу у Вікторії та Новому Південному Уельсі.
Протягом останніх 10 років доцент Інституту глікоміки Маніша Панді та професор Майкл Гуд досліджували шляхи, якими Streptococcus A може поширюватися організмом. За словами доцента Панді, висновки щодо цього дослідження матимуть далекосяжні наслідки, оскільки стрептокок А є причиною значної кількості інвазивних і неінвазивних інфекцій, які спричиняють значну захворюваність і смертність у всьому світі. Причина цього полягає в тому, що інвазивні організми експресують значно більше токсину, стрептолізину O (SLO), який був основним предметом цього дослідження. SLO виявляє потужну руйнівну дію на клітини та тканини та сприяє резистентності стрептококу А до лейкоцитів, що є критично важливим першим елементом захисту від інвазивної інфекції стрептококу А.
За словами професора Гуда та його команди, вони виявили, що SLO змінює взаємодію з популяціями клітин-господарів і підвищує життєздатність Streptococcus
A в таких місцях тіла, як кров і селезінка, і що його відсутність призводить до значно меншої вірулентності. По суті, чим менше присутній SLO, тим менш важкий випадок Streptococcus A. SLO секретується майже всіма ізолятами Streptococcus A, але ті, які виділяють найбільше SLO, є найбільш патогенними.
Ця робота підкреслює важливість значення SLO у вірулентності стрептококу А, підкреслюючи складний характер патогенезу стрептококу А.
Це покращене уявлення про взаємодію хазяїнпатоген дозволить краще зрозуміти механізми ухилення від імунітету хазяїна та створюватиме сприятливі умови для розробки стрептококової вакцини.
Доктор Панді сказав, що ключовим висновком є те, що присутність SLO в організмі людини не погіршує здатність реагувати на вакцину від Streptococcus A, розробленого Інститутом глікоміки Університету Гріффіт і яка зараз проходить клінічні випробування.
Стрептокок А може спричиняти низку захворювань, в тому числі імпетиго (шкірна інфекція), він уражає горло та може спричинити скарлатину. У важких випадках бактерія може потрапити в кров, викликати сепсис та смерть.
Дуже рідко стрептокок спричиняє інвазивну смертельно небезпечну інфекцію групи А або iGAS з ураженням внутрішніх органів.
Шлях передавання стрептококової інфекції групи A здебільшого повітряно-краплинний. Під час кашлю, чхання, інколи — розмови хворого збудник проникає в організм здорової людини через слизову оболонку верхніх дихальних шляхів, мигдаликів. Джерелом інфекції є люди, хворі на тонзиліт, скарлатину та інші клінічні форми респіраторної або шкіряної стрептококової інфекції, а також бактеріоносії стрептокока. Тривалість заразного періоду хворих на гостру стрептококову інфекцію переважно залежить від способу та ефективності їх лікування.
Агентство безпеки охорони здоров’я Сполученого Королівства (UKHSA) заявило, що у 2022 році показники захворювання стрептококом А вищі, ніж у попередні два.
Зростання випадків, ймовірно, є наслідком скасування заходів, які впроваджувалися під час пандемії COVID.
Розумні запобіжні заходи, такі як регулярне миття рук і невідвідування публічних місць під час хвороби, можуть зменшити ризик інфікування.
Джерело: https://www.sciencedaily.com



РОЗКРИТТЯ СЕКРЕТІВ ВІРУЛЕНТНОСТІ
Журнал «Сучасна фармація» • modern-pharmacy.com.ua • 2023 / лютий • У світі медицини • Цікаво 63
СУЧАСНІ ПОГЛЯДИ НА ЛІКУВАННЯ МІОМ:
з
досвіду
Ніжинського міського
пологового будинку

МІОМА МАТКИ — одне з найпоширеніших
захворювань жінок дітородного віку. За
статистичними даними з різних джерел, на цю недугу хворіє до 40 % жінок, але насправді цей показник суттєво

занижений, бо часто захворювання
на міому проходить
безсимптомно або маскується
під інші хвороби, і жінки просто
не звертаються до лікаря.
Найчастіше у своїй практиці маємо справу з лейоміомами. Лейоміома матки за частотою є однією із найбільш поширених пухлин жіночої репродуктивної системи. За статистичними даними, у кожної
4–5-ї жінки діагностують лейоміому матки, частота
якої у жінок віком до 35 років сягає 50 %, а за даними автопсії — приблизно 80 %. Значна кількість оперативних втручань, які проводяться в гінекологічному відділенні КНП «Ніжинський міський пологовий будинок», припадає саме на операції з приводу лейоміом матки.
Лейоміоми: фактори виникнення
новоутворень, симптоматика та методи діагностики
Лейоміома матки — це доброякісне новоутворення тіла матки, що складається переважно з гладком’язових клітин. Етіологічних чинників виникнення лейоміоми матки існує багато, єдиної теорії виникнення захворювання немає. Серед патогенетичних
факторів виникнення лейоміоми виділяють гормо-


Валерій Якуба, генеральний директор КНП «Ніжинський міський пологовий будинок» Ніжинської міської ради Чернігівської області, Заслужений лікар України, кандидат медичних наук;
нальні порушення, генетичні компоненти, інфекції, травми. Клінічні прояви міоми матки варіюють від безсимптомного перебігу до больового і геморагічного синдромів, симптомів здавлення прилеглих органів, розвитку маткових кровотеч, які призводять до тяжкої анемії. Характер клінічних проявів значно залежить від розташування вузлів лейоміоми тіла матки відносно порожнини матки (субмукозні, інтрамуральні, субсерозні), а також від їхньої кількості, розмірів та кровопостачання. Імовірність малігнізації лейоміом матки складає 1 %.
Сучасна діагностика лейоміоми базується на даних анамнезу, бімануального гінекологічного огляду, ультразвукового дослідження, а у деяких випадках — магнітно-резонансної та комп’ютерної томографії, гістеро- та лапароскопії [1].
Консервативне лікування лейоміом Міоми (лейоміоми) лікуються як консервативно, так і оперативно. Вибір тактики лікування залежить від локалізації, розмірів пухлини, кількості вузлів (вогнищ), супутніх захворювань, віку пацієнтки та бажання жінки зберегти репродуктивну функцію [2]. Хворі з лейоміомою матки, що не супроводжується симптоматикою (біль, мено- і метрорагія, порушення функції суміжних органів, безпліддя, невиношування вагітності) та не має тенденції до росту пухлини,

64 Журнал «Сучасна фармація» • modern-pharmacy.com.ua • 2023 / лютий • У світі медицини • Рекомендації спеціалістів
не потребують оперативного лікування, а знаходяться
під динамічним контролем лікаря акушера-гінеколога
один раз на рік. Надалі такі пацієнтки повинні бути обстежені для виявлення причини розвитку лейоміоми.
Зважаючи на те, що лейоміома —
це гормонозалежна пухлина, призначення гормональної терапії для лікування даної патології має на меті: послаблення чи зняття патологічних
симптомів, зменшення росту та зниження об’єму крововтрати [3].
В залежності від клінічної ситуації для досягнення цих результатів призначаються естроген-гестагенні препарати, прогестини, антагоністи Гн-РГ, антагоністи гонадотропінів, внутрішньоматкова система «Мірена». До методів негормональної терапії відносять симпто-

матичне лікування, яке включає застосування гемостатиків (при кровотечі) та спазмолітиків, нестероїдних протизапальних (при больовому синдромі), антианемічних препаратів, седативних засобів [3].
Однак, консервативну терапію лейоміоми матки не слід розглядати як альтернативу хірургічному лікуванню даного захворювання. Якщо є показання для оперативного лікування, то необхідно проводити хірургічне втручання, не гаючи часу і коштів на лікування, яке імовірніше за все буде чи неефективним, чи дасть тимчасове поліпшення.
Комбінована терапія лейоміоми включає в себе хірургічне лікування в об’ємі консервативної міомектомії на фоні медикаментозної терапії, а саме використання Гн-РГ в до- та післяопераційному періоді. В нашому закладі з цією метою використовується препарат «Есмія» фірми «Гедеон Ріхтер», який достатньо ефективний, але дороговартісний.
Хірургічне лікування лейоміоми (міоми)
Розв’язання питання про необхідність оперативного втручання та вибір між екстирпацією матки та міомектомією залежить від локалізації, розмірів, кількості вузлів (вогнищ), віку пацієнтки та бажання жінки зберегти репродуктивну функцію.
Показання до хірургічного лікування:
Симптомна: геморагічний синдром — рясні та тривалі менструації (менорагія), ациклічні кровотечі (метрорагії); больовий синдром; хронічна анемія.
Розміри пухлини, які досягають або перевищують розміри 13-14 тижнів вагітної матки.
Наявність субмукозного вузла (проявляється масивними кровотечами, які призводять до хронічної анемії). При даній локалізації вузла матка не завжди матиме великі розміри.
Порушення живлення вузла (асептичний некроз).
Субсерозне розташування вузла на ніжці (можливий перекрут вузла).
Швидкий ріст пухлини (збільшення величини, що відповідає 4-5 тижням вагітності на рік і більше,
особливо у жінок в клімактеричному чи менопаузному періоді).
Атипова локалізація вузлів:
інтралігаментарне розташування, яке викликає біль, внаслідок здавлювання нервових сплетінь, порушення функції нирок при стисненні сечоводів;
шийкове розташування вузла, яке проявляється порушенням функції суміжних органів.
Лейоміома в поєднанні з передраковою патологією ендометрію, яєчників, випадінням матки.
Лейоміома матки як причина безпліддя та невиношування вагітності.
Класифікація хірургічного лікування лейоміоми:
Консервативне хірургічне лікування (органозберігаюча операція):
лапароскопічна міомектомія;
гістероскопічна міомектомія;
лапаротомія з міомектомією;
черезшкірна та черезкатетерна емболізація маткових артерій.
• Рекомендації спеціалістів
2023 / лютий
•
modern-pharmacy.com.ua



•
Журнал «Сучасна фармація»
У світі медицини 65
•
Лапароскопічна міомектомія проводиться жінкам, у яких розміри матки не більше, ніж це було б при 6-тижневої вагітності і які мають невелику кількість субсерозних вузлів.
Гістероскопічна міомектомія застосовується при видаленні підслизової або субмукозної міоми, що знаходиться в порожнині матки [4].
Під час проведення консервативної міомектомії жінкам з наявністю лейоміоми і фактором безпліддя проводиться розсічення й видалення злук органів черевної порожнини та органів малого таза, пластика


маткових труб, цистектомії при наявності кіст на яєчниках, вкорочення круглих маткових зв’язок, що надає матці положення ante exio anteversio. За рік в нашому закладі проводиться понад 70 таких операцій.




Емболізація маткових артерій є перспективним методом лікування симптомної лейоміоми матки при передопераційній підготовці до консервативної міомектомії з метою зменшення об’єму інтраопераційної крововтрати. Суть методу полягає в позбавленні кровопостачання міоматозних вузлів в матці за допомогою введення в судини, що живлять вузли, суспензії емболів — мікроскопічних полімерних кульок. Без кровопостачання вузли зменшуються в розмірі й заміщуються сполучною тканиною [5]. Але у зв’язку з високою вартістю цієї процедури, відсутністю необхідного обладнання для її проведення, високим ризиком тромбоемболічних ускладнень у жінок та відсутністю 100 % ефекту дана процедура в нашому закладі поки не проводиться.
РАДИКАЛЬНЕ ХІРУРГІЧНЕ

ЛІКУВАННЯ:
а) тотальна гістеректомія (екстирпація матки):
лапаротомічна;
трансвагінальна;
лапароскопічна;
б) субтотальна гістеректомія (надпіхвова ампутація матки):
лапаротомічна;
трансвагінальна;
лапароскопічна [6].
Лікарі КНП «Ніжинський міський пологовий будинок» Ніжинської міської ради володіють всіма вищеперерахованими видами оперативних втручань. Звичайно, що ми надаємо перевагу малоінвазивним методам хірургічного втручання. Однак лапароскопічна тотальна гістеректомія та лапароскопічна надпіхвова ампутація матки недостатньо себе виправдали у зв’язку з обмеженим доступом в черевну порожнину та порожнину малого таза, малорухливістю інструментів, що викликає збільшення тривалості операції та перебування жінки в наркозі. При тотальній гістеректомії й надпіхвовій ампутації матки відкритим доступом (лапаротомія по Пфанненштилю) в процесі перитонізації проводиться підшивання куксей маткових зв’язок до кукси піхви чи кукси шийки матки, що профілактично запобігає їх випадінню через піхву в майбутньому. На жаль, при проведенні даних операцій лапароскопічним доступом виконати таку фіксацію неможливо. В нашому закладі було проведено понад десяток операцій з приводу випадіння кукси піхви й шийки матки після видалення матки лапароскопічним шляхом, проведених в інших медичних закладах При виконанні лапаротомії є можливість більш ретельно провести ревізію органів черевної порожнини і порожнини малого таза з метою виявлення супутньої патології. При виявленні збільшення розмірів Дугласової кишені та ентероцеле є можливість проведення облітерації Дугласової кишені.
З НАШОГО ДОСВІДУ 66 Журнал «Сучасна фармація» • modern-pharmacy.com.ua • 2023 / лютий • У світі медицини • Рекомендації спеціалістів
Статистичні дані оперативних втручань КНП «Ніжинський міський пологовий будинок» з приводу лейоміоми за рік складає:
80 тотальних екстирпацій матки з додатками
лапаротомним доступом;
20 екстирпацій матки без додатків;
15 надпіхвових ампутацій матки з додатками;
20 надпіхвових ампутацій без додатків;
Різниця в кількості тотальних екстирпацій і надпіхвових ампутацій обумовлена віком жінки та фактом наявності діатермокоагуляцій чи діатермоконізацій шийки матки в анамнезі з приводу ерозії, чи дисплазії шийки матки. Ми вважаємо, що скомпрометовану шийку матки не варто залишати у зв’язку з високим ризиком виникнення раку кукси шийки матки в майбутньому.
Питання про видалення додатків матки в кожному окремому випадку вирішується індивідуально.
Ми враховуємо той факт, що з 45 до 50 років функція яєчників припиняється, у жінки наступає клі-
40 екстирпацій матки через піхву;
30 консервативних міомектомій;
30 операційних лапароскопій;
60 гістероскопій.
макс. Якщо яєчники змінені внаслідок наявності в них кіст (фолікулярних, ендометріоїдних, дермоїдних) чи фібром, то додатки в таких випадках після 45 років видаляються.
З метою замісної терапії при видаленні додатків в післяопераційному періоді жінкам на 2 місяці призначається замісна гормональна терапія (трансдермальний пластир «Естрамон», таблетки «Прогінова», спрей «Лензетто»).
У жінок, молодших 45 років, додатки при оперативному втручанні залишаються, з метою профілактики розвитку остеопорозу та посткастраційних розладів.
Об’єм операційних утручань при виявленні злоякісних новоутворень При виявленні злоякісних новоутворень під час оперативного втручання об’єм операції буде наступним:
При раку тіла матки проводиться тотальна екстирпація матки з додатками і видалення лімфатичних вузлів (якщо вони є) з параметральної
клітковини.
При раку шийки матки проводиться розширена екстирпація матки по
Вертгейму з тазовою, параметральною і паравагінальною клітковиною та верхньою третиною піхви.
При раку яєчників проводиться тотальна екстирпація чи надпіхвова
ампутація матки з додатками, резекція великого сальника. [7]
У зв’язку з ретельним обстеженням жінок в передопераційному періоді, таких операцій за останні 30 років було зроблено біля 50.
Своєчасне звернення до лікаря, рання діагностика та адекватне лікування дозволяє попередити малігнізацію фіброміоми (лейоміоми) матки в саркому (злоякісну пухлину), яка швидко метастазує. Навіть блискуче проведена операція по видаленню саркоми не дає жінці шансів прожити більше ніж п’ять років після оперативного лікування, а променева і хімієтерапія в цьому разі неефективна. Таких випадків за 30 років у нас було 5. Як це не прикро, але ці жінки після операції прожили не більше 5 років.
Профілактика міоми Профілактика міоми (фіброміоми, лейоміоми) матки полягає в регулярному відвідуванні лікаря-гінеколога (не рідше 1 разу на рік, бажаніше раз на півроку), щорічному УЗ-дослідженні, раціональному і збалансованому харчуванні з достатнім вмістом рослинних продуктів, профілактиці ожиріння і гіпертонічної хвороби, запобіганні розвитку гіперестрогенних станів (вчасній корекції порушень менструального циклу, ановуляції, діагностиці та лікуванні гіперплазії ендометрію) та небажаної вагітності [8]. І однозначно це реалізація репродуктивного потенціалу, бо для здоров’я жінки бажано народження не менше 3-х дітей.
Література:
1. О.В. Голяновський, О.Ю. Качур, М.А. Будченко, К.В. Супрунюк, С.В. Фролов. Лейоміома матки: сучасні аспекти клініки, діагностики та лікування./ Репродуктивне здоров’я жінки.-2021.- №5.-С 7–18. https:// doi.org/10.30841/2708-8731.5.2021.240017
2. Лейоміома матки. Стандарти медичної допомоги (затверджено наказом МОЗ України №147 від 25.01.2023 р.).
3. Антагонисты рецепторов прогестерона в структуре комплексного органосохраняющего лечения миомы матки / А. Л. Тихомиров, А. А. Леденкова, А. Е. Батаева, В. Г. Абышова / Акушерство и гинекология. — 2012. — № 5. — С. 115–119.
4. Голяновський О.В., Будченко М.А. Комплексна методика виконання консервативної міомектомії у жінок репродуктивного віку/Вісник
Вінницького національного медичного університету. -2017.- №1, Ч. 2 (Т.21).- С. 329-331.
5. Bendifallah S. Myomectomy for infertile women: the role of surgery /S. Bendifallah, J.L. Brun, H.J. Fernandez // Gynecol. Obstet. Biol. Reprod.2011. - Vol. 40 (8). - P. 885-901.



6. Запорожан В. М. Акушерство та гінекологія : національний підручник / В. М. Запорожан, Т. Ф. Татарчук, І. З. Гладчук ; за ред. В. М. Запорожана. — К. : ВСВ «Медицина», 2014. — Т. 4. — С. 290–321.
7. Бондар Г.В. Лекції з клінічної онкології: Навч. посіб./ Г.В. Бондар, Ю.В. Думанський, С.В. Антіпова, О.Ю. Попович [та ін.] — Луганськ: Луганська обласна друкарня, 2009. —С. 586.
8. Сучасні погляди репродуктолога на етіопатогенез і лікування лейоміоми матки / Н. В. Авраменко, Д. Є. Барковський, О. В. Кабаченко, Д. В. Лецин // Запорізький медичний журнал. — 2017. — Т. 19, № 3 (102). — С. 381–386.
Журнал «Сучасна фармація» • modern-pharmacy.com.ua • 2023 / лютий • У світі медицини • Рекомендації спеціалістів 67
modern-pharmacy.com.ua

11 відзначають ЛЮТОГО
день жінок і
дівчат у науці
Міжнародний
день жінок і дівчат у науці (International Day of Women and Girls in Science) — це молоде, але








досить важливе свято — як зазначено в резолюції 70-ї сесії Генеральної Асамблеї ООН від 22 грудня 2015 року. Заснуванню цієї дати передувала прийнята 20 грудня 2013 р. резолюція Генеральної
Асамблеї ООН «Наука, техніка та
інновації в цілях розвитку», в якій зазначався рівний доступ жінок
і дівчат будь-якого віку до досягнень і розвитку науки, техніки і
ЦІКАВІ ФАКТИ про жінок у науці
інновацій як запорука забезпечення гендерної рівноправності в даній сфері.
На портретах «видатних науковців» у шкільних чи університетських кабінетах ми бачимо переважно чоловіків. Історія жінок-науковиць — це не просто історія досягнень. Це історія спротиву та боротьби, історія, що існує «незважаючи на».
Жінки у науці в XXI столітті стикаються з дискримінацією та домаганнями. Жінки в галузях природничих, технічних, інженерних та математичних наук пу-
За даними Інституту статистики ЮНЕСКО, лише 28 % науковців у світі — жінки.
В Україні серед науковців — 45 % жінок.
Україна займає 12 МІСЦЕ за кількістю жінок-вчених в рейтингу серед 41 країни світу.
До першої п’ятірки країн ЄС з найбільшою кількістю жінок-науковців входять Литва, Болгарія, Латвія, Португалія й Данія.
У світі всього 13 % патентів на винаходи отримують жінки. Прогнозується, що гендерної рівності в області винаходів буде досягнуто лише в 2070 році.
Об’єднані Арабські Емірати, Іран, Узбекистан, Японія, Камерун, Саудівська Аравія — країни, в науці яких жінки мають найменше представництво.
блікують менше наукових праць, отримують менші виплати за свої дослідження і не просуваються кар’єрними сходами так, як чоловіки.
Після народження дитини жінки в науці частіше стикаються з дискримінацією. За довгі проміжки відсутності активної наукової діяльності деякі установи штрафують своїх співробітників, понижуючи їх рейтинг. В одному британському університеті дослідили це питання і виявилося, що 100 % оштрафованих науковців є саме мами з маленькими дітьми.
ЖІНКИ-НАУКОВЦІ, ЯКІ ЗМІНИЛИ ХІД ІСТОРІЇ Попри поширення фемінізму, боротьби за права жінок, все ж рівності між статями поки немає… І йдеться не лише про мусульманський світ, у цивілізованих країнах в науковому світі жінки радше рідкість, аніж норма. Попри це досягнення жінок не менш важливі за досягнення їхніх колег чоловічої статі. Жінки-дослідниці з’явилися не в останньому сторіччі, коли їхні права нарешті почали зрівнювати з правами чоловіків. У кожній епосі були свої видатні жінки-науковці.
Ïерша жінка-математик. Жінки почали займатися наукою ще з давніх часів, зокрема, Гіпатія Олександрійська (математика, астрономія, механіка) 370-415 рр. була однією з найвидатніших вчених свого часу. Вона займалася математикою та астрономією, винайшла астролябію, дистилятор та принцип бульбашкового
ефекту, який досі використовують у ватерпасі.
Значним є внесок Гіпатії в алгебру та геометрію.
Міжнародний
68 Журнал «Сучасна фармація» •
• 2023 / лютий • У світі медицини • Хронограф
строном Марія Маргарет Вінкельманн. Жінки довго не мали доступу до офіційної освіти, тому вони намагалися співпрацювати в наукових дослідженнях зі своїми батьками, братами та чоловіками, і часто це було єдиним шляхом для реалізації їх інтересу в науці. Так, наприклад, Марія Маргарет Вінкельманн, астроном XVIII століття, змушена була приписати свої відкриття чоловіку, тому що жіночі досягнення в науковому світі ніким серйозно не сприймалися.
Àда Лавлейс і обчислювальна машина майбутнього. Ада Лавлейс, донька відомого англійського поета Джорджа Байрона, була виключенням з правил. З дитинства мати наполегливо навчала її математиці і це принесло свої плоди. Ада створила три програми для ще неіснуючої обчислювальної машини. Їй належить також геніальна думка про те, що обчислювальні машини можуть оперувати не лише числами, а й іншими об’єктами. Неймовірним здається той факт, що все це відбувалося у XIX столітті.


Ðозалінд Франклін і ДНК. Жінка-біофізик з Великобританії, зробила відкриття, яке багато науковців вважають найважливішим відкриттям XX століття. На початку 1950-х років вона працювала над рентгеноструктурним аналізом, який дозволив візуалізувати подвійну спіраль людської ДНК. Але ключову роль Франклін у цій роботі постійно знецінювали колеги-чоловіки. Зрештою, Нобелівську премію за відкриття моделі ДНК присудили саме їм, а Розалінд Франклін змогла отримати визнання лише посмертно.
Àвтомобільні «двірники», автомобільний глушник, WI-FI. Автомобільні «двірники» — ідея Мері Андерсон, запатентована нею в 1903 році. Автомобільний глушник теж придумала жінка — Ель Долорес Джонс у 1917 році. Систему зв’язку, на основі якої створили Wi-Fi, винайшла в 1942 році американська актриса Хеді Ламарр.
Ëауреат Нобелівської премії Марія Склодовська-Кюрі народилася в Польщі в 1867 році. Вона мала великі прагнення до знань та блискуче вчилася в школі. Але університет у Варшаві не приймав на навчання жінок, тому Марія поїхала вчитися до Паризької Сорбонни, де здобула ступінь магістра з фізики та математики. Згодом вона захопилася роботою з дослідження радіоактивних хімічних елементів, а її чоловік П’єр Кюрі відмовився від власної кар’єри та став допомагати дружині. В 1898 році подружжя відкрило радій та полоній, а в 1902 році їм вдалося виділити радій з уранової руди. Марії Склодовській-Кюрі присудили Нобелівську премію з фізики, але вона змогла отримати цю нагороду через кілька років вдруге — вже за досягнення в області хімії. На жаль, вона померла від хвороби, спричиненої радіоактивним ураженням організму під час проведення численних наукових експериментів.
Працю жінок-науковців часто недооцінювали, а інформація про багатьох з них неповна й уривчаста. Проте неможливо перерахувати всіх жінок, які змінили на краще світову науку та технології. Факти свідчать про те, що жінки не поступаються чоловікам ні розумовими здібностями, ні сміливістю та наполегливістю в будь-якому виді діяльності, в тому числі в науці.
Історичний нарис Міжнародного Дня

жінок і дівчат в науці
1843 Ада Лавлейс написала програму для обчислювальної машини, яка існувала тоді тільки в теорії. Через багато років після смерті Лавлейс її програму було використано для реальної машини, а цю жінку вважають першим програмістом в історії.

1903 Марія Склодовська-Кюрі першою серед жінок стала лауреатом Нобелівської премії з фізики.

1987 На базі Всесвітньої академії наук було засновано міжнародну організацію «Жінки в науці для країн, що розвиваються».

2010 Для того, щоб якнайшвидше досягти гендерної рівності та розширити права і можливості жі-


нок, створено спеціальну структуру в Організації Об’єднаних Націй «ООН — жінки».
2015 Резолюцією Генеральної Асамблеї ООН 11 лютого проголошено Міжнародним днем жінок та дівчат в науці.
2018 ЮНЕСКО та корпорація L’Oréal створили спільну програму «Жінки в науці» та заснували премію «L’Oréal-ЮНЕСКО для жінок в науці». Вона створена для молодих жінок, які професійно займаються науковими дослідженнями у галузі STEM (наука, технології, інжиніринг, математика) та заохочення їх до розвитку української науки.




À
Журнал «Сучасна фармація» • modern-pharmacy.com.ua • 2023 / лютий • У світі медицини • Хронограф 69
Ãертруда Белл Елайон — хімкиня та фармакологиня розділила Нобелівську премію з Джорджем Хітчінгсом і сером Джеймсом Блеком за інноваційні методи раціонального використання ліків. Брала участь у розробці препаратів, що застосовуються при багатьох захворюваннях, зокрема імуносупресивний препарат азатіоприн, меркаптопурин, піріметамін, антиретровірусний препарат азидотимідин). Останнім великим проривом стала розробка противірусного препарату ацикловіру, що отримав схвалення у 1977 р. Загалом ім’я Г. Елайон фігурує в 45 патентах на лікарські засоби. У 1988 р. вона разом з Дж. Хітчінгсом та Джеймсом Блеком отримала Нобелівську премію з фізіології та медицини «за видатні досягнення у фармакології», однак не за розробку конкретного препарату, а за відкриття нового, більш раціонального підходу до розробки ліків.
Åлізабет Лі Хазен та Рейчел Фуллер Браун — мікробіологині, яким завдячуємо за відкриття ністатину. Препарат зараз застосовується при грибкових інфекціях шкіри, ротової порожнини, піхви та кишкового тракту.
Жінки,


в розвиток
та фармації

Ëейла Денмарк —
американська лікарка-педіатр є однією зі співрозробників вакцини проти кашлюку. У 1935 р. вона отримала нагороду Фішера за видатні дослідження у сфері діагностики, лікування та імунізації проти кашлюку, а також роботу над вакциною.
Ãерті Корі — лауреатка Нобелівської премії, Герті Корі, отримала престижну нагороду за свою роботу в галузі медицини й фізіології в 1947 році. Корі стала першою жінкою, яка отримала Нобелівську премію в цій категорії. Вона працювала зі своїм чоловіком Карлом Фердинандом Корі, з яким прагнула довести важливі концепції генетики. Саме їхня робота привела до відкриття того, що дефіцит одного ферменту в організмі може бути причиною порушень метаболізму. Також пара провела безліч досліджень дії гормонів, приділяючи особливу увагу гіпофізу. За своє життя Герті отримала кілька інших нагород і отримала почесні ступені докторки наук в 5 вищих навчальних закладах.







Òу Юю — китайська хімікиня, яка винайшла препарат на основі полину для лікування малярії — артемізинін, що дозволило врятувати мільйони життів. У своїх пошуках вчена звернулася до китайських медичних текстів династій Чжоу, Цін і Хань. Т. Юю є першою ученою материкового Китаю, що отримала Нобелівську премію в науковій категорії.






Флоренс Зайберт — медикиня, відома за відкриття шкірної туберкулінової проби (манту), що
досі використовується для індивідуальної та диференційної діагностики туберкульозу.
які зробили вагомий внесок
медицини
70 Журнал «Сучасна фармація» • modern-pharmacy.com.ua • 2023 / лютий • У світі медицини • Хронограф
Âірджинія Апгар — відома своїм винаходом шкали Апгар. Це важливий тест, який перевіряє, чи потрібна новонародженим немовлятам термінова медична допомога. Шкала Апгар сприяє значному зниженню дитячої смертності та дотепер використовується для оцінки клінічного стану новонароджених в перші кілька хвилин їхнього життя. Апгар була першою жінкою, яка стала професоркою Коледжу лікарів і хірургів Колумбійського університету.
Ôрансуаза Барре-Сінуссі — вірусологиня, яка з'ясувала, що ВІЛ — причина імунодефіцитного захворювання під назвою СНІД. У 2008 році Баррі разом з Люком Монтаньє виявила, що ретровірус ВІЛ атакує лімфоцити
— клітини крові, які відіграють важливу роль в імунній системі організму. Це відкриття допомогло розробити терапію, яка дає змогу ВІЛ-позитивним людям проживати довге і здорове життя. А також може стати шляхом знайдення ліків в найближчому майбутньому.
Ðозалін Ялоу отримала Нобелівську премію з фізіології й медицини в 1977 році за розробку методу радіоімуноаналізу (RIA), який використовується для вимірювання пептидних гормонів в крові. Діагностична техніка Ялоу виявилась на стільки точною, що її почали використовувати для сканування донорської крові на наявність інфекційних захворювань, таких як ВІЛ та гепатит.
• Хронограф

лізабет Блеквелл стала першою жінкою, яка отримала ступінь докторки медицини в США. Зіткнувшись з відмовою у декількох університетах, в 1847 році Блеквелл нарешті прийняли у Женевський медичний коледж. Спершу однокурсники ставилися до неї вороже, але згодом вона не лише здобула їхню повагу, а й освіту. У 1857 році разом зі своєю сестрою вона відкрила Нью-Йоркський лазарет для жінок і дітей. Блеквелл зіграла важливу роль в США і Великій Британії, як соціальна діячка і реформаторка моралі. Також вона написала книгу «Піонерська робота у відкритті медичної професії для жінок», що надихнуло безліч жінок почати боротися за свої права для здобування медичної освіти
НА ЗАМІТКУ!!!
За всю історію існування Нобелівської премії лише 59 разів її присуджували жінкам
Наразі жінки-нобеліантки складають близько 6 % лауреатів цієї премії
Жінки отримували Нобелівські премії у всіх шести її номінаціях.
Ïатрісія Голдман-Ракич — нейробіологиня, відома своїми дослідженнями мозку. Її міждисциплінарні дослідження зробили значний внесок в розуміння неврологічних захворювань, таких як деменція, хвороба Альцгеймера і Паркінсона. А також у вивчення дофаміну і його вплив на мозок.
Редакція журналу «Сучасна фармація» долучається до відзначення цього дня та вітає чарівну частину наукової спільноти з побажаннями професійних успіхів та творчої наснаги!
•
2023 / лютий
modern-pharmacy.com.ua








•

Журнал «Сучасна фармація»
У світі медицини 71


Å
•
ТЕМПЕРАТУРА
НАШОГО ТІЛА

ЗНИЖУЄТЬСЯ, і причиною можуть
бути кишкові бактерії



Нове дослідження припускає, що зміни в харчуванні за останнє століття змінили середній мікробіом людини і згодом знизили середню температуру тіла.
За останні 150 років вчені спостерігали зниження середньої температури тіла людини більш ніж на півградуса по Фаренгейту (-0,3 °C). У новому дослідженні Мічиганського університету вчені, спостерігаючи за госпіталізованими пацієнтами із сепсисом, виявили, що деякі види кишкових бактерій відіграють певну роль у регуляції температури тіла, і було висунуто гіпотезу, що ці мікробні зміни можуть бути причиною
цих поступових змін температури тіла.

У середині 19 століття німецький лікар Карл
Рейнгольд Август Вундерліх витратив роки на збирання мільйонів вимірювань температури тіла тисяч пацієнтів. Його робота зрештою показала, що середня температура тіла людини становить 98,6 °F (37 °C). Звичайно, це було лише середнє значення з діапазоном нормальних температур
тіла від 97,2 до 99,5 °F (36,2 до 37,5 °C).




Відтоді багато дослідників припускали, що ця середня температура тіла трохи вища за ту, яку зазвичай можна
визначити у більшості людей. Але кілька років тому команда зі Стенфордського університету заявила, що початкові розрахунки Вундерліха, ймовірно, були правильними, а натомість
наші сучасні вимірювання свідчать про те, що середня температура людського тіла фактично впала з часом. Це дослідження показало, що температура тіла сучасної людини в середньому становить близько 97,5 °F (36,4 °C), і протягом останнього століття відносно послідовно знижувалася кожне десятиліття. Однак чому це відбувається, було незрозуміло, і висунуто безліч гіпотез, від поліпшення опалення та охолодження домогосподарств, що знижує загальну швидкість метаболізму, до покращення охорони здоров’я, що призводить до зниження запалення в усього населення. У новому дослідженні вчених з Медичної школи Мічиганського університету була перевірена інша гіпотеза. Цього разу досліджувалась роль нашого кишкового мікробіому в регулюванні температури тіла.
Щоб виявити це, дослідження було зосереджено на госпіталізованих пацієнтів із сепсисом. Попередні дослідження показали, що клінічні результати для пацієнтів із сепсисом можна передбачити за траєкторіями температури тіла під час госпіталізації. Таким чином поставало питання - чи може склад мікробіома кишечника, під час первинної госпіталізації, передбачити ці траєкторії температури тіла.
У понад 100 пацієнтів із сепсисом були відібрані зразки мікробіомів під час госпіталізації, і дослідження виявило чіткі моделі кишкових бактерій, які корелювали з траєкторією температури їхнього тіла протягом

72 Журнал «Сучасна фармація» • modern-pharmacy.com.ua • 2023 / лютий • У світі медицини • Цікаво
часу перебування в лікарні. Зокрема, високі рівні бактерій Firmicutes були найбільш пов’язані з подальшою високою температурою.
Спостерігаючи за піддослідними тваринами, дослідники виявили, що миші без мікробіому демонстрували менш екстремальні коливання температури тіла, викликані сепсисом, порівняно з мишами з нормальними кишковими бактеріями. За словами керівника дослідження Роберта Діксона, коливання температури
тіла, які фіксувалися у мишей, можуть бути пов’язані з подібними родинами бактерій, які спостерігаються в
когорті сепсису людини.
«Ми виявили, що однаковий тип
кишкових бактерій пояснює коливання

температури як у наших людей, так і в

наших лабораторних мишей», — сказав
Діксон. «Це додало нам впевненості в
достовірності наших висновків і дає нам ціль для розуміння біології, що стоїть за цим відкриттям».
Яким чином регулюється температура тіла? Постійність температури внутрішнього середовища організму досягається за рахунок балансу процесів теплопродукції та тепловіддачі. Теплопродукція здійснюється завдяки біохімічним реакціям з виділенням тепла. Основними органами теплоутворення є м'язи і печінка. Тепловіддача здійснюється шляхом втрати тепла теплопроведенням, тепловипромінюванням і випаром. У тепловіддачі беруть участь шкіра, слизові оболонки, легені, серцево-судинна і видільна системи.

Нервові механізми терморегуляції в свої й основі мають рефлекторні дуги, до

складу яких входять рецепторні утворення (теплові та холодові рецептори), закладені в основному в поверхневих шарах шкіри. Крім цього, холодові рецептори (більше численні, ніж теплові) локалізуються і у внутрішніх органах. По нервових волокнах імпульсація від рецепторного апарату досягає основних центрів структур гіпоталамуса. Структури ЦНС мають власні терморецептори. Отже, організм людини має подвійну систему контролю температури тіла: шкірними рецепторами, терморецепторами внутрішніх органів і структур ЦНС.
Найбільше значення в регуляції температури внутрішнього середовища організму має гіпоталамус, в якому локалізовані два регулюючих центри: центру теплоутворення і центру тепловіддачі.
Отже, що все це означає? За словами провідного автора Кале Бонгерс, ці висновки є хорошим доказом того, що кишкові бактерії відіграють значну роль у регулюванні температури нашого тіла. І зміни мікробіома через дієту, протягом останнього століття, можуть бути основою невеликого зниження середньої температури тіла людини.
«Хоча ми точно не довели, що зміни в мікробіомі пояснюють
падіння температури тіла людини, ми вважаємо, що це розумна гіпотеза», — додав Бонгерс. «Генетика людини
істотно не змінилася за
останні 150 років, але зміни в
дієті, гігієні та використанні
антибіотиків мали глибокий
вплив на наші кишкові бактерії».
ЦЕ ЦІКАВО!!!
Лауреатами Нобелівської премії 2021 з фізіології та медицини стали Девід Джуліус та Ардем Патапутіан «за відкриття рецепторів температури та дотику». Науковці відкрили рецептори, які реагують на механічні подразники шкіри та внутрішніх органів. Зокрема Девід Джуліус використав капсаїцин, гостру сполуку з перцю чилі, щоб ідентифікувати рецептори у нервових закінченнях шкіри, які реагують на тепло. Патапутіан для цього дослідження використав чутливі до тиску клітини. Ці відкриття дали початок інтенсивній науковій діяльності, яка призвела до швидкого розширення розуміння того, як наша нервова система відчуває тепло, холод та механічні подразники. Коли ми їмо перець чилі, то відчуваємо печіння – його викликає хімічна сполука капсаїцин. Капсаїцин активує нервові клітини, спричиняючи больові відчуття, але механізм його дії до 1990-х років був невідомий. Девід Джуліус відкрив рецептор капсаїцину, який пізніше отримав назву TRPV1. Коли Джуліус досліджував здатність білка реагувати на тепло, він зрозумів, що виявив термочутливий рецептор, який активується при температурах, які тіло сприймає болючими.
Тоді Джуліус ідентифікував рецептор TRPM8, який активується холодом. Девід Джуліус і Ардем Патапутіан незалежно одне від одного використовували ментол для виявлення цього рецептора.
За матеріалами American Journal of Respiratory and Critical Care Medicine.

Журнал «Сучасна фармація» • modern-pharmacy.com.ua • 2023 / лютий • У світі медицини • Цікаво 73
Українських ліків у Європі стане більше:
«ФАРМАК» БУДУЄ ЗАВОД В ІСПАНІЇ
НАЙБІЛЬШИЙ ВИРОБНИК ЛІКІВ УКРАЇНИ «ФАРМАК» ІНВЕСТУЄ ПОНАД 20 МЛН ЄВРО У НОВИЙ ЗАВОД ВЛАСНИХ ЛІКАРСЬКИХ ЗАСОБІВ В ПЕРЕДМІСТІ БАРСЕЛОНИ.
Підприємство з повним ланцюжком поставок і замкнутим циклом виробництва та контролем якості планують відкрити на початку 2024 року. Тут будуть випускати стерильні лікарські засоби у вигляді розчинів, суспензій у флаконах та шприцах. Крім самого виробництва, компанія планує відкрити в Іспанії мультифункціональний лабораторний комплекс з R&D-центром. Аналогічно українським асептичних цехам «Фармак» в Україні, іспанське виробництво компанії відповідатиме найвищим європейським стандартам GMP (прим. належна виробнича практика) та американським FDA (прим. управління з санітарного нагляду за якістю харчових продуктів та медикаментів).
«Відкривати завод у ЄС ми запланували ще до початку війни. «Фармак» знаходиться на шляху трансформації в міжнародну
компанію. Тому ми вирішили не змінювати свою стратегію
і не обмежувати можливості розвитку підприємства. По-перше, це допоможе «Фармак» першим з вітчизняних компаній інтегруватися
у європейський фармацевтичний
ринок. По-друге, ми отримаємо ряд
переваг, серед яких – поглиблення
співпраці з європейськими партнерами, більш масштабне
представлення українського
бізнесу на європейському ринку, обмін знаннями з європейськими спеціалістами у рамках дослідницької
лабораторії та імпорт передових
практик в Україну», — розповідає
виконавчий директор «Фармак»
Володимир Костюк.
Компанія не планує переміщувати виробничі потужності зі своїх українських заводів, а будує нове виробництво.
Наразі у продуктовому портфелі «Фармак» понад 450 найменувань лікарських засобів. Серед яких ендокринологічні, гастроентерологічні, кардіологічні, неврологічні, протизастудні препарати тощо. Окрім забезпечення ліками українського ринку, «Фармак» здійснює експорт до більш як 40-ка країн ЄС, Центральної та Південної Америки, СНД, Близького Сходу та Азії. При цьому, фокус компанії беззмінно залишається на першочерговому покритті потреб української системи охорони здоров’я.





74 Журнал «Сучасна фармація» • modern-pharmacy.com.ua • 2023 / лютий • У світі медицини • Події
У Великобританії з’являться нові
лікарські засоби від «Фармак»
Найбільший український виробник та експортер лікарських засобів, фармацевтична компанія «Фармак», розширила лінійку власної продукції, що реалізується на ринку Великобританії.
У результаті успішного проходження перевірок британських контролюючих органів, що тривали більше року, українська компанія зареєструвала два нові продукти, які тепер будуть продаватися у Великобританії. Це лікарський препарат, що використовують під час проведення МРТ (прим.: магнітно-резонансній томографії) та гормональний лікарський засіб для зупинки кровотечі. Також на даному ринку представлений протизапальний знеболюючий засіб для застосування у стоматології, який компанія «Фармак» продає у Великобританії з 2021 року.


«Ми представили британському ринку
серйозні лікарські препарати та вже маємо велике замовлення на їх постачання протягом двох років. Наразі ми співпрацюємо
з локальними партнерами по всьому світу, які відслідковують потреби ринку в своєму регіоні, та аналізують, з якими препаратами «Фармак» може найбільш успішно конкурувати в певній країні. Цей підхід допомагає трансформувати нашу українську компанію в міжнародну. Та продемонструвати світу потенціал української фармацевтики
в цілому», — зазначає виконавчий директор «Фармак» Володимир Костюк.

/ лютий
•
«Сучасна фармація» • У світі медицини • Події 75
Під час війни компанія першочергово задовольняє внутрішній попит українських пацієнтів, армії та шпиталей, а лише потім готує продукцію на експорт. У 2022 році «Фармак» відвантажив понад 240 різновидів продукції у понад 30 країн світу. Лікарські засоби українського виробника продаються в країнах ЄС, Центральної та Південної Америки, СНД, Близького Сходу, Азії. У 2021 році «Фармак» відкрив представництво у В’єтнамі та офіс у Об’єднаних Арабських Еміратах. Також компанія планує у 2024 році відкрити новий завод у Барселоні. Крім самого виробництва в Іспанії планується відкриття мультифункціонального лабораторного комплексу з R&D-центром для розробки і тестування нових лікарських засобів. •
Журнал 2023
modern-pharmacy.com.ua
CХВАЛЕНО ПЕРШИЙ
ГЕННИЙ ПРЕПАРАТ ДЛЯ
ЛІКУВАННЯ ПАЦІЄНТІВ
З ГЕМОФІЛІЄЮ В
HEMGENIX — препарат для терапії гемофілії В компанії CSL Behring LLC отримав позитивний висновок від Європейської комісії і умовний дозвіл на продажі. Це перший схвалений метод генної терапії

гемофілії В у ЄС та Європейській економічній зоні. Умовний дозвіл на продаж надається лікарському засобу, який задовольняє медичну потребу, коли користь для здоров’я населення від негайної доступності переважає ризик, пов’язаний з тим, що все ще потрібні додаткові дані. Очікується, що власник реєстраційного посвідчення надасть вичерпні клінічні дані на більш пізньому етапі.
Етранакоген дезапарвовек —
це векторна генна терапія на основі аденоасоційованого вірусу серотипу 5 (AAV5), який було модифіковано, щоб він не спричиняв захворювання у людей. Препарат показаний для лікування дорослих із вродженою недостатністю
фактора IX крові і містить копії гена, відповідального за цей фактор. При введенні у вену пацієнта вірус переноситься до печінки, де ген поглинається клітинами та починає виробляти фактор IX. Перевагами HEMGENIX є індукція відповідних рівнів потрібного фактора у плазмі та зменшення епізодів кровотечі.
Пацієнти з гемофілією живуть із постійною загрозою кровотечі або повторюваних епізодів серйозних спонтанних кровотеч. Тому ліки від цього захворювання це безсумнівний прорив в медицині і шанс хворим жити нормальним життям.
Під час триваючого клінічного випробування
HEMGENIX успішно зменшив частоту щорічних кровотеч за допомогою однієї інфузії. Більшість пацієнтів більше не потребували замісної терапії фактором IX протягом двох років після введення. Найпоширенішими побічними ефектами HEMGENIX були головний біль, порушення лабораторних показників печінки (підвищення АЛТ і АСТ) і грипоподібні захворювання.


Рішення ЄС прийнято після позитивного висновку Комітету з лікарських засобів для людини (CHMP) та Європейського агентства з лікарських засобів (EMA)
минулого року, який ґрунтувався на результатах ключового дослідження HOPE-B — найбільшого дослі-
дження генної терапії при гемофілії B на сьогоднішній день.
Професор Вольфганг Місбах, голова відділу розладів згортання крові в Центрі комплексного лікування Університетської лікарні Франкфурта, оптимістично оцінив рішення і сказав, що це важливий крок уперед у лікуванні гемофілії В, завдяки якому покращується якість життя таких хворих, позбавляючи їх від довічних внутрішньовенних інфузій фактора IX крові. Доктор Білл Меццанотт, керівник відділу досліджень і розробок і головний медичний директор CSL, зазначив, що схвалення HEMGENIX в Європі є сенсом великої науки, що створює ліки, які можуть змінити парадигму лікування як для людей, які живуть з гемофілією B, так і медичних працівників, які їх лікують.
Гемофілія — це генетичне захворювання крові, яке відноситься до групи плазмових геморагічних діатезів. Патологія полягає у природженій нестачі або дефіциті факторів згортання крові. В залежності від того, який фактор відсутній, розрізняють гемофілію A (дефіцит фактора VIII), гемофілію B (дефіцит фактора IX) або гемофілію C (дефіцит фактора XI).
Гемофілію часто називають «вікторіанською хворобою» і «царською хворобою». Оскільки, найбільш відомий носій гемофілії — королева Вікторія.
Цікавим фактом є те, що хворіють на це захворювання чоловіки, жінки лише передають його своїм дітям. Поширеність гемофілії у більшості європейських країн становить 13–18 випадків на 100 тисяч чоловічого населення.
Всесвітній день боротьби з гемофілією був проголошений 17 квітня за ініціативою Всесвітньої Організації Охорони Здоров’я та Всесвітньої федерації гемофілії. Ця дата була обрана організаторами не випадково, це день народження засновника Всесвітньої федерації гемофілії Френка Шнайбеля.
Джерело: https://www.pharmatimes.com


76 Журнал «Сучасна фармація» • modern-pharmacy.com.ua • 2023 / лютий • У світі медицини • Інновації
MODERN НАТУР MODERN
c.78
НАТУР
Харчування: користь і шкода харчових та нехарчових компонентiв
c.84 Ігроманія сучасні реалії паралельного світу
Оmnis ars imitatio est naturae
Будь-яке мистецтво є наслідуванням природи

ХАРЧУВАННЯ:
користьшкод а
ТА НЕХАРЧОВИХ КОМПОНЕНТIВ
«Valetudo est bonum optimum» –



«Здоров’я — найвище благо» Латинський афоризм

Їжа, яку споживає людина, необхідна для побудови та функціонування організму. З іншого боку, харчування має значення з погляду профілактичної медицини.
«Якщо батько хвороби не завжди відомий, то мати її
AДолжикова Олена Вікторівна, доктор фарм. наук, доцент кафедри клінічної лабораторної діагностики
У колишні часи лікарям доводилося мати справу здебільшого з наслідками недостатнього харчування, тепер їхньої уваги більшою мірою вимагають прояви переїдання. Надмірне харчування призводить до ожиріння, супутниками якого часто є «хвороби цивілізації», і зменшення середньої тривалості життя.
МИ ХАРЧУЄМОСЯ?
Відповідаючи на це питання, можна сказати, що при плануванні та виборі раціону харчування лікарі-дієтологи рекомендують віддавати перевагу продуктам, які вирощені у своєму регіоні. Передумовою такої рекомендації, з погляду фахівців, є те, що рослини зазвичай виробляють ті речовини, які допомагають їм протидіяти несприятливим місцевим умовам. Тому людина, яка споживає ці продукти, сама стає біочастинкою даного регіону і підвищує свої адаптаційні можливості.
Також не меншого значення набуває і відповідність характеру харчування сезонам річного циклу. Так, за зовнішньої спеки влітку відтворення тепла організмом зменшується, а тепловтрата повинна збільшуватися, чому сприяє вживання сирих рослинних продуктів, які містять значний вміст вологи, низьку калорійність. Взимку ж навпаки, краще вживати натуральні продукти, які мають не тільки високий енергопотенціал (жировмісні продукти, каші, горіхи), але і стимулюють теплоутворення (наприклад,
м’ясо), а також містять у концентрованому вигляді велику кількість біологічно активних речовин (наприклад, сухофрукти).
Принциповим є питання фізіологічної передумови — голоду, і вирішення його: коли, скільки і як треба їсти. Голод виникає як результат зниження концентрації поживних речовин у крові (насамперед — вуглеводів), і впливі цієї «голодної» крові на центр голода у головному мозку. Тому саме голод коригує поведінку людини, направлену на відновлення дефіциту поживних речовин і їхньої кількості.
У сучасної людини, яка перетворила їжу на задоволення, ситуація складається іншим чином. По-перше, вона їсть не при відчутті голоду, а при появі апетиту, який на відміну від голоду, має, в основному, психологічну природу (передчуття задоволення). По-друге, найчастіше безпосередньому отриманню їжі не передує необхідність витрати фізичних зусиль, що робить бажаний прийом їжі ще привабливішим. По-третє, надання їжі приємних смакових якостей значно під-
ХАРЧОВИХ
і
завжди — їжа» Гіппократ • ТАК
ВЖИВАЄМО І ЧИ ПРАВИЛЬНО
•
ЯКУ Ж ЇЖУ МИ
78 Журнал «Сучасна фармація» • modern-pharmacy.com.ua • 2023 / лютий • Натур modern • Думка фахівця
вищує потяг людини до її прийому. Це усе може призвести до надмірного споживання їжі і, як наслідок, проблем із здоров’ям.
Виходячи з цього, людина повинна харчуватися раціонально, тобто враховуючи особливості, такі, як вік, стать, характер життєдіяльності, звички та професія, сімейний стан та рухова активність. З урахуванням цих обставин слід звернути увагу на низку правил (рис. 1).
Таким чином, правильна організація харчування сприяє підтримуванню та зміцненню здоров’я, а порушення, яке, на жаль, найчастіше і буває у сучасному світі, веде до виникнення багатьох функціональних порушень та захворювань.
час та частота прийому їжі повинні узгоджуватися з режимом роботи (навчання)
при малій руховій активності кожному прийому їжі повинні передувати хоча б 10-15-хвилинні фізичні вправи (гімнастичні вправи, ходьба, танці тощо)
при високій руховій активності в раціоні повинна бути передбачена відповідна вуглеводна та білкова компенсація
харчовий раціон для організму, який росте, повинен відрізнятися позитивним балансом надходження речовин проти витрати, що забезпечує анаболізм
основним показником збалансованого харчування має бути високий рівень здоров’я, а у дорослої людини — ще й незмінна маса тіла напруженій роботі повинна передувати легка їжа, а після такої роботи — щільна їжа
їжу слід «заслужити», тобто харчування має не створювати запаси необхідних речовин для подальшої життєдіяльності, а бути результатом цієї життєдіяльності
КОМПОНЕНТИ ЇЖІ
Також їжа повинна бути корисною як у енергетичному, так і у пластичному відношенні, а також не спричиняти негативного впливу на організм. Враховуючи той факт, що харчові продукти складаються із тисячі хімічних речовин, для полегшення вивчення їх групують за певними фізіологічними та біохімічними властивостями. Відповідно до класифікації за Покровським О.О., харчові речовини поділяються на нутрієнти та нехарчові компоненти (рис. 2).
ХАРЧОВІ РЕЧОВИНИ




НУТРІЄНТИ
Білки: повноцінні та неповноцінні; тваринного та рослинного походження
Вуглеводи: прості цукри та полісахариди
Жири: тваринного та рослинного походження; жироподібні речовини.
Вітаміни: водорозчинні та жиророзчинні.
Мінеральні речовини: макроелементи та мікроелементи
НУТРІЄНТИ
Баластні сполуки: целюлоза, геміцелюлоза та пектин
Захисні компоненти
Смакові та ароматичні речовини
Компоненти їжі, які несприятливо впливають на організм людини
НЕХАРЧОВІ КОМПОНЕНТИ Рисунок 2. Класифікація харчових речовин.
Нутрієнти відіграють в організмі важливу роль (рис. 3), сприяючи його функціонуванню.
Білки з хімічної точки зору є полімерами, які складаються з 20 амінокислот, що забезпечують різноманітність білків. Одні амінокислоти синтезуються в організмі і називаються замінними, інші, які не синтезуються, повинні в достатній кількості надходити з їжею — незамінні амінокислоти. Біологічна цінність білків визначається наявністю в них незамінних амінокислот, їх співвідношенням із замінними та ступенем їх засвоюваності. За цим правилом розрізняють: z
біологічно цінні білки або «повноцінні», до складу яких входять усі незамінні амінокислоти; z менш цінні білки або «неповноцінні», які не мають однієї або більше незамінних кислот.
Журнал «Сучасна фармація» • modern-pharmacy.com.ua • 2023 / лютий • Натур modern • Думка фахівця 79
Залежно від свого походження розрізняють білки рослинного (зернобобові, овочеві, листова зелень, горіхи, насіння, крупи, хліб) та тваринного (м’ясо, риба, птиця, яйця та молочні продукти) походження.
Слід пам’ятати, що потреби у білках зростають при вагітності, інфекційних захворюваннях, авітамінозах, тяжкому фізичному навантаженні.
Важливою умовою є теплова обробка їжі, від якої залежить засвоюваність білків. У дієтології розроблено низку рекомендацій із цього приводу. По-перше, не слід тривалий час піддавати їжу високотемпературній обробці. По-друге, краще вживати варене та тушковане м’ясо, а не смажене. Дрібно нарубане, перекручене м’ясо корисніше, ніж цільне. По-третє, мінімальній термічній обробці слід піддавати і рослинну їжу. Легкозасвоювані рослинні білки (які містяться у овочах, зелені) доцільніше використовувати в їжу у сирому вигляді. Сир, яйця, м’ясо та рибу, які містять концентрований тваринний білок, доцільно вживати з великою кількістю сирих овочів та зелені, що сприяє його кращому перетравленню та засвоєнню.
Але необхідно враховувати кількість білкової їжі, бо дефіцит білка знижує стійкість організму до інфекцій, негативно відбивається на діяльності серцево-су-
Вуглеводи — найважливіші енергетичні (56 % енергії організм отримує за рахунок вуглеводів) компоненти харчового раціону.
ЕНЕРГЕТИЧНА ФУНКЦІЯ (перетворення їжі в організмі з виділенням енергії)
ПЛАСТИЧНА ФУНКЦІЯ (побудова тканин та органів нашого тіла)
ФУНКЦІЇ

НУТРІЄНТІВ
РЕГУЛЯТОРНА ФУНКЦІЯ (вплив на діяльність окремих органів, тканин)

ІНФОРМАЦІЙНА

ФУНКЦІЯ (надходження хімічної та енергетичної інформації про навколишню дійсність)
динної, дихальної та інших систем організму. У свою чергу, надмірне білкове харчування сприяє розвитку атеросклерозу, накопиченню в організмі токсичних продуктів розпаду білків (аміак, сечовина та ін.), знижує імунітет, є одним із факторів онкологічного ризику.
Основним та практично єдиним постачальником енергії для діяльності головного мозку є глюкоза. Вуглеводи потрапляють у наш організм у вигляді простих цукрів (глюкоза, фруктоза, галактоза, сахароза тощо), які містяться у меді, солодких фруктах, соках, рафінованому цукрі, варенні, джемі, кремах, цукерках та у вигляді полісахаридів, які містяться у хлібі, злаках та крохмальвмісних овочах (крохмаль), печінка, м’ясо (глікоген) та у сирих овочах та зелені (клітковина).
Моноцукри швидко всмоктуються у відділах шлунково-кишкового тракту. Тому чисельні рекомендації дієтологів передбачають вживання фруктів, особливо солодких, в окремі прийоми їжі, не поєднуючи крохмалисту та білкову їжу. Такий же олігосахарид, як лактоза, який у великих кількостях міститься у коров’ячому молоці (5 %) у деяких людей із віком викликає розлади шлунково-кишкового тракту (через нестачу специфічного ферменту). Ці люди не переносять молоко, але можуть пити кефір, де цей цукор спожитий кефірними дріжджами. Із засвоюваних полісахаридів особливе місце займає крохмаль, на частку якого припадає до 80 % засвоюваних вуглеводів.
Деякі вуглеводи є незасвоюваними і відносяться до баластних (нехарчових) речовин.

Нестача, так же як і надлишок, вуглеводів чинять негативний вплив, який проявляється:
порушенням функціонування центральної нервової системи;
послабленням розумової діяльності;

атрофією м’язів (нестача);
а також порушення обміну речовин (надлишок), що веде до ожиріння, цукрового діабету та інших захворювань сучасної людини.
Рисунок 3. Функції нутрієнтів.
80 Журнал «Сучасна фармація» • modern-pharmacy.com.ua • 2023 / лютий • Натур modern • Думка фахівця
Жири — це органічні сполуки тваринного та рослинного походження, які належать до найважливіших та незамінних компонентів їжі. Вони є складними органічними сполуками, що складаються з двох компонентів: гліцерину та жирних кислот.
Тваринні жири (сало, жир, вершкове масло, сир, сметана, вершки, ковбаса, жирна свинина) містять насичені жирні кислоти (стеаринову, пальмітинову та ін., які можуть частково синтезуватися в організмі) та мають менший ступінь перетравлення та всмоктування. В свою чергу, рослинні жири (у вигляді олій соняшникової, оливкової, горіхової тощо) містять ненасичені жирні кислоти (ліноленова, лінолева, арахідонова та ін., не можуть синтезуватися в організмі людини) і мають вищий ступінь перетравлення та всмоктування.
До складу харчових продуктів входять і так звані невидимі жири (у м’ясі, рибі, молоці тощо) та спеціальні кулінарні жири і маргарини. Тому це необхідно враховувати у добовому раціоні.

Необхідно зазначити, що для кулінарної обробки жирів краще використовувати нерафіновану олію. Короткочасне нагрівання збільшує засвоюваність тугоплавких жирів і, навпаки, зменшує біологічну цінність рослинних жирів, тому що руйнує поліненасичені жирні кислоти та деякі вітаміни. При тривалій те-
Вітаміни (лат. vita — життя і амін — речовина, яка містить аміногрупу) є біологічно активними речовинами, які мають велике значення для нормальної життєдіяльності організму.

Вони є каталізаторами дії ферментів та гормонів, сприяють правильному обміну речовин, підвищують розумову та фізичну працездатність, забезпечують витривалість організму та стійкість до інфекцій. Більшість вітамінів не синтезуються в організмі людини, тому необхідне постійне надходження їх із їжею. Деякі з вітамінів депонуються в тканинах і витрачаються в міру необхідності. Частина вітамінів синтезується
мікрофлорою кишечника, тому навіть їх відсутність у їжі не викликає негативних змін у організмі.

З хімічної точки зору вітаміни ділять на водорозчинні (вітаміни групи В (В1, В2 , В3, В6, В12 , ВС), вітамін РР і С), жиророзчинні (А, D, Е, К) та вітаміноподібні речовини (вітамін Р, В15, В 4, В8 тощо).
Дефіцит будь-якого вітаміну викликає порушення обміну речовин і спочатку не проявляється у зовнішніх ознаках. Поступово розвиваються гіповітамінози (зниження забезпеченості організму тими чи іншими вітамінами) надалі можуть призвести до важких патологічних станів — авітамінозів. Наслідком таких змін є зниження стійкості організму до дії пошкоджуючих факторів.
Гіповітамінози можуть бути спричинені недостатнім надходженням в організм вітамінів з їжею внаслі-
пловій обробці (понад 30 хв.) утворюються токсичні продукти окислення жирних кислот. При багаторазовому надмірному нагріванні жиру вище 200° С у жиру з’являються канцерогенні речовини.
Але як і для попередніх речовин надмірне вживання і нестача жирів призводять до порушень функціонування організму. Тривале обмеження споживання жирів призводить до ослаблення імунітету, порушення діяльності нервової системи, скорочення тривалості життя. Надмірне ж їх споживання сприяє розвитку атеросклерозу, ожиріння, порушення обміну речовин.
док харчування рафінованими продуктами, недостатнім споживанням рослинної їжі, неадекватною кулінарною обробкою та тривалим неправильним зберіганням продуктів. Також причиною можуть бути порушення функціонування травної системи, печінки, при деяких інфекціях та застосуванні ліків (наприклад, ацетилсаліцилова кислота — аспірин — посилює виведення вітамінів з організму із сечею).


У зимово-весняний період виникає сезонний гіповітаміноз. У цей період до раціону бажано додатково вводити вітаміни.
Надмірне застосування вітамінних засобів може призвести до гіпервітамінозу. Так, передозування, здавалося б, невинної аскорбінової кислоти призводить до загострення інфекційно-алергічних захворювань, підвищує зсідання крові, аж до тромбоутворення, чинить подразнювальну дію на слизову оболонку шлунково-кишкового тракту, підвищує ризик виникнення виразкової хвороби шлунка. До особливо тяжких отруєнь призводить передозування синтетичних вітамінів А і D. Лікарі-дієтологи наголошують, що хімічно синтезовані вітаміни значно гірше засвоюються організмом, ніж вітаміни, які містяться в овочах, ягодах, фруктах та лікарських рослинах. Так як у природному комплексі з іншими біологічно активними речовинами значно підвищується засвоюваність вітамінів.
Журнал «Сучасна фармація» • modern-pharmacy.com.ua • 2023 / лютий • Натур modern • Думка фахівця 81
Для компенсації сезонного гіповітамінозу до раціону рекомендується включати свіжі соки коренеплодів (моркви, буряків, ріпи тощо), які успішно зберігаються до пізньої весни наступного року, квашену капусту, сік обліпихи, журавлину. Водні настої таких лікарських рослин, як кропива, суниця, плоди шипшини, горобини, чорної смородини є природними полівітамінними препаратами, що не призводять до явищ гіпервітамінозу. Надходження вітамінів до ор-
Мінеральні речовини становлять 0,7–1,5 % їстівної частини харчових продуктів. Вони не мають енергетичної цінності, проте без них життя людини неможливе. Роль мінеральних речовин у організмі людини різноманітна.
Вони відіграють основну
роль у забезпеченні сталості
осмотичного тиску, який є необхідною умовою для нормальної
ганізму може бути недостатнім внаслідок неправильної кулінарної обробки продуктів харчування: нагрівання, консервування, копчення, висушування, заморожування, а також внаслідок нераціонального харчування.
Задля збереження вітамінів у овочевих стравах їх слід піддавати мінімальній тепловій обробці. І за можливості віддавати перевагу сирим вегетаріанським стравам.
життєдіяльності клітин та тканин. Мінеральні речовини входять до складу гемоглобіну, гормонів, ферментів, є пластичним матеріалом для утворення кісткової та зубної тканини. У вигляді іонів мінеральні речовини беруть участь у передачі нервових імпульсів, забезпечують зсідання крові тощо. Мінеральні речовини поділяються на макроеле-
менти (Ca, P, Mg, Na, K, Cl, S), які містяться в їжі в відносно великих кількостях та мікроелементи (Fe, Zn, J, F, Cu), які містяться у незначних кількостях.

Задля забезпечення організма достатньою кількістю мінеральних речовин раціон повинен бути різноманітним і містити продукти тваринного та рослинного походження.
НЕХАРЧОВІ КОМПОНЕНТИ, крім речовин, які несприятливо впливають на здоров’я, не володіючи енергетичною та пластичною цінністю, відіграють важливу роль у процесі травлення і впливають на стан здоров’я людини.
Баластові сполуки (целюлоза, геміцелюлоза та пектин, які відносяться до незасвоюваних вуглеводнів, окрім клітковини) є необхідними компонентами їжі та сприяють нормальному процесу травлення, бо нормальний процес травлення без них неможливий. Клітковина та інші баластні речовини створюють сприятливі умови для просування їжі шлунково-кишковим трактом, нормалізують діяльність мікрофлори, сприяють виведенню з організму холестерину. Клітковина певною мірою знижує апетит і створює відчуття насичення. Також клітковина та пектинові речовини можуть пов’язувати кальцій, магній, фосфор, залізо, цинк, мідь та інші мікроелементи. Оптимальний вміст баластових речовин легко забезпечується споживанням сирих та сушених фруктів, овочів, ягід, листової зелені та хліба грубого помелу.
До захисних компонентів харчових продуктів належать речовини, що у забезпеченні бар’єрних функцій тканин. Сюди можна віднести вітаміни А, С, Р, Е та групи B, речовини, які беруть участь у захисті організму від патогенних мікроорганізмів та вірусів — фітонциди. Ці рослинні сполуки транзитом проходять через весь шлунково-кишковий тракт та знешкоджують мікроорганізми. Вони містяться у гірчиці, хріні, часнику, цибулі, петрушці, капусті, буряках, моркві, цитрусових, обліписі, червоній та чорній смородині, суниці, журавлині, брусниці. Усі фітонциди, крім фітон-

цидів часнику, дуже нестійкі та руйнуються при тривалому зберіганні.
До захисних компонентів їжі відносяться і сполуки, які сприяють знешкоджувальній функції печінки (вітаміни В15, В12 , РР, В2).
Дуже важливі також речовини, які виявляють антиканцерогенні ефекти (баластні речовини, бета-стирол рослинних олій, комплекс вітамінів А, С та Е, вітамін K).
Джерелами захисних речовин є молоко, сир, кисломолочні продукти, нежирні сорти м’яса та риби у відвареному вигляді, яєчний білок, рослинні олії, вівсяна та гречана крупи, листові овочі, буряк, морква, гарбуз, аґрус, обліпиха, шипшина.

Однак у продуктах харчування містяться і речовини, які здатні протидіяти прояву позитивного ефекту захисних речовин. Наприклад, біогенні аміни, які знаходяться в багатьох сортах сиру, шоколаді, томатах, ананасах, червоних винах, а також холестерин, який міститься в жирах, жирному м’ясі.
Слід пам’ятати, що антихарчові речовини не чинять токсичності, але блокують і гальмують засвоєння багатьох нутрієнтів.
Особливої уваги заслуговують компоненти їжі, які несприятливо впливають на організм. Це природні токсичні сполуки та канцерогенні речовини. Найпоширенішими природними токсичними сполуками є лектини, ціаногенні аміни та соланін.
Са Fe Mg Cl Na 82 Журнал «Сучасна фармація» • modern-pharmacy.com.ua • 2023 / лютий • Натур modern • Думка фахівця
Лектини (містяться в бобових, арахісі, проростках рослин, ікрі риб) здатні порушувати всмоктування у тонкому кишечнику, підвищувати проникність стінок кишечника, що призводить до проникнення чужорідних речовин у кров. Теплова обробка руйнує їх майже повністю.
Ціаногенні аміни (містяться в ядрах кісточок мигдалю, абрикосів, вишні) є небезпечними, бо внаслідок їхнього руйнування відбувається виділення синильної кислоти.
Це відбувається, наприклад, при тривалому зберіганні наливок, настояних на плодах із кісточками.
Соланін утворюється в позеленілих бульбах картоплі.
Канцерогенні речовини — це поліциклічні ароматичні вуглеводи, які утворюються в обвуглених ділянках харчових продуктів, перегрітих жирах, в продуктах копчення. Вони містяться в продуктах, які зберігаються при недостатньо низькій температурі, можуть утворюватися в рослинах, які виросли на ґрунті, рясно удобреному азотистими сполуками (нітратами), особливо їх багато в буряках та листових овочах.
Особливе місце у списку речовин, які необхідно вживати, займає вода, так як організм дорослої людини на 60–70 % складається із води. Вода є основним середовищем, у якому відбуваються численні хімічні реакції, тому вона повинна бути у достатній кількості.
Для здоров’я шкідливі як нестача води, так і її надлишок. При нестачі води в організмі відбувається деяке згущення крові, утруднюється робота нирок, погіршується робота мозку (він містить 80 % води). При надлишку води посилюється робота нирок, серце працює з великим перевантаженням через збільшення об’єму крові. Протягом
доби людина втрачає приблизно 2–2,5 літра води.
Близько 1 літра води відновлюється за рахунок харчових продуктів, та води, яка утворюєть-
ся в організмі людини в результаті метаболізму.
Тому на частку рідких продуктів припадає 1–1,5


літра води, сюди входить вода напоїв (соки, компоти, мінеральна вода) та рідкі страви. Лікарі-
дієтологи рекомендують дотримуватися рівномірного вживання води протягом усього дня. А у спеку або під час посиленої фізичної роботи краще вживати мінеральну воду, сильно розведений фруктовий або ягідний сік, або злегка підсолену воду. Велике значення має якість води. Обов’язковим правилом є вміст у ній мінеральних солей (Ca, Mg, S, Cl, Fe, Mn, Cu тощо). Але воду з водогону бажано очищувати у домашніх умовах із застосовуванням побутових фільтрів, тому що, при кип’ятінні води в осад випадає не вся кількість надлишкових домішок.
Також має значення температура води:


склянка холодної води, випитої натщесерце, посилює скорочення кишечника, що допомагає долати звичні запори;
дуже холодне пиття після рясної жирної їжі викликає тривале перебування її у шлунку;
тепла або гаряча рідка їжа швидше залишає шлунок;
лікарі-дієтологи рекомендують пити зранку теплу воду, так як вона допомагає «пробудити» шлунок; небажаним є і харчування всухом’ятку.
Таким чином, харчування є одним з найважливіших умов підтримки та збереження життя, заповнюючи потребу організму в пластичних та енергетичних матеріалах, інформації, забезпечуючи нормальну та безперебійну роботу усіх органів та систем організму. Необхідним є і врахування того факту, що надмірне вживання поживних речовин як і їх нестача можуть нанести здоров’я людини шкоду. Тому для кожної людини характер харчування повинен відповідати її індивідуальним особливостям та враховувати специфіку життєдіяльності.
Література.
1. Дієтичне харчування / Черевко О.І. та співавт. — Х.: Світ книг, 2016. — 360 с.
2. Вісловух А. Безпека харчування як основа безпечної життєдіяльності людини: Навчальний посібник. — К.: Вид-во Ліра-К, 2018. — 252 с.
3. Малах, О. Н. Валеология : курс лекций / О. Н. Малах, А. Н. Дударев. — Витебск : ВГУ имени П. М. Машерова, 2020. — 119, [1] с. Режим доступа: https:// www.researchgate.net/publication
4. Лекції з валеології — Режим доступа: http://medbib.in.ua/valeologiya.html
5. Біологічна хімія: Підручник.– Київ-Тернопіль: Укрмедкнига, 2000. –508 с. - Режим доступа: https://repository.tdmu.edu.ua/bitstream/handle/1/8584/ bio_chem.pdf?sequence=1&isAllowed=y
Вода
Журнал «Сучасна фармація» • modern-pharmacy.com.ua • 2023 / лютий • Натур modern • Думка фахівця 83
ÑÓ×ÀÑͲ ÐÅÀ˲¯
ÏÀÐÀËÅËÜÍÎÃΠѲÒÓ

У сучасній класифікації лудоманія внесена в розділ
«Розлади звичок і потягів (F63)» — Патологічний
потяг до азартних ігор (F 63.0). Вперше за всі роки гемблінг визнано справжньою хворобою.
Ігровий розлад, згідно з критеріями Міжнародної
класифікації хвороб 11-го перегляду (МКХ-11),
— це ігрова поведінка, яка характеризується
порушенням контролю над гральним процесом, наданням пріоритету геймінгу над іншою
діяльністю настільки, що бажання грати переважує
всі інші інтереси, порушуючи повсякденний спосіб життя, попри навіть негативні наслідки від такого функціонування.


Цей факт є важливим і показовим, тому що з кожним роком збільшується число людей, які не можуть вирватися з полону віртуальної реальності, кращої, яскравішої і більш простої, ніж справжнє життя.
Результати епідеміологічних досліджень свідчать, що від 0,5 до 1,5 % населення економічно розвинених краї н, особливо там, де гральний бізнес уже легалізований, страждають на патологічний гемблінг і близь-
ко 60 % громадян таких краї н хоча б раз на рік проводять час за азартною грою.
Як правило, більш тяжкий перебіг захворювання характерний саме для жіночої статі — вони втричі
швидше залучаються до небезпечного захоплення та
важче піддаються психотерапії. Залежність від азартних ігор серед підлітків і молодих людей зустрічається
в 2–4 рази частіше, ніж серед дорослих. Частота проблемного та патологічного гемблінгу в цих вікових групах становить від 2,8 до 8,1 %, причому співвідношення хлопців до дівчат становить 5,7:0,6 %. Важливою особливістю є те, що початок гемблінгу в ранньому віці часто супроводжується іншими психічними розладами — зловживанням алкоголем/наркотиками, а також депресією.

В Украї ні дослідження поширеності патологічного гемблінгу засвідчили, що серед населення 4,6 % мають вказану патологію, 13,0 % — входять до групи ризику і 24,2 % — мають досвід азартної гри.
НА ЗАМІТКУ!!!
У МКХ-11 ігровій залежності присвоєно класифікатор захворювання 6С51, онлайновій ігровій залежності — 6С51.0, офлайновій — 6С51.1 та невизначеної етіології — 6С51Т.
На думку деяких учених, ризик стати ігроманом жодним чином не залежить від здоров’я, соціальних параметрів, умов виховання, а швидше від характеру і темпераменту, причому останні два, як вважають, є інваріантом, зумовленим май же винятково спадковістю.
Підвищений ризик розвитку патологічної схильності до азартних ігор спостерігається у тих, хто:
має проблеми з алкоголем чи наркотиками;

має порушення поведінки;
перебуває під психологічним тиском з боку батьків
має батьків/родичів/друзів із проблемним гемблінгом.
84 Журнал «Сучасна фармація» • modern-pharmacy.com.ua • 2023 / лютий • Натур modern • Цікаво
Åâîëþö³ÿ àçàðòíèõ ³ãîð



Азартні ігри відомі людству протягом більше десятків тисяч років: вперше вони згадуються сорок тисяч років тому. Єгипетські гробниці
(3500 років до н.е.) зберегли зображення людини, яка грає у кості. У стародавньому Тибеті ігорні діаграми були накреслені на дахах храмів. У греків
є міф про Зевса та Афродіту, які підкидають кості для визначення долі героя, а «Іліада» Гомера описує олімпійських богів, що грають у лотерею, щоб визначити переможця бою.


Попередники ігорних будинків («casіno» у перекладі з італійського «будиночок») з’явилися у Римській імперії. Днем народження казино історики називають 557 рік до нашої ери, коли римський цар Тарквіній Люцій Пріск спорудив на честь бога хоронителя врожаю Конса так званий Великий Цирк — давньоримський центр індустрії розваг.
Безневинні «хрестики-нулики», винайдені в Західній Європі приблизно в XІ столітті, споконвічно вважалися азартною грою.
Психологічні чинники, що сприяють гемблінгу:
занижена самооцінка;
схильність до ризику;
періодичні депресія та азартність;
низька конформність та самодисципліна;
конфлікти з батьками;
низька шкільна успішність;
постійна проблемна поведінка.
Якщо зазначені ознаки мають виражений характер, то розлад може чинити суттєвий негативний вплив на особисте, сімейне і соціальне життя людини, ї ї навчальну або професійну діяльність, а також інші важливі сфери ї ї існування. Так, ігрова залежність може спостерігатися як безперервна нав’язлива поведінка або мати епізодичний характер із постійним поверненням до гральної діяльності. Для встановлення достовірного діагнозу зазвичай потрібно, щоб пацієнт виявляв аномальну поведінку останні 12 місяців. Іншими словами, якщо гей мер «пішов у зав’язку» і протягом року не повертався до комп’ютерних ігор, то можна вважати, що це є прикладом успішної реабілітації, хоча ризик повернення до «старої» звички залишається.
Стадії ігрової залежності:
1) нульова — формування ігрової залежності (стадія «соціального гравця» — перехід від захопленості до звичайної пристрасті, азарту, потім до фанатизму, одержимості, а зрештою, до ігроманії);
2) перша — ілюзорне сприйняття гри і себе в ній (гра на виграш, у мотивації домінування викривленого, хибного сприй мання дійсності гравцем);

3) друга — гра заради самої гри (безілюзорне розуміння грального процесу на тлі перекрученого ставлення до себе, власних можливостей; мета гри — сам ї ї процес);
4) третя — деградація та повне спустошення особистості (розпад родини, втрата друзів, позбавлення роботи, житла, зубожіння, набуття стану безхатька, заручника гри, додатка до грального автомата).
Клінічна картина патологічного гемблінгу обумовлюється синдромом психофізичної залежності, ознаки якої багато в чому відповідають складовим так званого великого наркоманічного синдрому, описаного для хвороб хімічної залежності. Нерідко афективні розлади передують початку патологічних форм гемблінгу та можуть відігравати причинну роль, штовхаючи гравців на пошук саме у грі полегшення від подавленого настрою.
Розлад проявляється як: ослаблений контроль над гральним процесом (його початок, частота, інтенсивність, тривалість, припинення);
збільшений пріоритет ігор порівняно з іншими життєвими інтересами і повсякденною діяльністю; продовження або ескалація ігрової активності, незважаючи на виникнення негативних наслідків.
Патологічна схильність до азартних ігор починається, як правило, вже з одного яскравого епізоду гри і несподіваного виграшу.
ЦЕ
Журнал «Сучасна фармація» • modern-pharmacy.com.ua • 2023 / лютий • Натур modern • Цікаво 85
ЦІКАВО!!!
Зокрема, першій стадії (виграш)
притаманні такі ознаки, як:
випадкова гра;
виграш із можливістю контролю ігрового процесу;





почастішання випадків гри;
збільшення розміру ставок;
фантазії про гру;
безпричинний оптимізм.
Для другої стадії (програш)
характерні:
гра на самоті;
роздуми винятково лише про гру;
затягнення епізодів програшів;
нездатність контролювати ігровий процес;
брехня
власної проблеми;
та приховування
зниження рівня турботи про сім’ю;
зменшення робочого часу на користь гри;
відмова платити борги, що супроводжується зміною особистісного реагування — дратівливість, втомлюваність, похмурість, нетовариські стосунки. При цьому вибудовується складна емоцій на атмосфера, накопичуються великі борги, створені як законним, так і незаконним чином, кредити, позики грошей. Відчай душні спроби при-
Іноді факт викупу не повертає гравця до реальності, а навпаки, знову укріплює його в думці, що він невразливий і в разі виграшу вдача знову йому допоможе виграти велику суму. Все це зумовлює підвищення інтенсивності залучення до гри, подальше відчуження від родини та друзів, вироблення нових стратегій брехні, накопичення незаконних позичок і фальшивих чеків, породження відчаю і жалю, появу тривоги, панічних атак і нових раціоналізацій щодо потреби у збільшенні ставок.
Зрештою, фінал цієї стадії аналогічний до тієї, що і у хворих на алкогольну залежність. Він називається «падінням на дно» — гравець досягає останнього, обмеженого оберту спіралі, якою він просувався весь цей час. А відсутність гри схожа для нього за відчуттям із браком алкоголю для людини, яка страждає від алкогольної залежності.
Клініко-психопатологічні періоди ігрового циклу:
дистрес, що настає відразу за грою;
пинити грати залишаються малоуспішними.
Третя стадія (розчарування і відчай) поєднує:
втрату професійної та особистої репутації;
значне збільшення часу, проведеного за грою;
підвищення розміру гральних ставок;
наростаюче віддалення від родини і друзів. Постійні докори сумління, каяття, ненависть до інших, паніка, безнадія, проблеми із законом тягнуть за собою суїцидальні думки і спроби. Можливо зловживання алкоголем.
помірковано виражений тривожно-депресивний розлад;
субдепресивний розлад із перевагою астенії або апатіі;
тривожний і дисфоричний розлад у комбінації із субдепресією;
звужена свідомость (транс гри), що передує безпосередньо нервовому зриву.
Виділяють дві основні форми патологічного потягу до азартних ігор:
1) гравці «дії» (перший тип);

2) гравці, «які уникають реальності» (другий тип).
Представникам першої клінічної форми властиві такі риси: відносно високий інтелект і соціальний стан; нарцисизм як серйозна особистісна дисфункція; прагнення домінувати, ризикувати або маніпулювати іншими людьми.
Гравці другого типу стають патологічними учасниками грального процесу, уникаючи проблем, невдач, хворобливих втрат чи програшів у реальному житті. Через це ї х називають гравцями, «що тікають від реальності». Здебільшого цей тип виявляють саме в жінок. Вони грають, бажаючи у такий спосіб забути невдачі в особистому житті або болісні розтавання. Граючи, такі люди не почувають ні емоційного, ні фізичного болю. Деякі автори цей стан розглядають як наближений до гіпнотичного.
86 Журнал «Сучасна фармація» • modern-pharmacy.com.ua • 2023 / лютий • Натур modern • Цікаво
В американській класифікації психічних розладів DSM-IV діагноз патологічного гемблінгу встановлюється
за наявності таких п’яти або більше пунктів із розділу А та відповідності розділу Б.
РОЗДІЛ А:
захоплений гемблінгом постійно повертається
думками до минулого досвіду гри, навмисно відмовляється від гри або, навпаки, смакує і готується до реалізації чергової можливості пограти, або обмірковує спосіб отримати кошти для цього; він продовжує гру навіть тоді, коли ставки надмірно підвищуються, досягаючи при цьому бажаної гостроти відчуттів;
здійснює кількаразові, але безуспішні спроби контролювати свою жагу до гемблінгу, грати менше або зовсім припинити цю діяльність;
виявляє занепокоєння і дратівливість у разі спроби
грати менше або зовсім відмовитися від гемблінгу;
грає, щоб віддалитися від свої х проблем або зняти


дисфорію (наприклад, почуття безпорадності, провини, тривогу, депресію);
повертається до гри наступного дня після програ-
шу, щоб відігратися (думки про програш не дають спокою);

бреше сім’ї, лікарю та іншим зацікавленим особам, щоб приховати ступінь свого залучення до гемблінгу;
вчиняє кримінальні дії (підробку документів, шахрайство, крадіжку, привласнення чужого майна) для отримання коштів для гри;
ставить під загрозу та навіть готовий повністю розірвати заради гри стосунки з близькими людьми, кинути роботу або навчання, відмовитися від перспективи кар’єрного росту;
у разі відсутності грошей через гру перекладає вирішення проблем на інших людей.
РОЗДІЛ Б:

гральна поведінка не пов’язана з маніакальним епізодом.
Áîæåâ³ëüí³ ôàêòè ç ³ñòî𳿠àçàðòíèõ ³ãîð


1. ПАРОПЛАВ АЗАРТУ
Доволі довго азартні ігри були під забороною для жителів штату Каліфорнія, але, як не дивно, перше «плавуче казино» в історії з’явилося саме тут. Щоб обійти закони, місцевий підприємець і член злочинного угруповання Ентоні Корнер скористався юридичною перевагою міжнародних вод і почав проводити азартні ігри на борту корабля в декількох кілометрах від узбережжя Санта-Моніки. Це захищало Корнера як від проблем з урядом, так і від проблем з італійською мафією, яка контролювала всі гральні заклади на суші. У кінці 1930-х у Ентоні Корнера було два корабля, які могли прийняти на борт по 2000–3000 гравців кожен.
Там були ресторани, оркестр і навіть озброєна охорона. Тільки у 1948-му президент Гаррі Трумен наклав заборону на такий вид бізнесу, а сам Корнер помер при загадкових обставинах після гри в казино в 1955-му.
2. ЛУДОМАНІЯ ГЕНРІХА VIII

Багато відомих людей люблять азартні
ігри і не завжди пам’ятають про принципи відповідального гемблінгу. Серед них Майкл Джордан, Памела Андерсон, Бен Аффлек, Уейн Руні, Чарлі Шин та інші. Але одним з найбільш відомих лудоманів в історії був англійський король Генріх VIII Тюдор. За легендою, цей король програв величезну кількість грошей і коштовностей. Серед них — дзвони Каплиці Ісуса Собору Святого Павла в Лондоні.
Гру в кістки королю запропонував його придворний. Ставка останнього становила всього 100 фунтів, але в разі його перемоги Генріх VIII мав віддати наказ зруйнувати ці дзвони. Придворного пізніше повісили за звинуваченням у державній зраді.
3. ЛОТЕРЕЯ ДЛЯ БІДНИХ

Як і інші види азартних ігор, лотерея була під державною забороною у США до 1964 року. Але сьогодні в штатах існують кілька видів національних лотерей, в яких беруть участь десятки мільйонів користувачів.
Згідно з результатами недавнього дослідження, американські сім’ї, які заробляють на рік менше $13 тис., витрачають на лотерейні квитки в середньому до 10 % свого доходу. Вчені пов’язують це з тим, що люди з більш низькими доходами частіше думають про великий виграш і беруть участь в лотереях.
Журнал «Сучасна фармація» • modern-pharmacy.com.ua • 2023 / лютий • Натур modern • Цікаво 87
ЦЕ ЦІКАВО!!!
4. ПРОКЛЯТІ КАЗИНО
Ймовірно, забобонні гравці чули про казино Foxwoods Resort і Mohegan Sun в Коннектикуті, — ці заклади прославилися найбільшою кількістю смертей своїх користувачів. Все почалося в травні 1993го, коли 38-річний Роберт Том помер від серцевого




нападу після виграшу $4000. Після цього в казино померли ще 150 людей: причиною смерті більшості з них також став серцевий напад, а інші загинули від передозування наркотиків або суїциду.


Сьогодні ігроманія є нагальною соціальною проблемою. Адже формуючись, як правило, у соціально-активному віці, лудоманія призводить не лише до соціальної дезадаптації, а і до формування психічного розладу, що завдає шкоди соматичному здоров’ю. Особливо актуальною наразі є проблема швидкого формування адиктивної поведінки у підлітковому віці, що пов’язано із психічною та соціальною незрілістю молодого організму, який менше захищений від впливу негативних зовнішніх і внутрішніх стресових чинників. За відсутності відповідних втручань проблема
азартних ігор продовжуватиме негативно впливати як
на особу, так і на ї ї родину, що не може не позначитись
на суспільстві загалом.
Тому за сприяння Міністерства охорони здоров’я в Україні 3 лютого стартувало перше масштабне дослідження залежності від азартних ігор (лудоманії).
Суспільне дослідження здійснюється командою експертів, соціологів та науковців громадської спілки «Центр відповідальної гри» (RGC) та Інституту психіатрії, судово-психіатричної експертизи та моніторингу наркотиків МОЗ України.
На основі вивчення ігрової поведінки осіб, які грають в азартні ігри, команда науковців, лікарів, психологів, юристів та соціологів встановить критерії патологічної та проблемної ігрової поведінки й сформує «портрет» позитивного та проблемного гравця. Це допоможе своєчасно виявляти ознаки ризикової ігрової поведінки та попереджати ігрову залежність. Також
результатом такої роботи стануть рекомендації для професійної медичної спільноти із застосування протоколів лікування ігрової залежності.
Завданням дослідження є:
вивчити ігрову поведінку осіб, які беруть участь в азартних іграх в Інтернеті, казино, залах гральних автоматів, та встановити критерій патологічної та проблемної ігрової поведінки;
розробити інструментарій самовиявлення проблемної/патологічної ігрової поведінки у гравця; на основі критеріїв проблемної/патологічної ігрової поведінки розробити алгоритм дій гравцям та рекомендації самодопомоги щодо попередження ризику виникнення залежності від азартних ігор; розробити рекомендації для організаторів грального бізнесу щодо виявлення гравця з проблемною/ патологічною ігровою поведінкою та алгоритм дій для надання людині допомоги;
сформувати рекомендації для держави щодо поліпшення доступності медичної та соціальної допомоги для гравців з проблемною/патологічною ігровою поведінкою (залежністю від азартних ігор);
надати рекомендації по впровадженню протоколів лікування осіб із залежністю від азартних ігор. Сфера покриття дослідження охопить всю територію України (крім тимчасово окупованих територій).
Використані джерела:
1. Аймедов К. В. Ігроманія — паралельний світ. Монографія. К.: НДІ соціальної і судової психіатрії та наркології МОЗ України. LAT & K, 2012. 244 с.
2. Ігроманія: сучасні реалії та шляхи подолання [Текст]: науково-популярний посібник / І. Я. Пінчук, С. І. Табачніков, О. О. Древіцька, К. В. Ай медов, О. С. Осуховська, А. Г. Шевцов, О. В. Колодєжний [та ін.]; за ред. д.мед.н., старшого наукового співробітника І. Я. Пінчук та д.мед.н., проф. С. І. Табачнікова. К.: ТОВ «Медичний журнал «Ней роньюс», 2018. 60 с.
3. https://moz.gov.ua
В
УКРАЇНІ СТАРТУЄ ДОСЛІДЖЕННЯ З ІГРОВОЇ ЗАЛЕЖНОСТІ
88 Журнал «Сучасна фармація» • modern-pharmacy.com.ua • 2023 / лютий • Натур modern • Цікаво
переможців професійного конкурсу
на знання важливих аспектів використання
нестероїдного протизапального лікарського засобу ЦЕЛЕБРЕКС®
Краснікова Ольга, м. Дніпро, аптека «Рецептіка», фармацевт
Кривонос Ірина, м. Житомир, аптека «Аптекар», фармацевт

Воробей Катерина, м. Кропивницький Кіровоградська обл., Аптека «Бам», фармацевт

Кінаш Наталія, м. Івано-Франківськ, Аптека «Біла ромашка», фармацевт
Вітушинська Оксана, м. Чернівці, Аптека «Комплекс», заступник завідувача аптеки





УПЕВНЕНІ, ЩО НОВІ ЗНАННЯ СТАНУТЬ В НАГОДІ ДЛЯ ФАРМАЦЕВТИЧНОЇ ОПІКИ ВІДВІДУВАЧІВ АПТЕК
ЗРУЧНА ДОЗ-КАРТА ЦЕЛЕБРЕКСУ® ПРИ РІЗНИХ НОЗОЛОГІЯХ

viartisconnect.com.ua платформа, спеціально розроблена для практикуючих лікарів і фармацевтів. Отримайте зручний доступ до актуальних даних та корисних ресурсів, що допоможуть в роботі з пацієнтами і відвідувачами аптек



ЩИРО ВІТАЄМО